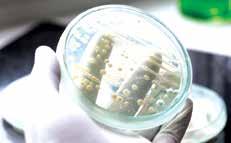

Last week, one of our readers wrote in about how we, as a community, should keep our Pesach cleaning schedules and “accomplishments” to ourselves. She noted how the boasting of what’s being done in our homes can only lead to stress and anxiety from those who are listening.
As I thought about what she wrote, I realized that, as with so many things in life, we are all built differently. We all work at different paces; we all have our own priorities. What works for one person may not necessarily work for another. And so, when preparing for Pesach, each person has to decide what works for them and then move forward toward that goal. We need to ignore what others are doing. We need to disregard the outside pressures. We need to focus only on our own goalposts and targets.
This week, while speaking with someone, she mentioned that she was going out of town for a few days and wouldn’t be back until after Rosh Chodesh Nissan. “Yes, I know, it’s almost Pesach,” she said. “But that’s how I live my life. We won’t be eating chometz on Pesach and we’ll have a beautiful yom tov, but I don’t stress these things.”
I loved her attitude. It was so fresh and different than what you hear from so many others.
But I also know that this perspective doesn’t work for everyone. In fact, I am close with her sister. And I know that her sister needs to have her schedule planned out and works out a sys-
tem to make sure that she is all clean and ready to “turn over” at least a week before the yom tov. What works for one doesn’t always work for the other.
It’s not just with Pesach preparation where we differ. We all possess different characteristics and traits to help us navigate our path through life. For some people, having a plan and checking things off their lists earlier than later makes them feel more in control and more centered. For others, tackling their tasks under pressure helps to galvanize them to complete them more quickly.
Do you shop for Shabbos on Wednesday and start cooking on Thursday, or is Friday your day to get everything done? Are your kids all packed for camp before school even ends, or are you stuffing their toiletries into their knapsacks as they head onto the buses? Do you send in your financial info to your accountant a few months before the tax deadline, or do you consistently have it filed on April 15?

As with all things in life, each person has their unique traits that they bring to every situation. Why should preparing for yom tov be any different?
So, yes, I agree with Talia W.: “Everyone will get to the Seder at the same time and at their own pace.”
Wishing you a wonderful week, Shoshana
Yitzy Halpern,
PUBLISHER
publisher@fivetownsjewishhome.com
Yosef Feinerman, MANAGING EDITOR ads@fivetownsjewishhome.com
Shoshana Soroka, EDITOR editor@fivetownsjewishhome.com
Nate Davis
Editorial Assistant
Nechama Wein
Copy Editor
Rachel Bergida
Shana Brecher
Lani White
Design & Production
Gabe Solomon
Distribution & Logistics
P.O. BOX 266
Lawrence, NY 11559
Phone | 516-734-0858
Fax | 516-734-0857
Classified Deadline: Monday 5:00PM classifieds@fivetownsjewishhome.com
text 443-929-4003
PAYMENT VIA CREDIT CARD MUST BE SUBMITTED ALONG WITH CLASSIFIED ADS
The Jewish Home is an independent weekly magazine. Opinions expressed by writers are not necessarily the opinions of the publisher or editor. The Jewish Home is not responsible for typographical errors, or for the kashrus of any product or business advertised within. The Jewish Home contains words of Torah. Please treat accordingly.
Friday, March 24 Parshas Vayikra
Candle Lighting: 6:53 pm
Shabbos Ends: 7:53 pm
Rabbeinu Tam: 8:25 pm

Dear Editor,
This past week’s paper you did a poll on Fruity/Cocoa Pebbles, and a lot of people including myself think either you guys made it up or the people who voted are deranged. So, we are looking for answers. You think you can show me the poll results? No way people be voting Cocoa over Fruity. Absolutely blasphemous.
A Fruity FanDear Editor,
The Gemara (Kiddushin 81a) records a remarkable incident. Rabbi Akiva, the greatest Tannaitic sage, taunts the yetzer hara, whereby the yetzer hara then appears to him as a woman at the top of a tree. Rabbi Akiva begins to climb the tree but is ultimately saved when the Heavens intercede for him. How can such a fall be understood?
The guf is all pleasure seeking and retains enormous power over the soul, yet it must understand the necessity to dance with the everlasting neshama. The more the guf follows the neshama to serve G-d, the more light of the Divine enters the body. Whereas if the body, which is a desire-seeking machine, gives into the physical, G-d’ light is shunned from entering the body. A thriving guf-neshama relationship has great ramifications when the soul will unite with the body in techiyat hametim. Since G-d wanted a physical body and spiritual soul to work in tandem, both are recognized for following in His ways.
Once you take on the bold step to admit your mistakes in the physical realm and address them, you are treated with mercy, as it says, “He who conceals his transgressions will not prosper, but he who confesses and forsakes them will find


Dear Editor,
Thank you for a wonderful publication. As a nurse practitioner who recently opened up my own practice that specializes in integrative medicine, I’ve been really enjoying Aliza Beer’s articles on health.
I wanted to weigh in on this week’s article, “Nutrition and Bariatric Surgery,” I worked for a local hematology-oncology practice for over a decade, and we’ve seen dozens of patients over the years who have become completely vitamin and mineral depleted 15-plus years post-bariatric surgery. (In many cases, it can take that long for the body to become completely deficient.) The surgeons fail to explain to the patients that they will lose a significant ability to absorb nutrients from food, specifically fat-soluble vitamins. The problem with taking oral vitamins is that these patients can’t even absorb the oral vitamins properly, so they still become deficient years later.
I agree with Aliza that chewable and/ or liquid vitamins are far superior than capsules because some of the vitamins get absorbed sublingually.
For any patients who are reading this who are suffering from brain fog, memory issues, low energy, foul smelling stools, and/or foul body odor, you may be suffering from ill effects of years of not absorbing vitamins and micronutrients. I’ve given patients intravenous and injectable vitamins and minerals and have gotten them into a much better state of health, eliminating debilitating side effects from bariatric surgery.
Yocheved Brazil NP-C
Continued on page 12



When your talented writer Pinchos Friedlander called to interview me for a story in your popular publication, I assumed it would be a short puff piece which would be used as filler material after the classifieds!
You can imagine my utter shock when I saw your beautiful cover layout followed by a fabulous three page spread complete with pictures and logos!

My phone didn’t stop ringing with calls from across the city. Your newspaper must have tremendous distribution because I was getting texts from Florida, Israel, and even Monsey!
Pinchos wrote a thorough, entertaining, and informative piece that accurately captured and interpreted my comments to his probing and well-informed questions. It was a real pleasure working with him!
Thank you for your interest, time, and professional graphics. Your newspaper is truly a world class publication! Sincerely,
Country Yossi ToivDear Editor,
Sadly, by the time anyone reads this, the election will be over but forgive me, Michael Hatten’s entire platform was disingenuous at best. If he were remotely serious about trying to change things, he would have run with another person to at least even the chances of doing a fraction of what he was promising. He did not. There are 4 Trustees in Cedarhurst and only 2 are up for re-election. He is offering one vote against 3 other trustees, not including the Mayor. In case he missed it, the Pearsall Project has already been approved (unanimously) and there is very little, if anything, Mr. Hatten can do at this point.
For clarity, let me try to explain this project for those who don’t actually understand it as it was explained to me by the Mayor. A consortium bought a large tract of land on Pearsall. It was already zoned for commercial use. The consortium submitted plans to put up a 5-story office building with 475 parking spaces. Please keep in mind that it did not need permission to do this. The land was already zoned for it. If the Village wanted to fight the building, they could, but they would most likely lose since the area was already zoned (for many years) for what the consortium wanted to do.
Instead, the Mayor and Trustees went to the consortium and requested an alternative, which would require the zoning to be changed. Would it consider building a 3-story high-end residential building (a Cedarhurst version of The Regency, if you will)? Not only did the consortium agree,
it offered to build a park, shul, mikveh on the premises, and 317 parking spaces (far more than are actually needed) under the building to ensure there will be no extra burden on parking for the Village.
These apartments will start in the very high 6 figures and go up from there. More residential housing equals a higher tax base and the potential of more FUNDED projects to better our community.
I know many of us would like to think our politicians are all powerful, but in many cases like this, they are not. This project is by no means comparable in size or scope to the debacle of the Woodmere Club. Kudos to the Mayor and Trustees for thinking outside the box to create an alternative plan that will enhance our community.
A Concerned Cedarhurst Resident Dear Editor,
Are reparations coming to New York?
Only in the land of Oz known as California would you learn about the San Francisco’s Board of Supervisors African American Reparations Advisory Committee. Who cares about inflation, crime, homelessness, excessive drug use and decline in the quality of life? While slavery ended in America in 1865, it never existed in California. Nevertheless, elected officials are giving serious consideration to give every African American resident $5 million, along with waiving any personal debt or delinquent taxes. There’s even more goodies. A guaranteed annual income of $997,000 for 250 years. A home for only $1 for each family. No wonder so many people are leaving town before it is too late.
Coming soon may be New York’s version of this insanity. Brooklyn State Senator Jabari Brisport is also interested in the Empire State becoming involved in reversing the damage of slavery by compensation. As a member of the African American, Puerto Rican, Hispanic and Asian Legislative Caucus, he sponsored a bill that would form a reparations commission to study the harm slavery perpetrated on our state. It would also look at various options for restitution to African American New Yorkers. His bill would require a reparations commission one year to research the effects including outreach to impacted neighborhoods. The commission would share their findings with the Legislature.
Will State Senate Majority Leader Andrea Steward Cousins and State Assembly Speaker Carl Heastie oppose this insanity? Will Governor Kathy Hochul veto the bill if it passes both houses? Let’s hope sanity will prevail.
Sincerely,
Larry Penner
children’s care homes.”
“My office alleges that these acts, amongst others, demonstrate an intention to permanently remove these children from their own country,” Khan said. “We must ensure that those responsible for alleged crimes are held accountable and that children are returned to their families and communities … We cannot allow children to be treated as if they are the spoils of war.”
“There are reasonable grounds to believe that Mr. Putin bears individual criminal responsibility for the aforementioned crimes,” the ICC judges’ statement said, adding that he both committed the acts directly and failed to stop others from doing so.

On Friday, the International Criminal Court (ICC) in The Hague issued an arrest warrant for Russian President Vladimir Putin for overseeing the abduction of Ukrainian children.
In granting the request for warrants by the ICC prosecutor, a panel of judges agreed that there were “reasonable grounds” to believe Putin and his children’s rights commissioner, Maria Alekseyevna Lvova-Belova, bore responsibility for the “unlawful deportation” of Ukrainian children.
These are the first warrants to be issued by the ICC for crimes committed in the Ukraine war. It is also one of the rare occasions when the court has issued a warrant for a sitting head of state, putting Putin in the company of the Libyan leader Muammar Gaddafi and the Sudanese president Omar al-Bashir.
Still, Putin is likely to evade justice in the near future: Russia does not recognize the court’s jurisdiction, and insisted on Friday it was not affected by the warrants. Despite the bluster, the Russian leader will face limits on his freedom of travel to the ICC’s 123 member states, further deepening his isolation.
In deciding to issue the warrants, the ICC pre-trial chamber of judges considered keeping the warrants secret but decided that making them public could “contribute to the prevention of the further commission of crimes.”
Last month, the Yale Humanitarian Research Lab published a report alleging that at least 6,000 children from Ukraine had been sent to Russian “re-education” camps in the past year. In a statement on Friday, the ICC prosecutor, Karim Khan, said, “Incidents identified by my office include the deportation of at least hundreds of children taken from orphanages and
In response, the Kremlin’s foreign ministry spokeswoman, Maria Zakharova, said, “The decisions of the International Criminal Court have no meaning for our country, including from a legal point of view. Russia is not a party to the Rome statute of the International Criminal Court and bears no obligations under it.”
Ukrainian President Volodymyr Zelensky has estimated the number of deported children at more than 16,000 and said the warrants represented “an historic decision which will lead to historic accountability.
“It would have been impossible to enact such a criminal operation without the say-so of the man at the helm of the terrorist state,” Zelensky asserted.
Russia has not been quiet about relocating these children. On February 16, Lvova-Belova appeared on television telling Putin about the program and thanking him for being able to “adopt” a 15-yearold boy from Mariupol, the south-eastern Ukrainian city that was devastated and occupied by Russian forces.
“Thanks to you, now I know what it’s like to be a mom of a Donbas child,” she told Putin.



trickle-down tax cuts to Boris Johnson’s revamped royal yacht. But one of Sunak’s most symbolic changes since taking over as prime minister five months ago has received less attention: retiring the slogan “Global Britain.”
No longer does the phrase, a swashbuckling relic of Britain’s debate over its post-Brexit role, feature in speeches by Cabinet ministers or in the government’s updated military and foreign policy blueprint released last Monday.
In its place, Sunak has hashed out workmanlike deals on trade and immigration with Britain’s nearest neighbors — France and the rest of the European Union. In the process, analysts and diplomats said, he has begun, for the first time since Britain’s departure from the European Union, to chart a realistic role on the global stage.
Global Britain, as promoted by Johnson, was meant to evoke a Britain, unshackled from Brussels, that could be
agile and opportunistic, a lightly regulated, free-trading powerhouse. In practice, it came to symbolize a country with farfetched ambitions and, under Johnson, a habit of squabbling with its neighbors.

Sunak has changed all of that, with a pragmatic approach that, to some extent, reflects his button-down, technocratic style. (In domestic policy, he has also shunned the ideological experimentation of Truss and the bombastic politics of Johnson in favor of a more methodical
approach to Britain’s deep-rooted economic problems.)
But a leader’s style matters, and on the world stage, Sunak’s no-bombast approach is paying eye-catching dividends.
In the past few weeks, he has struck a deal with Brussels on trade in Northern Ireland, eased years of Brexit-related tensions with France, inaugurated the next phase of a submarine alliance with Australia and the United States, and announced 11 billion pounds (about $13.3 billion) in increased military spending over the next five years, cementing Britain’s role as a leading supplier of weapons to Ukraine.
“It’s too early to say whether Sunak has found a role for post-Brexit Britain,” said Peter Westmacott, who served as Britain’s ambassador to France and to the United States. “But he has banished the much-ridiculed ‘Global Britain’ Johnsonian slogan, preferring to under-promise and over-deliver. He’s also moved fast to fix some of the obstacles to better relations with our partners.” (© The New York Times)
In an intense manhunt for a hardline Sikh preacher in India, authorities have arrested more than 100 of his supporters and shut down mobile internet in the state of Punjab.
Amritpal Singh, 30, rose to prominence in recent months demanding the creation of Khalistan, a separate Sikh homeland. He has wowed followers with his hardline interpretation of Sikhism at rallies in rural pockets of the western state of some 30 million people.

Last month, Singh and his supporters, armed with swords, knives, and guns, raided a police station after one of his aides was arrested for alleged assault and attempted kidnapping.
The brazen daytime raid on the outskirts of Amritsar – home to the holiest Sikh shrine, the Golden Temple – left several police injured and heaped pressure on authorities to act against Singh.
On Sunday, Punjab police began to

arrest those who were “attempting to disturb law and order in Punjab.” Singh’s uncle and driver were among those arrested, Indian media reports said on Monday.
According to police, the “manhunt” is ongoing, and the overall “situation is under control, citizens [are] requested to not believe in rumors.”
In connection to the unrest, India summoned the “senior-most UK diplomat in New Delhi” late on Sunday after some Singh supporters allegedly entered and vandalized the Indian High Commission in London.
The summon was “to convey strong protest at the actions taken by separatist and extremist elements” in London, India’s foreign ministry said in a statement.
New Delhi also sought “immediate steps to identify, arrest and prosecute” the suspects and demanded “an explanation for the complete absence of the British security that allowed these elements to enter” its official premises.
Punjab – with about 58 percent Sikhs and 39 percent Hindus – was rocked by a violent separatist movement for Khalistan in the 1980s and early ‘90s when thousands of people died.
India has often complained to respective governments over the activities of Sikh hardliners who, it says, have been
trying to revive the movement with a massive financial push.

ruins in Russia’s offensive.
Putin was flown into Mariupol by helicopter and toured districts around the city in a car, footage released by Russian authorities showed.
The Russian president is shown meeting seemingly surprised residents. Putin tells one man, “We need to start getting to know each other better.”
The Kremlin insisted the visit was “spontaneous.” It is not clear when it took place, although on Saturday Putin visited Crimea to mark the ninth anniversary of its annexation.
The visit is particularly provocative to Ukrainians as Mariupol was long a symbol of resistance and witnessed some of the most intense fighting since Russia launched its invasion.
making flights to all cities of Russia and abroad.”
The Kremlin added that Putin held a meeting at the command post of the special military operation – Russia’s description of its invasion – in Rostovon-Don.
An adviser to Ukrainian President Volodymyr Zelensky, Mykhailo Podolyak, slammed the “cynicism” and “lack of remorse” over Putin’s visit.
“The criminal always returns to the crime scene,” Podolyak said on Twitter.
Mariupol, a port city on the Sea of Azov, is located in Ukraine’s Donetsk Oblast and has been under direct Russian control since May 2022.
In an act of defiance, Russian President Vladimir Putin made a surprise visit to Russian-occupied Mariupol. This is his first visit to territory captured by his forces in the year-long conflict and came just days after the International Criminal Court issued an arrest warrant for the Russian leader.
Understandably, the visit prompted outrage from Ukraine – the defense ministry compared Putin to a “ thief” visiting “under the cover of night” –with the city having been reduced to

During the trip, the Kremlin said Putin also examined the coastline of Mariupol, visiting a yacht club and theater building.
Russian Deputy Prime Minister Marat Khusnullin, who accompanied him, spoke in detail to Putin about “ongoing construction and restoration work” in the city, including its airport.
In the video, Khusnullin tells Putin, “There is a plan to reconstruct it by the end of the third year. We plan for it to be a fully functional airport capable of
It was in Mariupol that Russian forces carried out some of their most infamous strikes, including an attack on a maternity hospital last March and the bombing of a theater in which hundreds of civilians had sought refuge. Mariupol became a symbol of Ukrainian resistance during weeks of relentless Russian attacks last year. Famously, even when most of the city had fallen, its defenders held out at the Azovstal steel plant for weeks before the stronghold finally fell.
Many of the 450,000 people who lived in the city before the war have fled.



he was in “great spirits.”

A U.S. official said Woodke, 62, was in Niamey and was being medically evaluated. Another senior administration official briefing reporters confirmed Woodke’s release and said the United States had not paid a ransom or made other concessions.

who stopped in Niger during a visit to Africa last week, had “confirmed” the release while there.
terest rates have undermined the value of some financial assets.
An American aid worker abducted by militants more than six years ago in West Africa has been freed, his wife and U.S. officials said on Monday, but the circumstances of his release were not immediately clear.
The aid worker, Jeffery Woodke, was kidnapped in Niger in October 2016 and then was believed to have been taken to neighboring Mali.
His wife, Els Woodke, of McKinleyville, California, said the U.S. government had notified her that her husband had been freed. She was told that he was in Niamey, the capital of Niger, and later spoke with him for an hour.
“He is safe,” she said in a phone interview. After she spoke with him, she said,
President Joe Biden thanked Niger and “dedicated public servants across the U.S. government” for securing Woodke’s release. “We remain committed to keep faith with Americans held hostage and wrongfully detained all around the world, and there is no higher priority for this administration than our work to bring them home,” Biden said in a statement.
A French security official confirmed that another hostage had also been released: Olivier Dubois, a French journalist who went missing in Mali in April 2021, and was later seen in a hostage video issued by an al-Qaeda affiliate there.
Woodke’s release ends an arduous ordeal in which U.S. officials believed at times that a dangerous military operation would have been required to free him. There is no indication that the United States mounted such a rescue or was involved in the release of the two men.
Efforts to release Woodke had been underway for a long time, the official said, and Secretary of State Antony Blinken,
The official said France — which is Niger’s former colonial ruler and maintains ties with its government — played an important role in securing Woodke’s release.
Dubois told reporters in Niger that “it’s huge for me to be here, to be free,” and thanked the governments of France and Niger. (© The New York Times)
“This acquisition is attractive for UBS shareholders but, let us be clear, as far as Credit Suisse is concerned, this is an emergency rescue,” UBS chairman Colm Kelleher told reporters.

“It is absolutely essential to the financial structure of Switzerland and … to global finance,” he told reporters.
The emergency takeover was agreed to after a days of frantic negotiations involving financial regulators in Switzerland, the United States and United Kingdom. UBS and Credit Suisse rank among the 30 most important banks in the global financial system, and together they have almost $1.7 trillion in assets.
U.S. authorities said they supported the action and worked closely with the Swiss central bank to assist the takeover.
Switzerland’s biggest bank, UBS, has agreed to buy its rival Credit Suisse in an emergency rescue deal aimed at stemming financial market panic unleashed by the failure of two American banks earlier this month.
“UBS today announced the takeover of Credit Suisse,” the Swiss National Bank said in a statement on Sunday. It said the rescue would “secure financial stability and protect the Swiss economy.”
UBS is paying 3 billion Swiss francs ($3.25 billion) for Credit Suisse, about 60% less than the bank was worth when markets closed on Friday. Credit Suisse shareholders will be largely wiped out, receiving the equivalent of just 0.76 Swiss francs in UBS shares for stock that was worth 1.86 Swiss francs on Friday. Owners of $17 billion worth of “additional tier one” bonds — a riskier class of bank debt — will lose everything, Swiss regulators said.
There is no need for the deal to be approved by shareholders since the Swiss government agreed to change the law to remove any uncertainty about the deal.
Credit Suisse had been losing the trust of investors and customers for years. In 2022, it recorded its worst loss since the global financial crisis. But confidence collapsed last week after it acknowledged “material weakness” in its bookkeeping and as the demise of U.S.-based Silicon Valley Bank and Signature Bank spread fear about weaker institutions at a time when soaring in -
Christine Lagarde, President of the European Central Bank, said the banking sector remains resilient but the ECB stands at the ready to help banks maintain enough cash on hand to fund their operations if the need arises.
The Bank of England said it welcomed the measures taken by the Swiss authorities “to support financial stability.”
Dating back to 1856, Credit Suisse has its roots in the Schweizerische Kreditanstalt (SKA), which was set up to finance the expansion of the railroad network and industrialization of Switzerland. In addition to being Switzerland’s second biggest bank, it looks after the wealth of many of the world’s richest people and offers global investment banking services. It had more than 50,000 employees at the end of 2022, 17,000 of those in Switzerland.
Want to be happy? Move to Finland, a country that has been ranked the world’s happiest for six years in a row.
The World Happiness Report is published by the UN Sustainable Development Solutions Network. It draws on data from people in more than 150


countries.
The report, which was released on Monday, identifies the happiest nations, those at the very bottom of the happiness scale, and everything in between, along with the factors that tend to lead to greater happiness.
Finland’s neighbors also did very well on the report, with Finland, Denmark, Iceland, Sweden, and Norway getting high marks in the categories of healthy life expectancy, GDP per capita, social support, low corruption, gen -
erosity in a community where people look after each other, and freedom to make key life decisions.

Israel moved up to No. 4 this year from its No. 9 ranking last year. The Netherlands (No. 5), Switzerland (No. 8), Luxembourg (No. 9) and New Zealand (No. 10) rounded out the top 10.
Australia (No. 12), Canada (No. 13), Ireland (No. 14), the United States (No. 15) and the United Kingdom (No. 19) all made it into the top 20. While the same countries tend to
appear in the top 20 year after year, there was a surprising entry this year: Lithuania.
The Baltic nation has been climbing steadily over the past six years from No. 52 in 2017 to No. 20 on the latest list. And the other Baltic countries, Estonia (No. 31) and Latvia (No. 41), have been climbing in the ranks, too.
France dropped out of the top 20 to No. 21 in this year’s report.
On the other side of the scale, Afghanistan came in last on the list at No. 137.
Lebanon nabbed the spot just above that. Average life evaluations in these countries are more than five points lower (on a scale from 0 to 10) than in the 10 happiest countries.
Russia and Ukraine, both countries suffering from war, were slotted into the 70 th and 92 nd spots, respectively.
The French National Assembly rejected a no-confidence motion against the government of President Emmanuel Macron on Monday, ensuring that a fiercely contested bill raising the retirement age to 64 from 62 becomes the law of the land.

The first of two motions received 278 votes, nine short of the 287 needed to pass. The close result reflected widespread anger at the pension overhaul, at Macron for his apparent aloofness, and at the way the measure was rammed through Parliament last week without a full vote on the bill itself. The Senate, France’s upper house of Parliament, passed the pension bill this month.
A second no-confidence motion, filed by the far-right National Rally, failed Monday, as well, with only 94 lawmakers voting in favor.
The change, which Macron has sought since the beginning of his first term in 2017, has provoked two months of demonstrations, intermittent strikes, and occasional violence. It has split France, with polls consistently showing twothirds of the population opposing the overhaul.
After the votes on Monday, there was no indication that the protests would abate or that the restive mood that brought about this crisis would fade anytime soon. A period of deep uncertainty lies before France, and it is unclear how Macron, who has remained largely silent, will be able to reassert his authority.
“Through strikes and demonstrations, we must force the withdrawal of the bill,” Jean-Luc Mélenchon, the far-left leader, said after the vote. After night fell, sporadic violent clashes erupted between crowds of protesters and the police in cit-

ies around the country, including Strasbourg, Rennes, and Lyon. In Paris, small groups of protesters played a game of cat and mouse with police, knocking over trash cans and setting fire to uncollected garbage. Riot police responded with tear gas, pepper spray, and batons.
Labor unions have called for a day of strikes and demonstrations on Thursday, and Marine Le Pen, the leader of the National Rally party, declared, “I believe it is difficult to govern in these circumstances.”
But for now, the center has held, and the fall of the government has been averted. (© The New York Times)

Whose side are you on? Japan and China made their allegiances clear this week when both nations visited countries involved in the Ukraine war.
Japan’s Prime Minister Fumio Kishida headed to Kyiv where he is promising unwavering support to Ukraine’s president, with talk of reconstruction and humanitarian aid.
China’s Xi Jinping, on the other hand, made his way to Moscow and has been described by Russia’s Vladimir Putin as a friend and a partner. China has insisted it is a neutral party in the conflict.
Kishida will also show his “absolute rejection of Russia’s one-sided change to the status quo by invasion and force,” the statement added.
Kishida was the only G7 leader not to have visited since Russia launched its invasion last year, and there had been calls for him to go before he presides over a G7 summit in Hiroshima in May.


On Tuesday, Xi said China would prioritize its ties with Russia and described the two countries as “great neighboring powers.”
It is rare for a Japanese leader to make an unannounced foreign trip. Kishida is the first to visit a country in conflict since World War II. The visit was kept a secret until just before his arrival early on Tuesday, with officials citing security concerns.
He will “show respect to the courage and patience of the Ukrainian people who are standing up to defend their homeland...and show solidarity and unwavering support” during his visit, the Japanese Foreign Ministry said.
He had already secured one strategic diplomatic coup by holding a summit with South Korea’s president last week in Tokyo – the first time that had happened in more than a decade. Normalizing ties with Seoul, sharing intelligence, and showing a united front against North Korea will all reassure Japan’s strategic ally, the United States.
Last month, China and Japan held security talks in Tokyo for the first time in four years. Beijing said it was troubled by Japan’s military build-up and Tokyo criticized China’s military ties to Russia and its suspected use of spy balloons.
These are the world’s second and third largest economies, and an open channel of communication is key despite their current tensions.
President Recep Tayyip Erdogan of Turkey gave the go-ahead on Friday for Finland’s application to join NATO, clearing a significant hurdle for the Nordic nation’s bid to join the alliance but leaving its neighbor, Sweden, on the sidelines for now.
“We decided to start the ratification process in our parliament for Finland’s membership,” Erdogan said at a news conference in the Turkish capital, Ankara, adding that he would like the vote to take place before elections in mid-May.
Erdogan spoke after concluding a meeting with Finnish President Sauli Niinisto. The leaders had telegraphed that the announcement was forthcoming, with Erdogan saying that Turkey would “keep


our promise.”
For Finland to join NATO after decades of military nonalignment would be a major shift in the balance of power in the region between the Western military alliance and Russia. It would also be a significant diplomatic and strategic defeat for Russian President Vladimir Putin, who made clear before invading Ukraine last year that his intention was to block NATO’s eastward expansion. But instead, his invasion convinced Finnish and Swedish leaders that there was no real security guarantee for them outside of the North Atlantic Treaty Organization.
Finland has a border of 830 miles with Russia, Europe’s longest, and a history of resisting Moscow’s hegemony. Favoring self-reliance, Finland did not shrink its military after the collapse of the Soviet Union, and it pulled along a more reluctant Sweden to apply to NATO together 10 months ago.
But Erdogan has blocked the Swedish application, claiming that the country has become a haven for Kurdish separatists and other dissidents he considers terrorists. So far, Stockholm’s efforts to placate him, including a new terrorism law, have failed.
Erdogan’s decision opens the way for Turkey’s parliament to ratify Finland’s membership in the alliance, which requires unanimous approval from the 30 nations in the bloc. Hungary is the only other country whose parliament has not ratified the bids by Finland or Sweden. Its leader, Prime Minister Viktor Orban, who has warm relations with Putin, has vacillated on when the Hungarian parliament will vote. But he always insists that Hungary has no objection to membership for either Nordic country. (© The New York Times)
It wasn’t a tunnel that was used to infiltrate Israel’s north last week. The Hezbollah terrorist who planted a bomb at Megiddo Junction crossed the Lebanon border fence using a ladder, defense sources said this week.

The suspected use of a ladder by the terrorist to climb over the border fence was permitted for publication on Tuesday, although the army is still not com-
The IDF has previously said the suspected terrorist crossed into Israel from Lebanon overnight between Saturday and Sunday of last week and planted the bomb, possibly on behalf of the Iranbacked terror group. It exploded on Monday, seriously wounding Shareef ad-Din, 21, from the Arab village of Salem.
Many details surrounding the blast were kept under wraps due to the ongoing investigation, which was spearheaded by the Shin Bet security agency.
The bomb itself was considered unusual according to the IDF and did not appear to be similar to explosive devices used by Palestinians in recent months. Ad-Din’s car, which was hit by the shrapnel, was around 100 feet away from the device.

After the attack at Megiddo Junction, the alleged terrorist hitched a ride to northern Israel. Several hours after the explosion, soldiers spotted a vehicle with the suspected terrorist near the northern Israeli town of Ya’ara, close to the border with Lebanon, the IDF said.
Officers of the elite police Yamam counterterrorism unit and Shin Bet officers opened fire at the suspect, killing him. The terrorist posed a “clear danger” to the security forces and had a primed explosives belt on him at the time.
Several more weapons were found in the vehicle, according to the IDF. The military said it was believed his killing had prevented another attack.
Defense Minister Yoav Gallant later issued a warning to “whoever is responsible” for the bombing, without explicitly mentioning the prime suspect, the Hezbollah terror group.
Between December 2018 and January 2019, the IDF conducted an operation to locate and destroy tunnels dug by Hezbollah into northern Israel from southern Lebanon. In total, it found six such passages and rendered them inoperable — either using explosives or filling them with concrete.
In January 2020, the IDF began installing a series of underground sensors along the northern border in order to detect any new subterranean tunnels being dug into Israeli territory from Lebanon.

On Saturday, a car with Israeli license plates driven by two German tourists entered the town of Nablus in the West Bank. When Palestinians noticed the vehicle, they began to surround the car and

attempted to drag the occupants out.
Gerald Hetzel, one of the tourists, told Israeli TV stations Kan and Channel 12 that he had visited Ramallah and Hebron on past trips to the region and came to Nablus on recommendation from friends.
“I’ve never encountered a situation like this. It was a very, very dangerous situation, and we really thought they wanted to kill us,” he said.
“Young men came from taxis around us … and started to knock on our win-
dows, to scream at us in Arabic,” he said. “They were bringing stones and a traffic sign and throwing everything against the car. After one or two minutes, they pulled out a knife and stabbed the wheels of the car, and also threatened my friend.
“I didn’t understand what they wanted. We tried to tell them in English that we are tourists, and we are not Jewish Israelis, that we are there to visit and see the town, but they seemed to not understand it,” Hetzel said.
“They continued coming after us and walking after our car. It felt like they were hunting the car,” he explained and said a PA police officer brought them over to the side. Even when the police officers told the crowd the disperse, the mob became even angrier.
“I really felt the hate from their eyes, and from the way they were acting. And they were throwing rocks, maybe double the size of my head,” Hetzel recalled.
He said he hadn’t understood the scale of the security sensitivities: “I thought they were only targeting religious-looking Jews, not international tourists.”
After police officials told the two men to try to get away, an Arab Israeli man then signaled the pair to follow him in their car and led the way out of the city through smaller streets. After they escaped the city, the Arab Israeli gave the pair a ride, because their rental car was so damaged.
“It doesn’t change my entire view on Israel. I think Israel is a very friendly country,” Hetzel said.
“It definitely changes my view on the Palestinians and the Palestinian Authority areas in Judea and Samaria,” he said, using the biblical name for the West Bank, then recalled a past trip to Bethlehem where he met a group of three 16-year-old boys.
“They told me if they meet a Jew on the street, they want to kill him, just like this. And I think it’s a big problem they have so much hate in their education,” Hetzel said.
A spokesman for the Palestinian Authority security services claimed Sunday that the attackers had feared the tourists had been Israeli forces, stressing they have “zero hostility” toward Germany.
Germany’s ambassador to Israel, Steffen Seibert, said on Twitter, “A mob attacking tourists because they don’t like their license plate is disgusting and cowardly.”
Israel is now the fourth-happiest country in the world, according to the



World Happiness rankings.
Israel’s 2023 fourth-place ranking, up from ninth last year, is its highest position since the UN-sponsored index began publication in 2012.
Finland is still at the top of the list. Afghanistan nabbed the most-unhappiest slot.
as the country returns to normal.
The Palestinian Authority was placed 99th on the list.
In addition to a personal sense of well-being, the happiness index takes account of GDP, social support, individual freedom, and levels of corruption, measured through Gallup polls conducted in each country.
The World Happiness Report is based on residents of 137 countries own assessment of their situation, as well as economic and social data. It assigns a happiness score on a scale of zero to 10, based on an average of data collected over a three-year period.
Residents’ assessments were taken before the recent judicial reform tumult. As such, it’s possible that Israelis aren’t truly as happy as they seem. But still, these results show that people are happy with the economic recovery since the pandemic and have hope and optimism
An Israeli man was shot and badly wounded in a terror attack while driving through the northern West Bank town of Huwara on Sunday.
David Stern, a native of Far Rockaway, NY, and a former U.S. Marine, was seriously hurt after sustaining gunshot wounds to his head and shoulder in the attack on the Route 60 highway. Even af-
ter he was wounded, he jumped out of the car to shoot at his attacker.
Footage from the scene showed the windshield of the car riddled with bullets. David’s wife, Rachel, was also in the car during the attack.
After a brief chase, troops located and detained the gunman, Laith Nadim Nassar, who had been wounded by the victim’s and troops’ gunfire.
The attack came exactly three weeks after two Israeli brothers, Hallel and Yagel Yaniv, Hy”d, were shot dead in a terror attack while driving through Huwara. In the wake of that attack, settlers staged a riot in the town, setting fire to homes and cars.
Huwara has long been a flashpoint in the West Bank as it is just about the only Palestinian town that Israelis regularly travel through in order to reach their residences.
After David Stern was attacked, Prime Minister Benjamin Netanyahu said he was praying for the “wounded hero” who succeeded in shooting the terrorist attacker, adding, “Whoever tries to harm Israeli citizens — will bear the responsibility.”
Hazem Qassem, a spokesman for the Hamas terror group, hailed the shooting, saying it was “a natural reaction to the occupation’s crimes against our people in the West Bank and Jerusalem.”
David and his wife have a small farm in Itamar where they raise sheep. David is also a well-known martial arts instructor.

today,” a reference to Or’s name, which translates to “light.”
Eshkar “showered nothing but goodness, love and giving on everyone who crossed his path,” his mother said. She thanked medical staff, family, friends and “all the people of Israel who were with us, who strengthened us, supported us and prayed.”
Prime Minister Benjamin Netanyahu said that “we hoped and prayed” for Eshkar to recover, but “our hearts are broken.” Opposition leader Yair Lapid wrote that “iron man Or fought until the last moment,” sending condolences to his family and friends.
Eshkar, 32, was critically hurt in the terror attack while on his way to a wedding with his friends Rotem Mansano, 34, and Michael Osdon, 36, who were also wounded in the terror attack. Osdon was released from hospital not long after the shooting; Mansano remains hospitalized although his condition is steadily improving.


The attacker, Mutaz Salah al-Khawaja, fled the scene before being gunned down not long after in a shootout with police officers and civilians.
Or Eshkar, one of the three men who were shot in a terrorist attack outside a café in Tel Aviv earlier this month, died on Monday, 11 days after he was wounded.
Roni Gamzu, director of Ichilov Hospital, said that “unfortunately, the severity of his wounds was deadly. After a heroic struggle of many days, in which we saw an iron man fight for his life, we were forced to declare his death.”
Natalie Eshkar, Or’s mother, said that “our light of uncommon quality went out

National Security Minister Itamar Ben Gvir signed an order this week barring a Palestinian radio station from operating inside Israel on the grounds that it is backed by the Palestinian Authority.
The order targets the Voice of Palestine, which is based in Ramallah but has offices in East Jerusalem and the northern Israel town of Kafr Kanna. The station is run by the PA’s Palestinian Broadcasting Corporation.
Israel Police arrived at the Voice of Palestine’s Jerusalem bureau in the Beit Hanina neighborhood and notified workers that the office had to shut down. Several Jerusalem-based Palestinian reporters were also summoned for questioning by police.
Ben Gvir’s order cites a law prohibiting the PA from carrying out political activities in Israel, which is regularly used by police to shutter Palestinian gather-




ings, including educational and cultural events loosely linked to Ramallah.
“I will not accept, and we will not allow incitement and support for terrorism and terrorists, neither by the Palestinian Authority nor by any other body,” Ben Gvir said in a statement. “The State of Israel is sovereign, and anyone who tries to fight us will find himself on the outside.”
The I’lam Arab Center for Media Freedom blasted the move as a “clear violation of freedom of the press in a country that claims to respect such freedoms.”
“Ben Gvir’s steps will not succeed in concealing the truth,” I’lam’s statement added, saying that the police order was further proof that the new Israeli government was trying to “hide its crimes in various ways.”
In 2016, the IDF shut down the Ramallah office of Palestine al-Yawm, or “Palestine Today.”
“The station is a part of the Palestinian Islamic Jihad organization and constitutes an illegal association,” the army said at the time.
rights established there starting from the date of the bill’s approval.
“There is no longer any justification to prevent Israelis from entering and staying in the evacuated territory in northern Samaria, and therefore it is proposed to state that these sections [of the disengagement law] will no longer apply to the evacuated territory,” reads the introductory text to the bill.
The bill’s passage erases “to some extent” the “stain on the garment of the State of Israel” left by the disengagement, it continues.

Israel’s Knesset on Tuesday voted 3118 to repeal articles of the 2005 Gaza Disengagement Law banning Israelis from entering and residing in four communities in northern Samaria.
The Gaza Disengagement led to the destruction and evacuation of the Israeli communities of Sa-Nur, Homesh, Ganim and Kadim in northern Samaria, as well as 21 communities in the Gaza Strip.
In addition to rolling back the articles (23-27) banning movement into and out of, and residence in, northern Samaria, the amendment stipulates that Article 28, which canceled rights regarding real estate in vacated territory, will not apply to

The Israel Defense Forces must now approve a military order allowing Israelis to return to those areas.
“Seventeen years of attempts, an uncompromising struggle, and a strong belief in the righteousness of this path converged into one moment when the Knesset plenum voted in favor of canceling the Disengagement Law,” Likud MK Yuli Edelstein, who sponsored the bill, said Tuesday.
“The State of Israel tonight began the recovery process from the deportation disaster,” he added in reference to the 2005 expulsion of some 8,000 Jews from their homes in Gaza and Samaria. “This is the first significant step towards real healing and settlement in Israel’s historical territories that belong to it.”
Edelstein sponsored the measure at the request of Samaria Regional Council chairman Yossi Dagan, who was among those expelled from the Samaria communities.
“This is a struggle we have been waging for 18 years and we finally see the light at the end of the tunnel,” said Dagan last month as the bill was making its way through Knesset committees.
“The deportees of [northern Samaria] – heroes who are standing with us as the tip of the spear in this struggle – will yet see recompense for their actions. The residents of the communities of Ganim, Kadim, Homesh and Sa-Nur will return within their borders,” he added, referencing a pasuk in Yirmiyahu.
A game of cat and mouse has taken place between the IDF and former residents and supporters since the Disengagement, particularly at Homesh, where a yeshiva has operated out of caravans and tents. Troops have dismantled the yeshiva several times over the years.
The coalition agreement between Likud and the Religious Zionism Party, led by Minister of Finance Bezalel Smotrich, requires the government to allow for the Homesh Yeshiva to remain as a first step towards rebuilding the four communities. (JNS)
According to new data from the U.S. Centers for Disease Control and Prevention, clinical cases of Candida auris, an emerging fungus, nearly doubled in 2021. Additionally, there was a tripling of the number of cases resistant to echinocandins, the first-line treatment for Candida auris infections.
The research, published on Monday in the Annals of Internal Medicine , evaluated cases of Candida auris reported to the CDC from 2016 – the year in which cases were first reported in the U.S. – to 2021.
Since then, the cases have increased each year but jumped in 2021 to 1,471 reported cases.
Cases of Candida auris also expanded geographically. Although it was initially confined mostly to the New York City and Chicago areas, Candida auris is now present in more than half of U.S. states. Between 2019 and 2021, 17 states identified their first cases.
The CDC has called Candida auris an “urgent threat” because it is often multidrug-resistant, easily spreads through health care facilities, and can cause deadly disease. It is also resistant to some common disinfectants and can be carried on people’s skin without causing symptoms, facilitating its spread to others.
Late last year, the World Health Organization released its first list of “ fungal priority pathogens ,” including Candida auris.
Candida auris itself first appeared as four strains on four continents between 2009 and 2015. All four strains have now been identified in the U.S., probably introduced through international travel.
Transmission of the fungus within the U.S. is largely driven by “poor general infection prevention and control practices in healthcare facilities,” the

38 authors of the new study said. Most of the transmissions take occur in postacute care facilities and ventilator-capable skilled-nursing facilities.
Fortunately, people who are healthy don’t usually get sick from Candida auris, according to the CDC. Rather, it’s more likely to affect people who have serious medical problems and require long stays in health care facilities, people with weakened immune systems, and people with medical devices going into their bodies, such as breathing tubes or catheters. Screening for Candida auris can help protect people at increased risk of serious infection.
strike expected to last three days. There are more than half-a-million students in the Los Angeles school district.

Service Employees International Union Local 99 members walked off the job after nearly a year of negotiations with the Los Angeles Unified School District. United Teachers Los Angeles, a union representing about 30,000 teachers, will participate in a solidarity strike this week and join the support workers union rallies
Superintendent Alberto Carvalho announced schools would be canceled for students starting Tuesday after last-minute negotiations, which included new raise offers, failed.
The union wants “equitable wage increases, more full-time work, respectful treatment, and increased staffing levels for improved student services,” it said. Workers’ average salary is $25,000 a year, and most work part-time – which has led to staffing shortages, the union said.
the union.
“Under California law, we cannot drive the school system into a bankruptcy position. We cannot drive the school system into a red position. And if we were to acquiesce to all the demands, that is exactly where we would be, that is not legally allowable,” he said.
If the three-day strike continues as planned, students will suffer, the superintendent said. The strike would make it “virtually impossible” to keep schools open in the district of more than 500,000 students.
According to the union, the strike is the only way to get their demands met.
“If the district doesn’t realize that our members are valuable … once they stop working, then nothing’s really gonna change,” said Max Arias, executive director of SEIU Local 99. “Ultimately, what we’re seeking is improving the schools – equity in schools. That’s what we’re seeking.”
that Covid-19 appears to have had a lasting impact on people’s behavioral choices when it comes to activity,” he said.
Brittain and his colleagues used data from the National Institutes of Health’s All of Us Research Program. Thousands of participants wore activity trackers for at least 10 hours a day over many years.

In the new study, published on Monday in JAMA Network Open, researchers compared steps taken by nearly 5,500 people who wore the program’s activity trackers. Most were White women, with an average age of 53.
According to the data, those who took the fewest steps were socioeconomically disadvantaged, under psychological stress and not vaccinated.
On Tuesday, the union representing 30,000 workers in the nation’s second-largest school district began a school
This is not the first time the district went on a strike. Back in 2019, union members went on a six-day strike after the teachers union demanded smaller class sizes, more school staffing, and higher wages.
Carvalho has tried to negotiate with
For now, if the strike goes as planned, children will be out of school. The district will offer help to families by opening 24 grab-and-go food sites and having 154 schools provide student supervision, plus about 120 city-run sites at libraries, recreation centers and other locations.
The Los Angeles Zoo is also offering free admission for students due to the closures, and its allday zoo camp program for students in kindergarten through 5th grade added two free “extended care” hours per day.
Interestingly, the pandemic did not seem to affect the steps of those over 60 years of age. Oddly, it was younger people between 18 and 30 whose step counts were most impacted, Brittain said. “In fact, we found every 10-year decrease in age was associated with a 243 step reduction per day.” That may be because younger people take advantage of technology available today instead of commuting to work or meetings.
He noted, “If this persists over time, it could certainly raise the risk of cardiovascular disease, obesity, hypertension, diabetes and other conditions strongly linked to being sedentary,” Brittian said. “However, it’s too soon to know whether this trend will last.”
In a previous study run by Brittain, he and his colleagues noted that overweight people could lower their risk of obesity by 64% by increasing their steps taken from about 6,000 to 11,000 per day.
Covid is to blame for many things, and here’s another thing to add to the growing list. According to a new study, Americans took fewer steps during the height of the pandemic – and they still haven’t gotten back into step.
“On average, people are taking about 600 fewer steps per day than before the pandemic began,” said study author Dr. Evan Brittain, associate professor of cardiovascular medicine at Vanderbilt University Medical Center in Nashville.

“To me, the main message is really a public health message – raising awareness
A mesmerizing display of lights streaking in the night sky over Northern California on Friday was caused by the reentry of flaming space debris into Earth’s atmosphere, experts said.
Specifically, flaming chunks of communications equipment, which were jettisoned from the International Space Station in February 2020, streaked across the sky at 17,000 mph, said Jonathan McDowell, an astrophysicist at the Smithsonian and Harvard Center for Astrophysics.


40 The orbit of the equipment had shrunk over the past couple of years until it got low enough to break apart and burn up.
“What you’re seeing is some actually very small objects releasing a lot of energy, very high up, traveling extremely fast,” he said.
The retired 700-pound communications antenna, called the Inter-orbit Communication System-Exposed Facility, went into space on a 2009 shuttle flight. About 10% of equipment like that might fall to Earth in small pieces, rather than melt on the way, McDowell said.
The equipment came down in an uncontrolled reentry, which means experts cannot predict where exactly the objects will land. McDowell said that pieces likely landed somewhere around Yosemite National Park. By contrast, the destination of equipment in a controlled de-orbit can be specified using rocket engines, he said.
Equipment the size of the one that created Friday night’s light show reenters Earth’s atmosphere every few weeks and has been doing so for the past 50 years, he said.
“They don’t happen very often over any one given place, so it’s always new to the people who see it,” McDowell said. “For me, it’s just another Tuesday.”
Debris that falls at night with clear
skies can create a captivating light display for observers, said Moriba Jah, an associate professor of aerospace engineering and engineering mechanics at the University of Texas at Austin.
But as the equipment burns, it can pollute the upper layers of the atmosphere, he said. Upon reaching Earth’s surface, the equipment can also contaminate oceans and land — and even injure people, though that scenario happens infrequently. (© The New York Times)
Mexico, threatening to dump noxious and possibly harmful piles across beaches and dampening tourism season.
Sargassum — the specific variety of seaweed — has long formed large blooms in the Atlantic Ocean, and scientists have been tracking massive accumulations since 2011. But this year’s bloom could be the largest ever, collectively spanning more than 5,000 miles from the shores of Africa to the Gulf of Mexico.

This year’s sargassum bloom began forming early and doubled in size between December and January. Traveling west, the blob will push through the Caribbean and up into the Gulf of Mexico during the summer. The seaweed is expected to show up on beaches in Florida around July.
robocalls. Robocall monitoring services say the effort has largely been successful at reducing the volume of robocalls. But in recent years, an explosion of spam and scam text messages appears to have taken their place, leading to more than 18,000 consumer complaints at the FCC last year.
The FCC is mulling additional regulations that could, among other things, apply Do Not Call registry protections to text messages for the first time.
Unwanted or scam robo-texts can be an even greater risk to consumers than unwanted robocalls, the FCC noted, because unlike phone calls, text messages may contain malicious links that can infect a smart device with dangerous software.
The beaches of Florida may be a bit smelly this summer. Scientists say that a giant blob of seaweed twice the width of the continental United States is headed for the shores of Florida and other coastlines throughout the Gulf of
Sargassum isn’t necessarily bad. When at sea, it’s beneficial for marine life, providing food and protection for fish and mammals. But when the seaweed hits beaches, it piles up and can emit gasses that smell like rotten eggs. Rotting algae emit hydrogen sulfide, which can be toxic. It also contains arsenic in its flesh, making it dangerous if ingested or used for fertilizer.
Mounds of algae are hard and expensive to clean up. The removal can also harm marine life. And, of course, the piles of smelly seaweed affect tourism, as people shy away from the beaches.
“Scam artists have found that sending us messages about a package you never ordered or a payment that never went through along with a link to a shady website is a quick and easy way to get us to engage on our devices and fall prey to fraud,” said FCC Chairwoman Jessica Rosenworcel in a statement.


The Federal Communications Commission is cracking down on spammy text messages with new rules for telecom companies, citing a surge of consumer complaints in recent years tied to unwanted robo-texts.
The new rules require phone providers to block text messages from suspicious sources including phone numbers that appear to be “invalid, unallocated, or unused.” Carriers will also have to block text messages coming from phone numbers that claim not to ever send text messages, or that the government has identified as numbers not used for texting, the FCC said.
The move mirrors a similar U.S. government effort to shut down illegal
He thought it was quartz, but it’s really just a big, ugly diamond.
David Andersen discovered a 3.29-carat brown diamond at the Crater of Diamonds State Park in Arkansas over the weekend.

Park rangers said it’s the largest diamond found at the park this year and the largest since last September.
“At first, I thought it was quartz but wondered why it was so shiny,” Anderson said. “Once I picked it up, I realized it was a diamond!”
Andersen found out about the park in 2007 and found a 1.5-carat white diamond while he was there for the first time. Since then, he has discovered more than 400 diamonds over the past 16 years, with 15 of them weighing over one carat.
Some of his other top finds include a 3.83-carat yellow diamond found in De-

cember 2011 and a 6.19-carat white gem discovered in April 2014.
Finders can choose the name of their diamonds. Anderson named his precious gem “B.U.D.”
“That’s for Big, Ugly Diamond,” he explained because of the diamond’s pitted surface and mottled brown color. He plans to sell the diamond, although we think he may need to change its name first.
According to the park’s website, over 75,000 diamonds have been found at the park since the first diamonds were discovered in 1906. The largest diamond — a white diamond with a pink cast weighing 40.23 carats — was found in 1924 during an early mining operation. In 2020, Kevin Kinard of Maumelle, Arkansas, found the second-largest diamond— a brown gem weighing 9.07 carats.
A rare gem.
He may be 90 years old, but he’s celebrating the birth of three of his children.
Mr. Pickles, a radiated tortoise native to Madagascar who now lives at the Houston Zoo, is the oldest animal on premises and has been living there for 36 years. Twenty-seven years ago, he
met Mrs. Pickles, his companion, who recently laid three eggs just as the zoo was about to close one evening. An eagle-eyed zoo employee saw the eggs being laid and rescued them, so they could be born in a proper environment as the soil in Houston isn’t conducive for incubating Madagascar-native tortoise eggs.
are no aid stations, phones, or GPS to help with navigation. Getting lost – as well as falling and getting injured in the brush – is par for the course.

This week, those three eggs hatched, and now Mr. and Mrs. Pickles have three lovely, little, hard-shelled babies.
This is not the first time the Pickles family had children shuffling around. The pair had one previous hatchling back in 1997.
Tortoises are critically endangered and don’t often produce offspring, the Zoo said.

The three new tortoises born were aptly named Dill, Gherkin, and Jalapeño. They will continue to be cared for at the Reptile and Amphibian House until they are old enough to join their parents.
That’s a sweet dill.
In almost 40 years, a grueling ultramarathon has only recorded 17 winners. Three of those winners ran through the finish line on Friday.
It was just the second time in the race’s history that three athletes managed to complete the Barkley Marathons in one year. The nearly-impossible competition, held in Tennessee, is the brainchild of runner Gary Cantrell (better known by his nickname Lazarus Lake or “Laz”). The route was inspired by the 1977 prison escape of James Earl Ray, who assassinated Martin Luther King Jr., and runs through Tennessee’s Frozen Head State Park.
Want to try it? Think again. The race consists of five loops of around 20 miles each, for a total of between 100 to 130 miles through brushy mountains with an elevation gain of around 63,000 feet. Athletes run the course over three sleepless days and nights – and there

How do judges know if runners really complete the course? The ultramarathon is marked with unique unmanned checkpoints, each of which contains a paperback book. Athletes must rip out a page corresponding to their bib number and have all the book pages in hand at the end of each loop to prove they reached each checkpoint.
For the past five years, no one has finished the race.
But this year finally broke that streak. Three athletes – French Aurélien Sanchez, American John Kelly, and Belgian Karel Sabbe – completed the exhausting five laps within the 60-hour time limit on Friday.

The only other time three racers completed the race was in 2012.
On Twitter, Kelly thanked his followers for their support. “Thank you to everyone for the support, and I hope some of what we get to discover out there is a shared experience,” he wrote. “Or, if we’re all just a bunch of idiots running around in the woods, that at least it’s entertaining.”
We’ll just sit back and watch.


As Klal Yisroel continues to remember Rav Chaim, zt”l, and all that he meant to us, the talmidim at Yeshiva of South Shore were privileged to be inspired by Rav Chaim’s son-in-law, Harav Yitzchok Kolodetsky, shlita. Rav Kolodetsky explained that Rav Chaim was zoche to an additional 20 years of life after his stroke because of his exceptional fulfillment of Kibbud Av v’Eim, and he described the daily visits that Rav Chaim would make to his parents each morning. Rav Kolodetsky related that Rav Chaim would encourage young children to always honor and thank their parents (es-

pecially their mother for preparing such a nice Shabbos)!
Rav Chaim would instruct Rav Kolodetsky that when he travels to America, he should encourage children to make brachos with kavanah and to be careful about not speaking in shul. He also would focus on honoring the Shabbos with divrei Torah, zemiros and above all having a Shabbat shalom, a Shabbos of peace without arguments or fighting!

Rav Kolodetsky told the story of an old man who learned together with Rav Chaim as a child in Yeshiva Tiferes Tzion. At the end of his life, he was so weak

that he didn’t even have the strength to open a Gemara, and yet when he began to learn, he would suddenly come to life with energy and excitement. When asked how he did it, he related the following story: When he was a child, the Chazon Ish came to farher the boys, and although he was very old and weak, he suddenly became animated and gave the boys brachos, telling them how much Hashem loves them for learning Torah and that Hashem is building worlds in Shamayim out of their Torah learning. The old Yid related that to this day, no matter how old and sickly he is, when he begins to
learn, he can still see the Chazon Ish and hear his powerful words!
Rav Kolodetsky then gave the boys at YOSS the Chazon Ish’s brachos and began to sing and dance together with all of the boys, thanking Hashem for the opportunity to learn our precious Torah every single day. The energy in the room was incredible as he led the singing and dancing, and then gave every boy an individual bracha to become a gadol b’Yisroel. HaRav Kolodetsky inspired the boys to connect to the legacy and teachings of Rav Chaim, zt”l, and connected them to the simcha that only Torah can bring!


This past week, Rabbi Adler’s shiur at Yeshiva of South Shore had the great zechus to be farhered by our Rosh HaYeshiva, Rabbi Mordechai Kamenetzky.
They, of course, were extremely well prepared. Each boy was chosen to either read, translate or explain the Gemara, and they did so with clarity and precision. Rabbi Kamenetzky was overjoyed to feel their confidence as they enjoyed an



exhilarating discussion about the Tosafos on the sugya of Mavriach Ari – when one saves a person’s possessions from a lion chasing them, how and when it applies. Most importantly, they are a sweet, fine and passionate group of young bnei Torah – a pleasure to see in action! IY”H, they will continue their learning with the same excitement and dedication displayed during their farher.
The talmidos of the Ganger Early Childhood Center at TAG celebrated a siyum on Sefer Shemos last week. They reviewed all of the parshios, sang their Shemos song (written by TAG’s Morah Goldie Sebrow) and received a special treat. Some talmidos even dressed up like characters from the Sefer.


The largest chocolate bar was made on February 6, 2020 and measured 26.8 meters wide by 14.4 meters high and weighed 13,073 meters.

Since its inception thirty years ago, Rambam Mesivta has incorporated activism into their core curriculum.



“It is essential to guide students to know what to do and to act on it. Speaking out in defense of Jews must be taught in word and in deed,” said Rambam Rosh Mesivta, Rabbi Zev Meir Friedman.
Rambam has held over 50 rallies over the years. Many successes have been realized as a result of these rallies. In some cases, Nazi criminals have been deported, and in other cases, they have been put on trial. It all depends upon the willingness of the government to cooperate. Most critically, Rambam students have learned to stand up against evil and injustice.
This past week, 200 students and staff from Rambam rallied outside the offices of the Lithuanian Consulate in Manhattan to protest the honoring of Jonas Noreika, the leader of a Lithuanian nationalist group responsible for the murder of hundreds of Jews during World War II. Media outlets covered the

story as the group chanted: “Your land is drenched in blood!”; “Take down the plaques!” (honoring Noreika); and “We will not forget!”
Speeches were given by Associate Principal Mr. Hillel Goldman, Rambam senior Azaria Sussman, and Rosh Mesivta Rabbi Zev Meir Friedman. During the rally, the Lithuanian Consulate asked Rabbi Friedman and 12th grader Azaria Sussman to come inside to discuss the purpose of the rally.
During the meeting, the Lithuanians advocated for the heroic stature they bestowed on Jonas Noreika, saying that Lithuanian courts proclaimed him inno -
cent and is thus worthy of honor. Rabbi Friedman and Azaria responded by saying that vast documentation exists about Noreika and his actions and that the Lithuanian court ruling was illegitimate. The Lithuanian ambassador bristled and simply said, “Everyone has a narrative.”
The students at Rambam were very disappointed to see that the government of Lithuania remains stridently anti-Semitic despite their protestations. However, “they do realize that Jewish groups will continue to protest their corruption, and know that the Jewish community did not forget,” said Rabbi Friedman.


Recognizing a national shortage of qualified teachers in Jewish and special education, Touro University and SINAI schools have partnered to create The SINAI Teacher Fellowship Program, beginning this fall. This trailblazing collaboration offers current and prospective SINAI faculty the unique opportunity to earn a graduate degree at a greatly discounted tuition, while also receiving full compensation as an assistant teacher at SINAI and hands-on training and mentorship from experienced SINAI educators.
SINAI Teacher Fellowship Program participants will study for Touro University’s Master’s Degree in Jewish Education and Special Education, a twoyear program that prepares its students for careers in special education. Anyone who has not yet earned a master’s degree in education (whether or not they are a
current SINAI faculty member) is eligible to apply to SINAI to join this program, while also applying to Touro’s Graduate School of Education.
“This collaboration with Touro University, an educational powerhouse with a strong reputation in Jewish and special education, will produce a new cadre of highly trained special education teachers,” said Rabbi Yisrael Rothwachs, the Leo Brandstatter z”l Dean of SINAI Schools.
Fellows will receive significant scholarship incentives towards their master’s degree, and will work concurrently at SINAI as assistant teachers, with full compensation. Graduates are eligible for dual licensure in Education and Special Education from the New York and New Jersey Departments of Education.
“This exciting new partnership reflects the foresight of Rabbi Rothwachs and the SINAI School leadership in fo-
cusing and committing to furthering the professional development of their teachers and staff,” said Dr. Jeffrey Lichtman, the Lucille Weidman Director of Graduate Jewish Education/Special Education at Touro University.
“This relationship brings together SINAI, a leader in special education throughout the New York metropolitan area, and throughout the Jewish world, with Touro’s Graduate Jewish Education/Special Education Center, a leader in training teachers, and the only institution offering teacher training in Limudei Kodesh/Jewish Studies instruction within graduate special education. We hope that this partnership inspires new creative ideas to bring more dedicated individuals into Jewish Education/Special Education, and provide them with the guidance and education necessary to be able to develop highly trained and caring teachers, rebbeim, and morahs for the
When it comes to saving a life, we all know that every minute counts.
When Justin Wallace was shot in Edgemere at the tender age of 10, he was rushed to the nearest hospital: St. John’s Episcopal Hospital. There, doctors and nurses did all they could to save his life. But he could not be revived.
St. John’s Episcopal Hospital is the only hospital in the Rockaways. But cru-
cially, St. John’s does not provide trauma care. Those who experience major traumas – people who are shot, or stabbed, or in a car accident – must travel miles off the peninsula to reach a certified trauma center. It can take up to an hour for a trauma victim to reach a facility equipped to save their life. By that time, it is often too late to administer care.
Based on size alone, St. John’s does not have the capacity to fully serve the community. The numbers tell a clear story: a hospital with a 257-bed capacity is not large enough to provide comprehensive
care to a quickly growing population of 124,728 on the Rockaway peninsula (and of 66,856 in Far Rockaway alone). While recent capital upgrades have added to St. John’s capacity and services, the hospital’s current footprint is insufficient for the growing Far Rockaway community.
Overutilized areas compound the devastation the COVID-19 pandemic inflicted on underserved communities. In May 2021, Modern Healthcare reported that one in every 146 people died of COVID-19 in Far Rockaway. This seaside community contained the second deadliest zip code during the height of the pandemic. Its vaccination rate of 64% in June 2022 was among the lowest in New York City, 15% below the citywide rate. To further complicate matters, recent construction has strained access to vital resources. As the community expands its stock of affordable housing, residents need access to vital healthcare options.
Far Rockaway was not always so vulnerable to healthcare emergencies. The community once had two hospitals. For 104 years, Peninsula Hospital operated in Far Rockaway as a 272 inpatient-bed and 200-bed long-term care and rehabilitation facility. Alongside St. John’s, Peninsula Hospital addressed many healthcare needs in the community, from ambulatory to emergency and surgical.
children in our communities,” Lichtman added.
Rothwachs concurred. “The fellowship is also an opportunity to identify and engage early career ‘stars’ in the field of Jewish special education, and they will benefit from receiving hands-on supervision from experienced SINAI educators,” he said.

Applications for the SINAI Teacher Fellowship Program are open now for the fall semester. For more information on the program, email fellowship@sinaischools.org.
However, after financial troubles and the release of the Berger Commission’s infamous report, Peninsula Hospital closed in 2012.
It should not take an hour for those in desperate need of care to reach a facility that can help them. We need a facility with staff and the capacity to handle patients like Justin Wallace. Stories like his break my heart and highlight the alarming lack of services for those who live here in the Rockaways.
That’s why I launched the Far Rockaway Trauma and Healthcare Access Taskforce – to explore how we can bring a trauma care facility to the Rockaway community. The Taskforce is in the process of surveying the Peninsula to assess our Trauma care needs and we encourage all residents to complete a simple survey by March 10th that can be accessed at this link – https://bit.ly/3S4aePn.
Survey responses will provide vital community feedback and guide the work of the Task Force going forward.
Without a certified trauma center nearby, victims of trauma are too often deprived of life-saving care simply because they could not reach a certified hospital in time. We deserve a facility in the Rockaways that meets our healthcare needs. The lives of community members depend on it.

HALB Middle School celebrated Pi Day in their math classes last week. Students discussed and discovered pi by examining random circular objects. By measuring the distance around the circle, and dividing by the distance across the center of the circle, we can get the constant pi. Students came to recognize that this will work regardless of the size of the circle.
Mrs. Auman’s math classes did something a little different: “The Magic Circle.” A simple circular piece of paper can teach a surprising number of geometric concepts. The students folded and unfolded their circular paper in order to observe, compare, and draw conclusions. By being engaged in this hands-on activity, students were able to see geometric concepts in a real world context.
Students at HALB’s Lev Chana are excitedly preparing for Pesach







Summer camp campuses often lay quiet during the cold winter months, but Camp Simcha’s sprawling 125-acre campus in upstate New York was filled with laughter, friendship, and learning this past weekend for the Chai Lifeline LH Family Retreat for families living with pediatric cancer. Families from New York, New Jersey, Pennsylvania, Ohio, Texas, Florida, and California had an opportunity to connect with other Chai Lifeline families facing similar challenges, gaining support from their peers while tapping into the knowledge of a team of professionals, to help navigate their medical journey.
The Chai Lifeline retreat featured programs and activities that delivered educational tools, inspiration, solidarity and simcha. The weekend included a keynote from Chai Lifeline’s CEO Rabbi Simcha Scholar and insightful guidance from Dr. David A. Pelcovitz on developing “A Toolbox for coping,” which taught parents critical skills in managing through crisis. Peer support groups were available to parents, facilitated by Dr. Pelcovitz and Esther Leah Sandhaus, MSW, regional director in the Southeast. Children enjoyed programming for all ages, including a Game Show hosted by the Schnitzel Guys and a Shabbos party, filled with treats and singing. When Shabbos was over, families enjoyed a Motzei Shabbos party and a Melave Malka. From start to finish, connections were created, and memories were sealed.
One participant shared, “What an amazing difference a short weekend can make in providing us with the opportunity to learn from each other and the expert staff...we experienced tears, laughter and learning.”
Hosting the weekend getaway at Camp Simcha allowed parents to see where hundreds of children experience a sanctuary of hope each summer, strengthening their spirits. The Chai Lifeline team of volunteers and staff recognize that there is human need behind every call for help and this program delivered that and more in a relaxed environment with friends, old and new alike.
“Witnessing families getting away to receive the much-needed support they deserve is truly awe-inspiring,” shared Chai Lifeline’s National Director of Client Services, Rabbi Mordechai Gobioff, MSW. “The serenity of Camp Simcha promoted calm and family connection. A weekend in a supportive environment helps every member of the family feel less isolated and more loved.”

On March 14, Legislator Mazi Melesa Pilip joined with Nassau County Police Commissioner Patrick Ryder, Israeli Activist Rudy Rochman, Avi Posnick of StandWithUs, and Andrea Bolender of Voices4Truth to sponsor a forum called an Open Conversation about Antisemitism and What We Can Do. The event, which filled Young Israel of Great Neck, started the conversation about how to combat the ongoing number of antisemitic attacks around the country, including in New York.

Did you know?
The forum was hosted by Times of Israel’s Scott Cushing and opening remarks were given by Rabbi Shmuel Ismach.
“Around the New York area, Antisemitic attacks have been on the rise, leaving many Jewish people feeling very unsafe,” Legislator Mazi Melesa Pilip said. “We need to fight back, and this forum was the first steps in putting an end to this crisis. I was very happy with the large turnout, and the enthusiasm for taking on this issue. Hate has no home in Nassau County.”
German chocolate cake was named for Sam German, who developed a sweet bar for Baker’s Chocolate and was not from Germany.
MACS (Modesty Awareness Committee by Students), part of the Stella K. Abraham High School for Girls’ LEV (Living Enhanced by Values) initiative, organized an incredible program on Tuesday, March 14, analyzing the power of non-verbal communication.

Popular mentalist and magician Ben Cohen stunned the SKA students of every grade in a presentation predicting the choices students would make and “reading their minds” with a perfect score each time. He explained how one’s body language and nuances in speech can indicate what the person is thinking; it was an excellent introduction to the student-led workshops that followed.
How we conduct ourselves and what choices we make were the goals of the MACS workshops. Our mannerism, ex-

pressions, and posture send a clear message of who we are as do the choices we make about what and how to wear clothing. Demonstrating the role of unspoken language, SKA teachers and student workshop leaders used celebrity images, airport security and jury selection to illustrate their points.
Stressing the Torah’s view on how non-verbal communication relates to tziniut, the SKA workshop sessions included student-produced videos and slides with scenarios depicting girls in different situations. The girls also distributed an engaging booklet they compiled with an inside view to the world of body language.
Yashar koach to SKA faculty advisor Mrs. Paghit Ralbag, teachers and the MACS student leaders for organizing and facilitating this powerful event!


Shulamith Elementary School’s Connection with Direction events brought parents and educators together in support of our collective efforts to provide safe and wholesome boundaries for our children in a digital world.
Rabbi Avraham Robinson and Mr. Ariel Kamel spoke about the effects of technology on our children and gave practical advice for understanding children’s thought processes, their sense of self and self-esteem, and how we can help them safely and effectively navigate this digital world.
Following the impactful event, the Shulamith administration introduced TIPS (Technology Incentive Program @ Shulamith), a program that encourages
students to be responsible digital users. The girls have responded very positively and are signing up voluntarily to limit their technology use during the week.

On Wednesday, March 15, HANC hosted Rabbi Doron Podlashuk, the publisher from Tzurbah M’Rabanan, along with program representative Mr. Eli Seiden who visited classes and met with halacha teachers to discuss the benefits of this extraordinary innovative approach to learning halacha.

The Tzurbah M’Rabanan system was devised by Rav Algasi in Eretz Yisroel and quickly caught on with many Chaburot being established all over the country. The idea is to work through a Sugyah (topic) by starting with the source in Tanach and following through the generations to see the Mishna, Gemara, Rishonim and Acharonim as they discuss the different aspects and applications of the halacha.
A few years ago, the curriculum was brought to various schools outside of Eretz Yisrael, and many of the sources were translated and color-coded to en-
able easier access for non-native Hebrew speakers. This past year, HANC has piloted the curriculum for the boys in grades 9 and 10, resulting in an enthusiastic renewed interest in Daily Halachah Living. A unique HANC feature is that the general editor of this work is a HANC alum, Rabbi Eli Ozarowski ‘96, and includes snippets from former HANC Rosh Yeshiva, Rav Shlomo Wahrman, zt”l.
Over lunch, HANC halacha teachers provided feedback and made suggestions for further improvement of the English-based Tzurbah M’Rabanan including networking amongst the other six high schools currently implementing the system. This would enable sharing of school produced halacha videos and assessments.
HANC High School looks forward to future collaboration with the Tzurba M’Rabanan team and continued success.
The much anticipated JHS Girls Shabbaton began at the beautiful Bushkill Inn last Friday afternoon. Students swam in the indoor pool and participated in exciting “Pre-Shabbat ruach” to welcome in Shabbat with singing and dancing. The energy continued throughout the evening.

During dinner, divrei Torah were given by Ilana Ismailov, Binah Baturov, and Eva Musheyev. Mishnachas Adar Marbin B’Simcha doesn’t stop after Purim! Students then watched eighth grade students put on a hilarious skit to continue bringing the Adar spirit to the student body.
Students then had the opportunity to hear from the absolutely incredible Mrs. Devorah Goldstein. As an infant, Mrs. Goldstein was abandoned in a train station in Taiwan and found by a Jewish American Professor, Avraham Schwartzbaum. Professor Schwartzbaum and his wife Rachel later adopted Devorah, moved back to the U.S., became more observant, and Devorah converted to Judaism. The remarkable story is detailed in the book, The Bamboo Cradle.
Throughout the Shabbaton, Mrs. Goldstein shared her remarkable story and described her life and the struggles she faced growing up. She shared inspiring anecdotes and grabbed the attention of every single student. Her presence was one of, if not the, highlight of the Shabbaton. After students heard from Mrs.
Did you know?
Goldstein, it was the morot’s turns to put on their own hysterical skit.
Shabbat morning kicked off with tefillah and a kiddush, and then students participated in an entertaining custom YCQ-themed game of Apples to Apples. After a delicious lunch that featured divrei Torah from Ilana Zavulun, Moria Cohen, and Rena Schwartz, more games were played with the Morot, including Jeopardy! and Order in the Court.
Students had another opportunity to hear from Mrs. Goldstein before an exciting raffle. Faculty contributed individual prizes including lunch with teachers. Mincha and a meaningful seudat shlishit followed and included divrei Torah from Naomi Matatov, Mia Aranbaiev, and Aylea Moussaieff.
After Maariv and Havdalah, the ruach train was full steam ahead with a musical Melave Malka that featured more singing and dancing. Sweatshirts were given out that will help students remember all the amazing memories they created on the Shabbaton.
Thank you to the alumni advisors for giving back to the YCQ family. Special thanks to Mr. Jacob Grossman, the Director of JHS Student Life and Activities, for all of his effort organizing the Shabbaton, a huge thank you must also be given to all the morot and administrators, and their families, whose presence truly enhanced the Shabbaton.
Benjamin Franklin sold chocolate in his print shop in Philadelphia.


Mercaz Academy fifth and sixth graders collaborated to create a wonderful fair to educate all at Mercaz Academy about every aspect of the bracha “Asher Yatzar.” This fair culminated the school-wide, co-curricular examination of this bracha, said after using the bathroom and reflecting our appreciation of the wise way in which Hashem created our bodies.
Sixth graders set up booths to share their studies on the digestive system, while fifth graders focused on the meaning of the bracha. Exhibits focused on the teeth and jaws, the mechanics of swallowing, the stomach, the small and large intestines and, yes, there was even a fun discussion about the end product. Among other activities, visitors were challenged to correctly place the organs, guess the length of the small intestine (22 feet!), and answer questions about vitamins and nutrition.

The fifth graders, inspired by the design of the digestive system, challenged everyone with amazing mazes. Students could only escape the full-sized maze by answering questions about the meaning of the words in Asher Yatzar. They could only navigate the floor maze with mirrors, highlighting the clever design of the human body. Finally, students sent a ball through a model of the small intestine, steering it by blowing through straws.

The very last booth challenged everyone to write a specific note of thanks to Hashem, and featured a competition to see if teachers or students were more thankful (students, having an advantage in numbers, would seem to have triumphed here).

“I was so impressed by this fair,” said Rabbi Fogel. “I am in awe of the way our students brought together science and Torah into one expression of gratitude to Hashem. They used their creativity and their leadership to teach a beautiful lesson to our younger students. And Rabbi Moshe Rubel, Rabbi Avi Kramer, and Mrs. Liz Gonzalez-Spagnuolo collaborated so beautifully–educationally and programmatically – to make all this possible.”

“AsherMrs. Silver’s fourth grade students at Yeshiva Ketana of Long Island using their protractors
We are delighted to announce the opening of the very first of its kind, a chessed house for the women of the Five Towns. The Manchester, located in the heart of The Five Towns, is set to have the grand opening on May 14, at six o’clock in the evening. Please mark your calendars!
The Manchester has been created l’ilui nishmas Daniella’s beloved father, Mannie Cahn, z”l, and l’ilui nishmas Chavi’s dear mother, Esther Eichor, a”h. Our objective is the creation of a warm and inviting space which will ultimately enhance the lives of our community members, bridging the generations of women. It will be a place to give, receive, connect, and inspire.
Our programming will be diverse and most enjoyable. Come join us to hear inspiring speakers, engage in creative activities, and enjoy musical recitals. Additionally, we will be running various support groups. Affordable pop-up shops before the major holidays will provide a lovely shopping experience. Art classes will be offered. Our game room and library will provide hours of fun and companionship for our members.
This all began as a small initiative, organized by young mothers in their homes, reaching out to senior sophisticates in the neighborhood to share lunch and entertainment. Started by eight volunteers and a dozen women, this soon evolved into a monthly get together of 5075 women. The only compensation these young volunteers sought was a fun-filled afternoon of camaraderie, music, fun and learning. Look how this project has evolved! Hodu l’Hashem!
With the opening of The Manchester, a larger number of women will be able to participate in broader programming. Previous participants along with new members will have the chance to meet on a regular basis. Seeds will be planted for blossoming friendships.

As the kickoff for the grand opening of the Manchester, we are calling all young artists, ages 10-16, to submit creative and original works by May 7. Our theme is “Kindness Through the Ages.” The judges panel will include Peshi Haas, Yaeli Vogel and Suzie Libin. The grand prize winner’s artwork will be purchased by The Manchester for $550 and will be dis-
played in the lobby. The runner-ups will have their works purchased as well by The Manchester for $250. To register for this competition, please email TheManchester5T@gmail.com
The original “Ladies and Lattes” team is eagerly looking forward to greeting you at the inauguration of the newest, most exciting project of the 5 Towns. Mazal tov to all!
Most sincerely, Daniella
Wolfson & Chavi MandelbaumAt the Chasdei Lev of Far Rockaway and Five Towns Peninsula Passover food distribution. Pinchus Hikind was representing City Comptroller Brad Lander, Motti Hellman, Nochum Wolf, Tzali Guttman, and Mo Brecher, leaders and individuals involved with Chasdei Lev.

On Wednesday, March 15, the HANC High School Girls’ Torah Bowl team defeated SKA to win the Eastern Division!


In order to move on to the final round from their position in second place, the HANC team first defeated North Shore. Once the team advanced to the final round, they had to win 2 out of the 3 rounds to be named the winners. After

Lechu V’Nelcha of Far Rockaway and the Five Towns continues to hold weekly shiurim for post-seminary girls. These past few weeks have been full of inspiration! LVN held two pre-Purim shiurim. Rabbi Daniel Glatstein spoke Sunday night, February 19, about hashgachas Hashem as the theme of Megillas Esther. The following week, Mrs. Adina Waldman spoke about the true meaning of simcha and how to attain it. Following Purim, we were privileged to hear from Rabbi Birnhak for a shiur on hilchos kibbud av v’eim. Getting into Pesach mode, this past Sunday, Mrs.

a narrow loss in the first round, HANC won by a large margin in the following two rounds, winning the division and advancing to the championship! Yasher koach to Morah Batsheva Fink and to all the team members on their hard work and on their success in interpreting correctly the highly specific questions of this competition.
Yaffa Jungreis spoke about the hischadshus of Rosh Chodesh and Nissan. LVN thanks the Agudah of the Five Towns and The Agudas Yisroel of West Lawrence for graciously hosting us.
This coming week, we are excited to once again be having Rabbi Shaya Cohen. LVN invites all post high school/seminary girls in the community for a special pre Pesach shiur, this Sunday, March 26, at the Agudah of the Five Towns, at 8:15 PM. As always, to stay informed about future events or to sponsor a shiur, please email lvnfarrockaway5t@gmail. com. Looking forward to greeting you!
Mehadrin Dairy Co. donated a few pallets of high-end dairy products to help feed the needy at Masbia of Boro Park as part of turning over their inventory to Kosher for Passover

Since last Sunday, a group of MTA talmdim have been on the ground in Romania helping to resettle orphans displaced by the ongoing war in Ukraine. It is a special privilege for these talmidim to assist on the mission, run by the Tikvah Fund and NCSY. It is one thing to learn about chessed in a theoretical sense, but during their time in MTA, the talmidim chosen for the mission have been inspired to put their learning into action and they have been making a profound impact for children who are desperately in need.

Yeshiva Darchei Torah menahel Rav Dovid Morgenstern presenting a plaque to fifth grader Michi Zakai in Rav Goldbaum’s class in honor of his being mechaven to Tosfos’s kashya for the first time. The plaque features a copy of the amud with the Tosafos highlighted and an inscription at the bottom commemorating this tremendous accomplishment.



Every year, MTA seniors participate in the Names Not Numbers Project. Created in MTA, the program, which aims to record and preserve the accounts of Holocaust survivors, has spread to several schools in the tri-state area. However, the participants from MTA take the unique additional step of traveling to Poland to learn about the
Holocaust on the very ground on which it occurred. Accompanied by MTA Rosh Yeshiva, Rabbi Michael Taubes, the talmidim experienced something they will surely never forget, and they have gained an insight that will help them in creating their final Names Not Numbers project, preserving the stories of survivors so that we surely never forget.
“Do not duck. Lean in and fight. Antisemitism is no different than cockroaches. You either turn the light on or it will spread.” Those words of advice were given by former Vice President Mike Pence to Rav Dovid Hofstedter, Nasi of Dirshu, in a private meeting earlier this month.
Pence was responding to a question by Rav Hofstedter as to what is the best way to fight the increasing, drastic uptick in antisemitic acts against the Jewish community: “Is it better to duck it or combat it?” Pence was emphatic that the only way to fight antisemitism was to unapologetically combat it, head on.
The private meeting with Mr. Pence transpired in New York where Rav Hofstedter was invited to be the guest speaker at the Israel Heritage Foundation event that featured Vice President Pence.
The background behind the private meeting with Pence was Rav Dovid’s increasingly deep concern over a conglomeration of recent events that clearly show bias and hatred against the Jewish community and especially the visibly Orthodox and Chassidic community. The attacks are coming from both the right and the left. Especially concerning are the attacks from the left, from the academia and the progressives who are spearheading an effort to force government intervention into the chinuch we give in our schools. They are also proving to be implacable foes of Israel and by extension, the millions of Jews who live there.
There is also an increase in antisemitism and antisemitic attacks from the right by white supremacists and bigots who have always expressed antipathy to Jews. All of this has caused great concern to Rav Hofstedter and, as a son and son-in-law of Holocaust survivors, has spurred him to action.
Although Dirshu’s primary mission is increasing limud haTorah, not shtadlanus, Rav Dovid passionately feels that someone who has the ability to influence public discourse on burning issues regarding the perpetuation of Torah is obligated to invest whatever effort he
can. Whether he is trying to help combat government regulation against chinuch, which is essentially thinly disguised antisemitism and anti-religion, or whether he is trying shtadlanus for Acheinu Bnei Yisrael in Eretz Yisrael who are under fire from the international community and the left for simply defending themselves, it is his obligation to try!
Pence: The Rise of the Secular Left Does Not Bode Well
That was the reason for the meeting with former Secretary of State Mike Pompeo in January and more recently with Vice President Mike Pence and addressed an event with Pence in attendance.
As Rav Dovid entered, Pence, the former vice president, a religious man, stood up, greeted him and expressed how he felt honored to be in the presence of a Torah scholar and leader such as Rav Hofstedter.
After the two sat down, Rav Hofstedter began the meeting by raising the issues currently worrying the Orthodox Jewish community. He specifically mentioned concerns that the community has regarding the denial of basic freedoms that the community has suffered – in the realm of education and otherwise. He also highlighted the tremendous assault the community has experienced on the part of the mainstream media, who have clearly been shown to have a biased agenda against visibly Orthodox Jews and specifically against our institutions of chinuch
When Pence was asked what he thought was the best way to combat this kind of antisemitism, Mr. Pence replied emphatically with the above-mentioned words, “Do not duck. Lean in and fight. Antisemitism is no different than cockroaches. You either turn the light on or it will spread.”
The Vice President went on to note that the rise of what he described as “the secular left” is on a collision course with Israel and has led to a great deal of antipathy on the part of certain elements of the Democrat Party.
“The rise of the secular left is inconsistent with support for a Jewish state,” Pence went on to say.
In an astute and insightful commentary, Vice President Pence clearly noted that things have changed in America
regarding support for Israel. The left in America is becoming more like Europe that has an affinity for the Arabs and casts blame for the intransigence of the Arabs on the Jews. A classic antisemitic position.
That is how the caucus to combat antisemitism came up in the conversation.
The Vice President went on to suggest to Rav Dovid that there’s a need for a caucus in Congress to combat these issues related to antisemitism. He suggested that Rabbi Hofstedter work with the caucus that the Vice President had previously chaired during his time as a Congressman from Indiana. When Rav Dovid replied that he had worked toward the creation of a Congressional Caucus for Torah Values with the express intent and purpose of combatting this manifestation of antisemitism toward the Orthodox Jewish community, the Vice President replied that indeed, he had heard of the caucus and of its work, “That’s terrific; and just what is needed.”

The Vice President, engaged as ever, then asked, “Who’s chairing the caucus?”
Rav Dovid responded that it was a bi-partisan commission chaired by Congressman Don Bacon of Nebraska and Congressman Henry Cuellar of Texas. The Vice President, apparently very satisfied with the chairmen, replied, “That’s just what’s needed.”
Indeed, both Vice President Pence and Secretary of State Mike Pompeo took
pains to stress how important it is for the Jewish and especially the Orthodox community to make their voices heard and not back down thinking the problem will just go away.
It is important to reach out to politicians, to members of the press who are willing to tell the truth and to use every avenue available, both in government and otherwise to fight against antisemitism, especially the type of genteel antisemitism under the guise of human rights. Whether the antisemites target the rights of Jews to give their children a religious education or whether they target the Jewish State for their “Apartheid” policies towards the Palestinians, they must be combated with everything we have and all tools at our disposal.
Indeed, that was the focal point of the speech that Rav Hofstedter gave in the aftermath of his meeting with Vice President Pence in his presence.
He opened the speech at the Israel Heritage Foundation event by expressing what a great honor it was to be in the presence of a great American, a great statesman and leader who has served the United States with such honor and distinction. He also praised Pence as a great and true friend of the State of Israel, expressing the heartfelt gratitude of the Jewish community for the friendship
Pence has shown and emphasizing how much it is cherished.
He spoke about his fears regarding the great uptick in antisemitic incidents and his alarm over the fact that antisemitism has become acceptable in many quarters in parlor meeting company. Something that was unheard of in the recent past.
He said that just in the past few weeks, there have been incidents of violent attacks on visibly Orthodox Jews, hate literature, the desecration of a synagogue, and the outrageous desecration of the New England Holocaust Memorial in Boston.
“Things have gotten so bad, that even those who speak out against antisemitism have been vilified for speaking up and calling it by its name.
“Therefore, the most important question is not only what we can do – it’s also what we must do.”
Rav Hofstedter said that as people of faith we must believe in and cherish our ability to be able to keep our traditions. We must show mutual respect and at the same time show the courage of our convictions.

He praised Vice President Pence as the embodiment of this ideal.
“You have demonstrated in public office the dignity and grace as well as the courage of your convictions. You have stood up for your principles in the face of criticism, being proud of your faith, your country, the constitution. You have stood by your friends and what a great and loyal friend you have been!”
Rav Dovid said that as a son and sonin-law of Holocaust survivors, “we must take inspiration from the survivors. They came to these shores broken and penniless after having endured the tortures of the Holocaust. They didn’t back down. They had the courage to rebuild their lives from nothing.

“We must emulate them, have faith
in our beliefs, pride in our heritage and pride in each other. We must not back down or be intimidated.”
Rav Dovid thundered, “If we will have the courage of our convictions, our enemies will not succeed! If we don’t have respect for each other, cherish our beliefs, our religion and our homeland, they certainly won’t.”
He concluded his address with a powerful charge, “If we don’t stand up for each other, we leave the door wide open for them!”
In a conversation with this writer Rav Hofstedter outlined his hashkafa regarding shtadlanus
“Not everyone is able to engage in shtadlanus with politicians but for those who can, we have ample evidence from the previous generations of Gedolim that this kind of hishtadlus is very important.
“I remember once speaking to HaGaon HaRav Aharon Leib Shteinman, zt”l, about the great Rav Meir Shapiro and his impact on the Jewish people with his revolutionary innovations such as the establishment of the Daf Yomi and the founding of Yeshivas Chachmei Lublin that raised kavod haTorah in an unprecedented way during the pre-war depression years in Europe. Rav Shteinman pointed out that another important accomplishment of Rav Meir Shapiro was that he was a representative in the Polish Sejm, the Polish parliament, where he engaged in shtadlanus on behalf of his brethren.

I knew that Rav Shapiro himself did not attribute much value to his efforts in this regard, but it is clear that Rav Shteinman valued them tremendously.
“For those capable of engaging with politicians and other people of influence, although at times it looks like these efforts are futile, the reality is that you don’t

know what kind of impact you make on people with access to power. Sometimes we don’t see the fruits of our labor right away either, but it can have a real impact.”
He then spoke on a personal note.
“Both my parents survived the war, and I barely had family after the war. Hashem, in His kindness, however, spared my paternal grandfather, Reb Zev Hofstedter, who had served as Rosh Hakahal in his community in Hungary. He had lost everything, most of his family and his community. When I was growing up, he lived near us in Toronto. Every Friday night, we would visit him. He constantly bemoaned the great losses, the loss of the talmidei chachomim, the unique way and rhythm of Torah life in Hungary where he was born and raised. He would say, ‘Where was America when six million Yidden were being killed?’
“We didn’t have the voice in the government back then. We must therefore use our voices and raise them when we see such a precipitous rise in antisemitism.”
In the meeting with Mr. Pence, the
Vice President pointed out that he had done much work to combat antisemitism with the late Congressman from California, Mike Lantos, who himself was a Holocaust survivor. “When Congressman Lantos asked me to chair the Congressional Anti-Semitism Task Force, I did so with great pride.”
The underlying message expressed by Rav Dovid Hofstedter is that yes, our primary mission is to be engaged in Torah and tefillah and promote the learning of mussar and ethical behavior and without a doubt these hallowed activities invoke tremendous rachmei shomayim on behalf of Klal Yisrael. At the same time, our tradition and mesorah from Gedolei Yisrael from previous generations is that those who have the ability to engage in hishtadlus on behalf of their fellow Yidden to help combat and rescind gezeiros should avail themselves of every effort possible to engage on Klal Yisrael’s behalf, because “if we don’t stand up for each other, we leave the door open for them!”
Mrs. Shoshana Ayzin’s 3-4 grade CAHAL class at YOSS finished writing research essays and creating projects about Native American tribes. Mainstream third graders were invited to see their displays and learn about the tribes. The students did a great job and celebrated with a class party.

Last week, the HALB debate team traveled to Moriah for their third debate of the year. HALB, Moriah, and BPY debated the resolution: “The United States Should Ban the Death Penalty.” At the debate, HALB took home a total of three awards! First place speaker went to Sammy Libkind, second place team went to Moshe Broder and Sammy Libkind, and third place team went to Noa Berman and Leah Fistel. Congratulations!


The Camp Scholarship Fund, which is a campaign of the Matzliach Organization, launched three very successful fundraisers these past two months, starting with Rabbi Goldman from Rambam who headed an all-boys football game to help raise funds for our organization. A fun time was had by the boys. We thank Rabbi Goldman and the boys for making the game a great success!

We also wanted to thank Mrs. Debra Green and Mrs. Ralbag for putting together a Bowl-A-Thon dinner with SKA at Woodmere Bowling. The girls radiated with their glow-in-the-dark headband and bracelets that were handed out. The girls had a wonderful night out eating, bowling, and enjoying each other’s company.
This year on Purim, 50 boys from local yeshivas got involved and went around to various homes for The Matzliach Organization. They did a terrific job collecting with their friends. Thank you to all the boys who collected and individuals who gave to this organization to send children to camp!
Every year, we have a frum all girls 5K Color Run, which is coming up Sunday, March 26 at 10:30am at Baldwin Park. About 200 girls from our local schools as well as neighboring schools are invited to participate. We are having a professional photographer and DJ. We would like to thank Rockaway Kosher Supermarket for sponsoring drinks, World of Chantilly for sponsoring customized cookies, and Gourmet Glatt for sponsoring the refreshments. Every year, these girls run

together in achdus inspiring each other with singing, dancing and running, and when they cross the finish line, they feel a big sense of accomplishment! Contact BeMatzliach@gmail.com to register.
TCSF was started in our local community, for our local community, eight years ago by two siblings Channa Shira (Ryback) Schik and Shmaryahu Ryback.
Summer camp is an essential part of a child’s social, emotional and spiritual development, and no child should be left out. Unfortunately, not everyone in our community can afford summer camp. This organization is proud to say that they have helped hundreds of children go to camp. The Camp Scholarship Fund has a dual purpose: the children learn the importance of doing chessed with fun activities, and the result of this fun chessed is that children are helping their peers go to camp in the summer. Teaching children this twofold concept has been proven to be very successful!
There are no salaries taken. $700 will help send a child to camp for two weeks; for half a summer, $1,400; and for a full summer, $2,500, however, any size donation is welcome! Zelle: BeMatzliach@ gmail.com.



This past Friday was week one of FM Home Loans 5 Towns Flag Football. We had an excellent, intense, and competitive kickoff week, and we are looking forward to an amazing season!
The Pre-1A division, under the direction of Rabbi Jeremy Fine and Rabbi Aron Flecksher had an excellent day practicing drills for running, catching, and throwing.
In the 1st grade division, the Patriots defeated the Jets with a game winning touchdown by Eytan Neuman. And the Broncos defeated the Giants.
In the 2nd grade division, the Jets defeated the Commanders. The Broncos defeated the Patriots with an all star TDP from Jacob Fox. The Giants defeated the Vikings. And the Eagles defeated the Texans.
In the 3rd and 4th grade division, the Panthers defeated the Broncos. The
Patriots defeated the Steelers with Izzy Korn’s amazing interceptions. The Packers defeated the Jets. The Seahawks defeated the Saints. The Dolphins defeated the Eagles with Yitzy Statfeld’s amazing catching and communication. The Falcons tied with the Raiders. And the Vikings defeated the Giants.

In the 5th and 6th grade division, the Dolphins defeated the Giants. The Raiders defeated the Seahawks with Mikey Pollack’s consistent short plays. The Saints defeated the Falcons. The Broncos defeated the Steelers. The Jets defeated the Packers with 2 amazing touchdowns from Shlomo Davison. And the Patriots tied with the Panthers.
In the 7th and 8th grade division, the Giants tied with the Broncos with excellent interceptions from Tzvi Farbman. The Eagles defeated the Patriots. And the Vikings tied with the Jets with MVP Hudie Chait.
SKA seniors Meira Berkowitz, Aliza Coronel, Batya Kimyagarov and Lea Septimus participated in AIPAC’s 2023 Political Student Leadership Summit held in Washington, D.C., on Sunday, March 19 through Tuesday, March 21.

Together with their faculty advisor Mrs. Tamar Bindiger, the SKA students
had the opportunity to learn more about issues affecting the U.S.-Israel relationship and interact with leading Washington political figures and other Student Leadership Summit attendees. They found the Summit filled with intense political and foreign policy programming and training, which will help them be effective advocates for Israel.



After completing the incredible sefer of Olam HaAvodah, the talmidim of Yeshiva Ateres Eitz Chaim had the opportunity to travel to Newark, NJ and visit the mechaber, Rabbi Moshe Don Kestenbaum, shlit”a. The talmidim enjoyed a shuir on avodas Hashem and heard divrei chizuk in
preparation of the upcoming yom tov of Pesach from Rabbi Kestenbaum. Talmidim also enjoyed engaging in discussion on the topic of emunah, hishtadlus, and other areas of avodas Hashem.
Talmidim then received an inscribed Hebrew edition of sefer Olam HaAvodah from Rabbi Kestenbaum.




Anumber of fun and exciting activities took place at Shulamith to connect the simcha of Adar to Nissan. In honor of Pi Day on March 14, Big Sisters and Little Sisters made ice cream pies and worked together to memorize the number of pi. Congratulations to Adina Romer, Tehila Friedman and Yael Fruchter, and to Libby Kiss, Orly Munk,Yael Stahl, and Zoe Silver on memorizing pi!
Later that week, girls came dressed in jerseys to show their team spirit. The Adar festivities culminated with an Achdut production, performed by Shulamith 6th-8th grade students with songs, dance, art presentations and a skit. The girls were also treated to a recap of all the amazing events and activities that took place at Shulamith over the month of Adar.

HANC’s Early Childhood Center in West Hempstead is bursting with activity as the children prepare to be active participants in their families’ Seders. In addition to learning the story of Pesach, the many brachot that are recited and the songs that are sung during the Seder, the yeladim are utilizing a myriad of modalities and artistic techniques to create ceremonial objects that they will be able to share with their families. From tie-dying colorful matzah covers, decorating washing towels, and creating beautiful Seder plates, the experiential method of learning has permeated all aspects of their Pesach preparation.


As each class learned the Pesach story, the children acted out the scenes using costumes and props. These adorable vignettes were photographed and included in their interactive Haggadot and will serve as a keepsake for their entire lifetime. When they came to the dramatic crossing of the Yam Suf, Morah Kaylie, HANC ECC’s music teacher, created a “model” so that the children could have
a virtual experience of crossing the sea to freedom. Melodies of Pesach songs, including the Ma Nishtana, could be heard all day long in the hallways, as the children dutifully practice so they are prepared to sing at the Seder.
With great anticipation, the yeladim will pack up all of their projects next week and carefully carry them home to present them to their adoring families. Not only will their projects adorn the Seder table, but their singing and recitation of brachot will certainly be a source of joy and pride for all of their families.
Every other year in Yeshiva of South Shore, we have our attention focused on a very critical area of halacha. Last year, we focused on the practical applications of hilchos brachos and our talmidim mastered hundreds of food items and their proper brachos. This type of limud , however, can be found in any Yeshiva. What makes our Yeshiva a “cut above the rest” is a year like this.
Every Rebbe learns the 39 Melachos with his class shortly after Sukkos, taking one melacha a day and generally discussing it with his talmidim so that they are familiar with each and every one of the 39 Avos Melachos .
Over the midwinter break, our famous Chevra Shone Halachos reviews this vitally important limud, and our talmidim undergo a voluntary test on the 39 Melachos when they return. At that point in time, our entire student body, 4th through 8th, delves into the intense learning of the practical applications of Hilchos Shabbos. Grade appropriate alphabetized sheets are distributed every week for three weeks with practical applications that come up almost every Shabbos and they learn if it’s muttar or assur. If it is assur, they will learn to identify from which melacha the issur stems.

On the fourth week, there is a major review and a final exam. All of this is culminated with a school-wide Melachos Bee.
As this cycle of Hilchos Shabbos one year and Hilchos Brachos another year begins in grade 4, when a talmid

graduates our eighth grade, he has gone through these two major areas of halacha twice – once on a basic level and the second time on a more advanced level.
When this idea was introduced, these sheets were checked over and gone through in detail by one of the great Poskim in Lakewood. He was so impressed with it that he felt this should be done in every yeshiva in the country!

It gives the boys a firm understanding of the complicated halachos of Shabbos, which we use every week! Indeed, when this idea was introduced (years ago) to our Rebbes, one rebbe commented, “I didn’t learn this until I was in Beis Medrash. It is so important for our talmidim to understand this.”
One of our graduates was sitting in his high school shiur, and his rebbe was teaching Hilchos Shabbo in the Mishna Berura. His rebbe was so impressed with his commanding understanding of Hilchos Shabbos that he asked him, “Where do you know this from?” To which he proudly responded: “From Yeshiva of South Shore – where else?!”
It was the final week of the JSL season by FM Home Loans, and it ended in thrilling fashion. All participants in the JSL Juniors division received trophies for their incredible play and improvement throughout the season. Basketball played their championship games Sunday night and Hockey played the Semi-Final games on Sunday and the Championship games on Monday. There were some truly wild games, including 3 games being decided in OT. The tension and drama was high, and the boys played incredibly. We would like to thank all our tremendous coaches, staff, and sponsors for an amazing season. The league extends a special thank you to our MVP Sponsors Island Roofing, Five Towns Orthodontics, & Town Appliance, and our Premium Sponsor Maidenbaum Tax Reduction, and of course, our amazing league sponsor FM Home Loans. Looking forward to more great hockey and basketball next Fall.
The boys’ skills are greatly improving under the guidance of our amazing JSL coaches. K/P Hockey: The game between Arg and Simcha Day Camp was a nail-biter. Arg managed to tie it up with just one minute left, forcing the game into overtime. Despite both teams’ efforts, neither could score, resulting in a thrilling 4-4 tie. Alpert Financial and Hewlett Auto Body battled it out in a game that saw the lead change hands multiple times. In a last-second effort, Ari Davidowitz of Hewlett Auto Body scored to tie the game, sending it into overtime. Alpert Financial managed to come out on top, winning 4-3. Meanwhile, Home and Stone had an impressive victory, with Daniel Hammer scoring all
five goals and goalie Zack Pearlman delivering excellent goaltending.
K/P Soccer: Arg emerged victorious against Future Care Consultants, thanks to Elimelech Yakomov’s impressive hat trick.
1st Hockey: In 1st Hockey, Island Roofing had a strong start, leading Arg 2-0. However, Arg managed to fight back and score a goal, only for Island Roofing to respond immediately, keeping their two-goal lead. Island Roofing held on for a thrilling 5-3 win in the championship game. Charlie Rosenblatt scored the most goals, and Akiva Greenspan delivered excellent defense.
3rd/4th: Built by Nate dominated against Island Roofing, with Judah Hess, Noam Rosman, and Aaron Levitin putting on an impressive offensive performance as they went on to win the 3rd/4th grade championship. Town Appliance secured third place in the consolation game. 5th-7th Basketball: The 5th-7th Basketball championship game saw Five Towns Orthodontics defeat Maidenbaum, thanks to Lior Benhayun and Shane Obadiah’s excellent performances. In the third place game, Aryeh Rosenzweig’s acrobatic spin and layup helped Wieder Orthodontics secure a 29-24 win against Extreme Vent Cleaning.
2nd/3rd: In 2nd/3rd Hockey, the #6 seed MoldPro pulled off a stunning upset against the undefeated #1 seed Meat + Board. MoldPro jumped out to an early 2-0 lead, but Meat + Board managed to claw their way back into the game, eventually tying it and sending it into a shootout. MoldPro scored two in the shootout, giving them the improbable victory and a shot at the championship.
Ton Polanski delivered an incredible performance in net for MoldPro. Meanwhile, JNT defeated Elegant Lawns 3-1 in a close defensive battle to secure their spot in the championship game.
4th/5th Hockey: The 4th/5th Hockey games were full of excitement, with Town Appliance managing to secure a last-minute win against AutoClick and a chance for the championship trophy Monday night. In a high-scoring game, 925 Sterling took an early lead against Five Towns Orthodontics, but Gavriel Abittan’s impressive hat trick helped Five Towns Orthodontics to eventually tie the game and force it into a shootout. However, 925 Sterling came out on top, winning 9-8 in OT, as they’ll face Town Appliance in the Championship Game on Monday night.
6th/8th Hockey: In 6th/8th Hockey, BayRock Insurance secured an impressive 9-3 win against Wieder Orthodontics, with Tzvi Maltz scoring an impressive five goals and Yaakov Kopolwetz delivering a hat trick. Meanwhile, MoldPro was no match for JNT, with JNT’s powerful offense scoring four goals in the second period and adding even more in the third, ultimately winning 8-1. JNT will face off against BayRock Insurance

in the championship game in what is sure to be great game
Men’s Basketball
It was Game 3 of the men’s season Sunday night. Island Roofing exploded offensively, scoring 82 points in their win vs SBS Energy. Yoni Bobker rained down multiple 3s in the 2nd half. Zev Teitlebaum had a monster 2nd half with three 3s as Alpert Financial dominated all game in their win against KolSave. David Ivry was on fire Sunday night, scoring 30 points in Stone Group’s win over Home & Stone.
Pinny Weinstein, Rudy Rosenzweig, Charlie Rosenblatt, David Gerson, Eli Oratz, Ezra Rosman, Yehuda Fricker, Max Edery, Aaron Resnick, Aaron Levitin, Eli Levovitz, Zachary Obadiah, Yaakov Levine, Avi Drandoff, Yoni Schaffran, Yaakov Kopelowitz, Moshe Sherman, Dov Wolff, P. Eisenberger, Joshua Gerson, Shlomo Greenspan, Netanel Kirschner, Gavriel Levine, Chezjel Jeidel,






The Ezra Legal Eagle Society was established 23 years ago. Its goal was to promote legal education in the high school classroom. In its inception, the program required that students take at least four law-related classes and participate in at least one NYS Bar Association recognized extra-curricular activity.
The concept remains the same, but the choices of classes and activities have grown tremendously. Students are invited to choose from classes including (but not limited to) business law, constitutional law, criminal justice, contemporary issues in law, honors legal seminar, comparative law, argumentation and public speaking. Many of these classes are taught in our very own courtroom, donated by Ezra Alum of 2007. Additionally, the activity list has grown exponentially over the years as well. From the NYS High School Mock Trial Competition, the Legal Eagle Society now invites students to participate in numerous other competitions including (but not
limited to) the High School Moot Court Competitions run by Princeton, Duke University and Denver University, the PATCH Program Civil Moot Court Tournament, Model Congress, Model UN, Debate, Extemporaneous Speaking and Forensic Science. Society members are led by student co-presidents who help organize and facilitate participation on teams. The student leadership includes the presidents as well as captains of each team and other committees that work to encourage academic growth and team success. This year for example, the mock trial team placed into the Sweet Sixteen
in NYC, losing just before advancement to round 5; a tremendous result in the NYS State competition. Our debate team won several awards just this week at a debate hosted by YUHSG.

In addition to all of these classes and programs, it is noteworthy that the legal studies program has become one of the major choices in the majors program at Ezra Academy. All students choose a major before 10th grade and follow a pathway to completion as they finish high school. (The other majors include business, STEM, and Pre-Health.) Now that Ezra has partnered with PCC, students
can actually graduate from Ezra Academy having completed more than half of the college credits needed to graduate with a bachelors. This creates a conduit to early admission to law school (among other opportunities). Finally, as a culmination of the legal studies program, seniors are invited to intern in law offices of Ezra graduates who are currently practicing law. The program has grown and blossomed with time. Ezra is tremendously proud of all the lawyers who began their careers in this program and those who are taking that journey now.
Rabbi David Ashear, author of the Living Emunah series, brings his unforgettable emunah insights and stories to one of the most important – and often most stressful – parts of our lives: finding a shidduch for our children or for ourselves.
How can we stay calm and tranquil when the wait to find a shidduch for ourselves or our loved ones sometimes seems almost endless? How should a person react in the face of disappointment? With sensitivity, compassion, and – of course! – emunah , Rabbi Ashear’s brand new Living Emunah on Shidduchim offers Torah insights and powerful stories to guide us through the parashah of shidduchim.
With more than 300,000 copies in print, the Living Emunah series has touched so many lives. In Living Emunah on Shidduchim , Rabbi Ashear shows us how everyone involved in the world of shidduchim – parents, friends, shadchanim , and, of course, those waiting for their basherts – can turn a challenging and tense time into a vehicle for growth, tranquility, and ever-strengthening emunah .

The following is an excerpt from the book, a small glimpse into the penetrating inspiration that comprises this must-have volume.
Yaffa* mentioned to her friend that she didn’t have a housekeeper for a couple of days. “I sent her to my neighbor, who is recovering from minor surgery.”
“Aren’t you worried about letting her go to someone else’s house?” asked her friend. “That’s how they end up leaving.”
Yaffa replied, “I know that Hashem decides how long my housekeeper is going to stay with me, and He’s not going to shorten that time because I am helping someone. It’s just the opposite. We only gain from doing chessed .”
Yaffa told me afterward that she felt very proud of being able to feel this way after many years of reading and listening to classes on emunah . “There is no way I would have felt like this a few years ago,” she admitted, “but baruch Hashem , my life has changed due to the
emunah I have learned.”
We never lose by doing chessed . We only gain. Sometimes, people struggle when it comes to doing chessed , especially when a great deal of effort is required. Reminding themselves that helping others will only benefit them will help overcome their reluctance.
Shortly before their daughter Devorah’s scheduled wedding date, Mr. and Mrs. Scheiner were notified by the manager of the hall that due to Covid restrictions, all weddings were being canceled. The couple and their families were very distraught. What to do now?
Mr. Scheiner heard from a friend about the Roths, a wealthy couple who had a very large home and backyard. “Maybe they would agree to host the wedding?” the friend wondered.
Devorah’s father overcame his natural shyness, went to the Roths’ home, and rang their bell. When Mr. Roth opened the door, Mr. Scheiner explained the situation. Then, swallowing hard, he said, “I know we are complete strangers. But is there any possibility you would consider opening your home and hosting my daughter’s wedding?”
Taken aback, Mr. Roth said he would need to discuss it with his wife first.
When he brought it up with her later, her response was immediate and unequivocal.
“Absolutely not!”
Although he understood his wife’s reluctance, he really wanted to do this chessed.
“Shmuli* has been going through a very hard time since his divorce,” he said. “Let’s do this chessed as a zechus for our son.”
When Mrs. Roth heard those words, she changed her tune. “All right. For Shmuli’s sake I’m willing to do it.”
They immediately contacted the Scheiners and told them it would be their pleasure to host the wedding.
“In fact,” they added, “we would be honored to pay for it as well.”
Near tears, Mr. Scheiner thanked them profusely and told the couple that the wedding was on.
The Roths hired a party planner to coordinate the wedding, and it was a
beautiful celebration.
After the guests left, the party planner remained behind to clean up. “This was not part of our agreement,” the Roths pointed out. “Why are you going beyond the call of duty?”
“I am divorced,” she said. “I decided to do this wedding free of charge as a zechus for myself to get remarried. I know it’s hard for couples to get married these days with all the Covid restrictions in place. I decided to help another couple, and hopefully, in that zechus, Hashem will help me get married, too.”
“Oh, yes, we certainly understand,” said Mrs. Roth. “We hosted this wedding as a chessed in the zechus of our son, who is also divorced.”

A few months later, Mr. and Mrs. Roth had the pleasure of hosting another wedding, when their son Shmuli married the party planner! Their wedding was celebrated in the very same location, a place that was
infused with chessed. We never lose by helping others. Just the opposite is true. We always gain.
This week’s biannual Career Exploration Day provided a fantastic opportunity for Shulamith High School students to discover new horizons. Setting aside their busy schedules, nearly 40 professionals dedicated their time and talents to present their fields to the juniors and seniors, showcasing a wide range of professions within each category.
The program opened with a keynote address by Mr. Nachum Schoenfeld, father of senior Rebecca. He spoke of the myriad directions one can take towards finding a suitable profession and instructed the girls about some helpful steps to open the door to a career path of choice. The program continued with the Career Fair, where parent and volunteer participants explained their jobs and answered questions from individual students, followed by two small, in-depth panel discussions, based on students’ interests in particular fields. Conversations covered the strengths, aptitudes, and personality traits utilized in certain occupations, the winding paths sometimes
taken to get there, and the divergent opportunities available within any given career choice. Students were encouraged to explore multiple fields and to search outside of their usual interests.



SHS is so grateful to the volunteers who gave up their morning to attend and contribute so richly to our students’ real-world educational experiences. Thank you for offering invaluable information and advice and allowing our girls to think beyond the scope of their high school careers.




More than 100 students from 24 colleges in New York and New Jersey gathered at Touro’s Lander College for Women/The Anna Ruth and Mark Hasten School (LCW) last month for the college’s annual all female Hackathon. Over the course of 12 hours, the students collaborated with teammates in a competition to solve real-world problems faced by companies and organizations of all sizes by utilizing coding and creative programming skills.
Teams of three-to-five students sat at tables inside the gymnasium and developed unique methods to find the best solution to one of two challenges provided by the Hackathon organizers.
When she addressed the exhausted but smiling participants late in the day, Dr. Marian Stoltz-Loike, dean of Touro’s Lander College for Women and VP for Online Education at Touro University, underscored how effectively the women collaborated at the Hackathon.
“It comes naturally to us, the idea of being a team, and joining together with people who we’ve never met before and creating something amazing. That’s what you’ve all done today,” she said.
The students worked throughout the day, with breaks built in, during which several dynamic women who have succeeded in the tech world—including keynote speaker Shira Rubinoff, a cybersecurity executive—shared opportunities and challenges the participants may encounter if they pursue careers in the
Did you know?

technology sector. Mentors were available to offer guidance to individuals and teams, and projects were presented to the judges in the evening. The organizers also built in dedicated times for students to network with the various speakers, judges, and mentors.
Organizer Chana Chambre, who won the 2019 Hackathon with Rina Glasser while they were both in high school, said that the Hackathon is useful to students interested in a career in computer science, “where there isn’t really a guidebook or a manual or one way to do it.”
“It’s not like, medicine, where you have a very set path. It’s sort of do it yourself,” Chambre said. “And I like being able to help people, tell them what worked for me, and let them see what works for them, because that’s how you figure out your own niche in the field.”
Glasser, who will graduate in May with a degree in Judaic Studies and is minoring in Computer Science, noted the constant hum of activity in the gymnasium during the 12-hour day.
“Everyone was working hard, everyone was coding, and when you walked around, everyone’s laptops were open,” she said.
A team from the Stevens Institute of Technology won first place in the competition. The main sponsors of the event were Fabuwood and 400 Capital Management. Fabuwood also provided one of the two Hackathon challenges which was won by a team of Touro students.
It takes 400 cocoa beans to make one pound of chocolate.


Rabbi Daniel Glatstein, rav and founder of Machon Maggid Harakiah in Cedarhurst, NY, is one of the contemporary Jewish world’s most popular speakers and respected maggidei shiur. In the just-released Rav Daniel Glatstein on the Haggadah, published by ArtScroll/ Mesorah, he treats the Haggadah text not as a series of unconnected “vertlach,” but as a living, unified document, mirroring the slavery, miracles, and ultimate liberation in its words and structure.
Rav Daniel Glatstein on the Haggadah features comprehensive analyses on rarely-before tackled subjects such as, “Who Wrote the Haggadah?”, “What Is The Structure of The Haggadah?”, “How Many Words In the Haggadah?” and many other basic issues that give us a deeper understanding of our beloved Haggadah, and, indeed, of the entire experience of Yetziyas Mitzrayim.

The following is an excerpt, providing a glimpse into this uplifting, fascinating Haggadah.
The Gemara teaches that there are four people who are obligated to show gratitude to Hashem by bringing a korban todah: one who crosses a sea, one who traverses a desert, one who recovers from an illness, and one who is released from captivity. The Maharsha writes that when Klal Yisrael were redeemed from Mitzrayim, we experienced all four of these forms of salvation. This is alluded to when the Torah uses four distinct expressions of geulah, redemption: V’hotzeisi, v’hitzalti, v’ga’alti, v’lakachti. Each represents a different miracle for which hoda’ah must be expressed.
The Vilna Gaon and the Sefer HaMichtam explain that the four cups of wine that symbolize these four expressions of salvation are, by extension, also expressions of gratitude to Hashem.
The matzah, too, is fundamentally a means whereby to convey gratitude to Hashem. The Rosh brings the custom of Germany and France to make the three matzos of the Seder from one
isaron of flour, which is the quantity of flour used to make every three loaves of the korban todah. Thus, the matzos, too, are a form of a thanksgiving offering to Hashem.
We can now more fully appreciate one of the most fundamental objectives of the Pesach Seder. An integral part of our avodah at the Seder is to express hakaras hatov, gratitude and appreciation to the Ribbono Shel Olam for the miracles and incredible kindnesses He showered upon us when He redeemed us from slavery. As we recite the Haggadah, and especially as we read the parashah of Bikkurim, we must express sincere and heartfelt hakaras hatov to the Borei Olam for His infinite kindness and mercy.
Thus, we come to a novel interpretation and understanding of the mitzvah of Haggadah. When discussing the mitzvah of bikkurim, the Torah instructs:
You shall come to whoever will be the Kohen in those days, and you shall say to hint, “I declare – higaditi – today to Hashem, your G-d, that I have come to the Land that Hashem swore to our forefather to give us” (Devarim 26:3).
The mitzvah of Bikkurim itself includes the use of the term “Haggadah” – higaditi ha’yom.
Targum Yonasan ben Uziel explains:
And you shall put crowns upon the baskets, hampers, and woven cases, and bring them to the priest appointed to be the chief priest in those days, and shall say to him: We are grateful this day before Hashem, your G-d, that we have come into the Land that the Lord swore unto our fathers to give us.
The Targum Yerushalmi similarly translates higaditi הגּדְתּי as thanks and praise. The term higadati is not defined as a declaration or statement. Rather, it means gratitude and thanks.
Amazingly, the Avudraham comments that this is the very meaning of the word “Haggadah” on Pesach. Thus, the objective of the Seder is not merely to relate events of the past and discuss the power and might of the Ribbono Shel Olam. It is to express our heartfelt gratitude to Hashem for all He did for us as He redeemed us from Mitzrayim.
B’siyata d’Shmaya, we are now equipped to suggest an answer to a question raised by Rav Chaim Brisker. There is the mitzvah of Zechiras Yetzias Mitzrayim
that a Jew is obligated to perform every day of the year. What is different about the mitzvah of Sippur Yetzias Mitzrayim with which we are charged on the night of Pesach?
Based on the above, the answer is clear. There is a daily obligation to recall and mention the events of Yetzias Mitzrayim. Seder night is different. In addition to merely mentioning these seminal events, we are required to express gratitude and thanks to Hashem for the miracles He performed on our behalf. While the daily chiyuv is to discuss and recall, leil haSeder incorporates the element of hoda’ah that is not included in the mitzvah during the rest of the year.
As the Avudraham teaches, this is not an aspect of the Haggadah; it is its very definition.
Perhaps we can further suggest that this fundamental difference is actually the foundation and basis for the three differences that Rav Chaim highlights between the daily mitzvah of Zechirah and the annual mitzvah of Sippur. The reason we are maschil b’genus umesayeim b’shvach is because when we present our history in this manner, we engender greater feelings of gratitude. We follow a question-and-answer format at the Seder, and we mention the reasons behind pesach, matzah, and maror for the same purpose. The structure of the entire evening revolves around our need to feel and express hakaras hatov to the Ribbono Shel Olam in the fullest, most extensive way.
Thus, the underlying objective of Sippur Yetzias Mitzrayim, the mitzvos of the night, the four cups of wine, and the achilas matzoh, are all to be able to wholeheartedly fulfill the mitzvah of v’higadeta levincha, which is to say to Hashem: Thank You!


Over the last few months, yeshivas have come under fire in New York City with allegations that these Orthodox Jewish private schools fail to provide sufficient secular education. Some have called for increased regulation of these institutions. The criticism overlooks the valuable role yeshivas palay in our communities. It is too easy to allow a generalization or misperception to define an entire community, and those falsehoods malign an entire people.
The fact is, yeshiva students spend many more hours in the classroom than traditional students, and much of that time is spent on a curriculum focused on critical thinking and analytical skills, skills that are not emphasized in traditional public schools. The longer school day starts when these students are in elementary school, and that training provides a foundation to help them excel as adults in a wide variety of professions. In addition to the critical and analytical thinking, yeshivas also emphasize ethical and moral development, and that is central to their cultural teachings. Taken as a whole, yeshivas instill grit and determination, as well as core values in students, rarely seen in any other type of education system.
Critics are quick to point out that even though yeshivas are private schools, they receive government funding. What you may not know is that yeshivas are saving New York taxpayers money. The Orthodox families who send their children to yeshivas are largely self-funding the education system to the tune of $2 billion a year. And while yeshivas receive some public funding, most of that money is spent on legally mandated services required by the federal government, from student transportation to school lunch. Despite these mandated services, some
are still calling for state regulators to intervene and provide more oversight. Some claim that yeshivas should be forced to “show their work” and detail how they provide minimum standards of secular education to their students. If

Education and Board of Regents should work with yeshivas to provide the necessary resources for supplemental instruction. This is especially important for some yeshivas where English may be a second language to Yiddish. Similar
The goal of all schools — traditional public, charter, Catholic, Hellenic, yeshivas, and alternatives — is to provide students with a high-quality education. It is in the best interest for all that future generations be as educated as possible. We must always be vigilant to work collaboratively to ensure students — regardless of their background or religion — receive a pedagogically sound education. It is critical to acknowledge that yeshivas play an invaluable role in their communities regardless of an outsider’s perspective.
It goes without saying that generalizations and attacks in the press against one group of people and their schools places a target on that community by the politics of contempt. We have already seen the hatred in some people’s hearts and how that is weaponized against the innocent. At this moment, it is critical to foster a discourse of inclusion, understanding, and empathy; anything less is a cunning disguise inviting public hostility.
It’s important for the public and my colleagues in government to recognize the valuable role yeshivas play in their communities. We must collaborate to ensure all students receive a high-quality education. If there are educational needs and gaps in education — whether around language or anything else — then government must do its part to ensure those places of learning have the resources necessary for students to be successful.
there is a need to involve the state, then do so, but also provide those places of learning the same opportunities as the entire state’s population of students. For instance, when substantial equivalence is questioned, the state Department of
support is given in public schools, where a large segment of the student population may also be English language learners; the only difference is the language being spoken, so aren’t all students entitled to those resources?
Assemblymember David Weprin represents the 24th Assembly District in Queens, NY, which includes parts or the entirety of Jamaica Estates, Jamaica Hill, Hillcrest, Hollis Woods, Hollis Hills, Richmond Hill, and Briarwood. Assemblymember Weprin is Co-President of the National Association of Jewish Legislators and is a leading voice in New York for Jewish issues.
Taken as a whole, yeshivas instill grit and determination, as well as core values in students, rarely seen in any other type of education system.

$ A bank is a place that will lend you money if you can prove that you don’t need it.– Bob
Hope$ Bank failures are caused by depositors who don’t deposit enough money to cover losses due to mismanagement. – Dan

 Quayle
Quayle
$ Banks are an almost irresistible attraction for that element of our society which seeks unearned money. – J.
 Edgar Hoover
Edgar Hoover
$ I believe that banking institutions are more dangerous to our liberties than standing armies. – Thomas
Jefferson$ Banks are nothing but old-fashioned money lenders. They encourage you to borrow, to get in debt, and when you can’t pay back the loan, they take your home away. At least a money lender only breaks your legs. -
Karl WigginsJim, Bob and Sam were arrested and brought to the police station because one of them was suspected of having robbed the local bank.
The three suspects made the following statements: Jim: I’m innocent.
$
A banker is a fellow who lends his umbrella when the sun is shining and wants it back the minute it begins to rain. – Mark Twain
$ There are two things that can disrupt business in this country. One is war, and the other is a meeting of the Federal Reserve Bank. – Will Rogers
$ Banking is very good business if you don’t do anything dumb. –
Warren Buffett$ Drive-in banks were established so most of the cars today could see their real owners. – E. Joseph Cossman

$
I saw a bank that said “24 Hour Banking,” but I don’t have that much time. - Steven Wright
Bob: I’m innocent.
Sam: Bob is the guilty one.
If only one of the statements turned out to be true, who robbed the bank?
Answer: Jim
There are really only 2 genders…I mean types:
Type 1
1. Pull up to ATM
2. Insert card
3. Enter PIN
4. Take cash, card, and receipt
5. Drive away
Type 2
1. Pull up to ATM
2. Back up and pull forward to get closer
3. Shut off engine
4. Put keys in purse
5. Get out of car because you’re too far from machine
6. Hunt for card in purse
7. Insert card
8. Hunt in purse for grocery receipt with PIN written on it
9. Enter PIN
10. Study instructions
11. Hit “cancel”
12. Re-enter correct PIN
13. Check balance
14. Look for envelope
15. Look in purse for pen
16. Make out deposit slip
17. Endorse checks
18. Make deposit
19. Study instructions
20. Make cash withdrawal


21. Get in car
22. Check makeup
23. Look for keys
24. Start car
25. Check makeup
26. Start pulling away
27. Stop
28. Back up to machine
29. Get out of car
30. Take card and receipt
31. Get back in car
32. Put card in wallet
33. Put receipt in checkbook
34. Enter deposits and withdrawals in checkbook

35. Clear area in purse for wallet and checkbook
36. Check makeup
37. Put car in reverse
38. Put car in drive
39. Drive away from machine
40. Drive 3 miles
41. Release parking brake
A guy walks into the bank, pulls out a gun, points it at the teller and screams, “Give me all your money or you’re geography!”
The teller replies, “Don’t you mean history?”
The robber says, “Don’t change the subject!”

With the beginning of the reading of the Book of Vayikra this Shabbat in the synagogue, the title of the book itself calls out to us for understanding what is meant when the Torah tells us that G-d called out to Moshe. Moshe experiences a special and unique method of G-dly revelation. The Torah testifies to this by describing that G-d, so to speak, talks to Moshe “face to face.”
The prophets of Israel receive G-dly communication while in a dreamlike trance. But the thrust of Jewish tradition is that even though there is no longer any type of G-dly prophecy present in our world, G-d still communicates with hu-

mans, but He does so in very subtle means – in reflections of human behavior and world events themselves. Free will allows humans to behave as they will, yet there is a guiding heavenly hand in world affairs visible to those who wish to see it.
A few decades ago, two scientists won a Nobel Prize for proving their ability to yet hear the echo of the sounds of the original “birth” of the universe at the moment of its creation. We all know that human hearing is possible only within a limited range of wave frequencies. Judaism preaches that good deeds, moral behavior, Torah observance, and loyalty to traditional Jewish values help expand our hearing ability –
and this enables us to tune into heavenly sound frequencies which were originally blocked to us.
The auxiliary message of Vayikra, when G-d called out to Moshe, is that Moshe’s hearing is so perfectly attuned to heavenly communication, he is always “face to face” with his Creator. That is the true indication of the greatness of Moshe and makes him the most unique of all the world’s prophets, teachers, and leaders.
improve in our everyday lives.

The Bible teaches us that Shimshon began his career as the savior and Judge of Israel when he was able to hear the spirit of the L-rd beating within his heart. In our busy and noisy lives, with so much incessant sound exploding all around us constantly, we really have little time or ability to listen to our true selves – those small voices that are always speaking to us. Our inner voice is the medium that Judaism
The word “vayikra,” as written in the Torah, contains a miniature letter “aleph.” This indicates to us that G-d’s message to us is subtle, quiet, and easy to ignore temporarily but persistent and ongoing. As the L-rd told the Prophet Elijah, “I do not appear in the great wind or in earthquakes or other terrifying natural phenomena, but rather in a small, still voice.” Listening to a still, small voice requires good hearing acumen and intense concentration. Casual hearing will not suffice.
In our times, the small aleph requires us to really listen and pay attention to what transpires in our personal and national lives. Oftentimes, we, like the Prophet Yonah, attempt to flee from the still, small voice that continually echoes within us. But it remains persistent and waits patiently for our hearing ability to
uses to teach us that the L-rd calls out for our attention, to give us moral and courageous guidance. But it can only be of value if we listen – and that requires concentration, thought, and commitment.
A great sage once remarked that when a Jew prays to G-d, he or she is talking to G-d. But, when a Jew studies Torah, then G-d, so to speak, is talking to him or her. That is one of the reasons that Judaism places such a great emphasis on Torah study. As the Talmud says:
“The study of Torah outweighs all other commandments.” It is the proven method for attuning to the spiritual frequencies that beat within us. Our Creator constantly calls out to us, and we have to make every effort to improve our hearing and our listening.
Shabbat shalom.
In our times, the small aleph requires us to really listen and pay attention to what transpires in our personal and national lives.


Regarding the mitzvos the Seder, the Maharil explains (Seder Hahagada 4) as follows: “We see that the mitzvos of the Seder are so precious from the fact that the Torah is more scrupulous [regarding the involvement of] the children on this night [than with regard to any other type of mitzvos], as it says, ‘And you shall tell your son...’” We must understand why this is. Rav Elchonon Wasserman, zt”l, quoted in the name of the Vilna Gaon that, altogether, we fulfill sixty-four mitzvos, both rabbinic and Torah-based, on Seder night. In connection with the voluminous number of mitzvos on Pesach, one of the great Mussar masters admitted to wondering why, on the night we celebrate our freedom, we are weighed down with so many mitzvos. We feel like we have returned to slavery! What is the connection between our focus on the children and the tremendous number of mitzvos when we celebrate our liberation from slavery?
Rav Yerucham Levovitz, zt”l, teaches (Bais Chochma U’mussar, Vol. 1, Maamarim 38-43) that the main idea of Pesach is not the freedom to do whatever we want. Rather, the main idea of the exodus from Egypt is that it gave us the freedom to be servants of Hashem. We want to internalize this awareness even in our physical bodies. However, in order to bring our bodies into the service of Hashem, we must use language that our bodies understand. The physical body does not understand wisdom or philosophy. It does not comprehend intellectual experiences like reliving the Exodus. Rather, the way to reach the body is through physical acts. As the pasuk (Devarim 29:8) says, “And you shall do them.” Because the Hebrew word for “them, osum,” is spelled without the letter vav, the Gemara (Sanhedrin 91b) explains that the pasuk could homiletically be translated as “and you shall make you,” so that when one does the mitzvos
Adaptedfor publication by
Binyomin WolfYisroel or because their family dynamics simply give them no choice, they do their children and themselves a profound disservice by running away from the mitzvos of preparing for Pesach. By fleeing to a hotel for the duration of the holiday, children see that their parents are servants of their own bodies’ desires, and not servants of Hashem, and they similarly learn to identify themselves in the same way.
with his physical body, “it is as if he creates himself.”
The only way we can fulfill the purpose of leaving Egypt is by physically doing all of the mitzvos of the Pesach and the Seder. When we cook and clean for Pesach, eat the matzah and the Pesach offering, and drink the four cups of wine, we enter Hashem’s servitude. That is why the Haggada says, “Even if we were all wise, all men of understanding, and we all knew the Torah, it would still be incumbent upon us to recount the exodus from Egypt.” We must use our physical mouths to retell the story. Our whole body gets involved in the mitzvos of Pesach and the Seder. While we must certainly also focus on the deeper things we can attain through the Seder like greater faith in Hashem’s existence and continued providence, the main point is to physically do the mitzvos in order to bring ourselves into Hashem’s service. That is how we go from slaves of Pharaoh to being Hashem’s slaves.

There is a beautiful Midrash (Yalkut Shimoni, Tehilim 113, Siman 872) which makes this point clearly:
[At the time of the Plague of the Firstborn, Moshe and Aharon said to Pharaoh,] “If you want this plague to end say, ‘Behold
you are free people. Behold you are in your own domain. Behold you are slaves of the Holy One, blessed is He.’” Pharaoh then began to scream, “You used to be my slaves. Behold you are now free people. You are now only slaves of the Holy One, blessed is He. You must praise Hashem because you are his servants.” As it says (Tehilim 113:1), “Praise G-d! Praise, oh servants of Hashem,” and as it says (Vayikra 25:55), “Because the Jewish people are my servants.”
Now we understand why on the Seder night we have more mitzvos than at any other time of the year. We can be like those who left Egypt by entering the service of Hashem and doing all of the sixty-four mitzvos of the Seder. Going from being slaves to Pharoh to slaves of Hashem is like creating ourselves as exalted servants who faithfully carry out the will of the Creator (see also Maharal, Gevuros Hashem 52).
Now we can understand why the Maharil says that the Torah is particularly concerned that we involve children in the Seder. We must allow our children to observe how we define our essential nature as servants of Hashem by doing His will so that they will learn to define themselves that way as well. When people go to Pesach hotels for reasons other than going to Eretz
The Sfas Emes (Pesach 5663) writes that the pasuk (Tehilim 113:1) says, “Praise G-d! Praise, oh servants of Hashem,” demonstrates that there is a connection between being a servant of Hashem and joyful praise. The connection exists because all types of servitude of this world result in sadness and depression except for the servitude of Hashem, which brings a person to happiness and joy. In the world at large, growing up means throwing off the shackles of one’s parents and teachers in order to do whatever he or she wants. That is why the celebrations they associate with coming of age like proms and graduation parties demonstrate that ethos of personal independence. In contrast, by connecting ourselves to the infinite greatness of Hashem by submitting to His will, we demonstrate to our children that the greatest joy in life is not enslaving ourselves to our own desires. Such desires ultimately become merciless tyrants over us. Rather, the key to happiness in life is taming our personal physical desires by submitting our own will to the will of the Master of the world. May we merit to see the full revelation of Hashem’s kingship and mastery over the world with the coming of Moshiach soon in our times.

True events and several recent passages in Nazir inspire the following story.
Boruch Cohen and Shimon Levi board a plane together somewhere in the United States. They discover their seats are next to each other with a third traveler occupying the remaining seat in the row.
Boruch to the third traveler: Hi! So nice to meet you. I’m Boruch Cohen.
Third traveler: Hi! I’m Steve Fygoda. I’m sorry if my knapsack took up all the space in the overhead bin. I’m a skydiving instructor and that’s my parachute.
Boruch to Steve: Wow! That’s really neat. I don’t think I’ll ever go skydiving in my entire life.
Steve: Don’t dismiss the idea. You may actually do it one day. One never knows when one may have to jump out of a plane. (Steve chuckles to himself.)
The plane takes off and Boruch and Shimon strike up a conversation.
Shimon: Are you a real Cohen or is that a convenient last name?
Boruch: Real Cohen here!
Shimon: That’s interesting. I’ve always wondered how Kohanim take commercial flights. Aren’t you worried you might fly
over a cemetery? Kohanim aren’t allowed to become tamei meis and jump over a grave because of tumas ohel. The tumah projects from the grave upwards even if no contact is made.
Boruch: Well, since the plane flies really fast over the cemetery, the tumah won’t be able to catch me!
Shimon: Yes, someone did actually suggest that theory, but it was virtually rejected by all poskim.
Boruch: Well, according to the Ravaad, Kohanim may become tamei meis nowadays since we are all already tamei meis.
Shimon: Yes, the Ravaad may hold that way. But we don’t follow his opinion. Moreover, some say the Ravaad did not actually mean that a Kohen may initially defile himself, just that if he did, he would not be subject to punishment when a Jewish court system was active.
Boruch: Well, I don’t have to worry about a goyish cemetery. A goyish meis doesn’t transmit tumah.
Shimon: That is mostly a myth. Goyim do transmit tumah, but only via direct contact or by carrying even indirectly.
Boruch: Why do you say mostly?
Shimon: There is the lone opinion of
the Yireim that, in fact, a goyish meis does not transmit tumah at all. Nevertheless, at least according to the Shulchan Aruch, you are correct about not being concerned about a non-Jewish cemetery. The Shulchan Aruch rules that non-Jews do not transmit tumah via ohel. Therefore, a kohein may travel above a non-Jewish grave. Still, the Rema rules that a Kohen should preferably be machmir that goyim do transmit tumah via ohel, therefore a Kohen should not be in the same room/ structure as a non-Jewish meis. Likewise, a Kohen would not be allowed to jump over a non-Jewish grave.
Boruch: At least I’m okay according to the Shulchan Aruch.
Shimon: Still, maybe this flight will fly over a Jewish cemetery?

Boruch: What are the odds of that? In Torah law, we follow the majority. The majority of the land below is not cemeteries, and certainly not Jewish cemeteries.
Shimon: That is a persuasive argument but not conclusive. Some suggest that we only follow the majority when what is being discussed is not in its permanent place. We can discuss a piece of meat found outside many butcher shops.
But the Jewish graves are permanently in their place and can’t be ignored using the concept of rov/majority. This is the concept of kavua, which if applicable would tell us to treat this question as a 50-50 safek. But this topic is really beyond the scope of this conversation.
Boruch: Well, fortunately, I recently learned the daf. I know that I am protected from tumah of a grave because this plane is itself an ohel and is similar to the large box discussed in the Gemara that protects a person from the tumah beneath it. Therefore, even if we fly over a grave, I will not be violating any halacha.
Shimon: I’m surprised at you! You say that you learned the daf and yet you don’t realize the potential fallacy of your argument. The Gemara says that there is a machlokes whether or not a moving box/ ohel can protect a person from tumah. The plane is moving, and according to Rebbe Yehuda HaNasi it cannot shield a person from a grave below. This is similar to a box being carried by an animal that may not protect the person inside it from tumah below.
Boruch: I recalled that, but I wasn’t sure whose opinion we follow.

Shimon: The Rambam and most Rishonim are of the opinion that a moving ohel/box cannot protect a person from a grave below it.
Boruch: Yet you admit that some Rishonim disagree. The Rashba, perhaps? Moreover, I distinctly recall an opinion that a moving box is only not a valid separation according to Rabbinic law. According to Torah law, it is. So therefore, I would argue that the plane is its own ohel and protects me from any grave. Even if one disagrees because it’s moving, the problem is only rabbinic. Lastly, at best, it’s a doubt if the plane will travel over a grave, and therefore we can say safek d’rabbanan l’kula! This logic can be combined with the Ravaad mentioned earlier that we are all tamei meis and not enjoined from becoming tamei. (And I’ll throw in Safek Tumah Brishus HaRabbim but that is beyond the scope of this conversation…)
Shimon: Your argument is very convincing. However, one could argue that your whole premise is based on a mistake. The Gemara was referring to a box made out of wood which can protect the occupant from tumah. The plane is made out of metal. Not only does the plane not protect the occupant, but it itself contracts tumah and becomes a source of tumah!
Boruch: Yes, but this plane is not made of iron. It is made out of aluminum. I learned in the Igros Moshe that non-disposable utensils made out of aluminum only require tevilah rabbinically. That is because the Torah doesn’t mention aluminum as one of the metals that require tevilah. Likewise, one can argue that aluminum is not a metal capable of contracting tumah because it is not on the list of metals in the Torah!
the runway we will be using.
Boruch: Wow! In that case, I need to call my Rav, HaRav Dovid Feinstein [this conversation took place while Rav Dovid, zt”l, was alive] for a psak.
Boruch uses his credit card to pay for a call on the plane. He reaches his Rav.
Shimon: Nu, what did Rav Dovid pasken?
Boruch: Rav Dovid ruled that it is forbidden for a Kohen to knowingly fly over
will cost $10,000 including the use of the parachute. As per the psak of his rebbe, Boruch pays the man $10,000! Boruch asks the instructor, “Is there any danger to human life involved in this jump?”

The instructor answers in the negative and opines that Israeli children jump out of planes by the time they are six!
Then, Boruch jumps out of the plane. On his way down, he notices that “787 Dreamliner” is emblazoned on the side of the plane.
Boruch yells to Shimon who is still on the plane, “Wait! This plane is made mostly out of carbon fiber and not aluminum! It’s basically not made out of metal! Even Rav Dovid could agree that this plane protects a person, at least according to the Rashba!”
Shimon: Indeed, there are mainstream poskim that feel that way. But in a different letter, Rav Moshe Feinstein, zt”l, left this issue undecided as it relates to tumah. Moreover, while we are having this discussion, I researched the airport where this plane is landing. This plane will most certainly fly over a Jewish cemetery because there is one very close to
a Jewish cemetery. Moreover, as with all prohibitions (even rabbinic ones), one must use any money he has to save himself from violating one! (This was his real psak.)
At that point, Boruch turns to the skydiving instructor and asks him if he can quickly teach him how to jump out of a plane. The instructor agrees but says it
Shimon: Oh, good point. Sorry, I didn’t think of that. Don’t worry, I’ll tell your family why you aren’t on the flight. Enjoy your trip!
Rabbi Avrohom Sebrow is a rebbe at Yeshiva Ateres Shimon in Far Rockaway. In addition, Rabbi Sebrow leads a daf yomi chaburah at Eitz Chayim of Dogwood Park in West Hempstead, NY. He can be contacted at ASebrow@ gmail.com.
Moreover, as with all prohibitions (even rabbinic ones), one must use any money he has to save himself from violating one!

There was a time when I looked at the Western states basically in various shades of grey. This was probably a result of watching cowboy and Indian television shows when I was a child which were only in black and white. The deserts, the plains, the driedup riverbeds, the mountains, the peaks, the canyons, the buttes and arches all seemed as colorless as t he dusty town of Dodge City. Yes, I saw color depictions of the Western wilderness later in life, but it was not until Pesi and I began traveling beyond the Mississippi River that we were able to witness Hashem’s Master creations in full color. The contrast between the grassy plains, the desert, and the mountains illuminated by the sun at different times of the day was nothing short of spectacular. Our first trip to Nevada and Utah was in 2004, followed by Arizona in 2005 and Colorado in 2010. We have since been in all the Western states and were privileged to see unpar -
alleled majesty and beauty.
In August of 2018, we took a twoweek trip to Wyoming and the Dakotas. With the exception of Shabbos, we were
ning natural sites, encountered wildlife, visited museums and historic buildings, and explored numerous cities. In most of these locations, with the exception of
blue Ford. The next morning, we visited the Wyoming Territorial Penitentiary. The infamous bank robber Butch Cassidy was incarcerated there in 1894. Prisoners would be utilized in making straw sweepers, and there was a fascinating exhibit showing the process of how these brooms were produced. From there, we took a self-guided walking tour of Laramie focusing on the unusual street art on the face of many buildings. We also went to the University of Wyoming’s Art Museum which specializes in Western art and objects.
on the road every single day. We probably drove over 1,500 miles during these two weeks, but nevertheless we felt exhilarated even on these long journeys.
We toured National Parks, viewed stun-
Chabad, there was very little Jewish life, but some places places had a fascinating historic past.

We arrived late Monday afternoon in Laramie, Wyoming, and picked up our

After checking out of our hotel, we headed west towards the Medicine Bow National Forest. As we climbed the elevation, the scenery changed from livestock ranches to plains teeming with pronghorn antelope, which was then followed by snowcapped mountains surrounded by pine forests. The panorama was simply breathtaking!
That night, we spent in Cheyenne. We

We probably drove over 1,500 miles during these two weeks, but nevertheless we felt exhilarated even on these long journeys.Medicine Bow National Forest
went there mainly to remove the stitches above Pesi’s lips which resulted from a fall a week earlier. Our next stop on Tuesday was really exciting. We visited a bison farm where we were “herded” into a wagon and driven into a corral where these massive animals were grazing. The bison and buffalo (yes, there are differences between them) approached our wagon, and we were able to feed them and get close-up views. There were a number of nursing calves in various stages of growth. They are born with an average weight of 50-80 lbs. and will grow into 800-2000 lb. mammals. The farm had a collection of donkeys, horses, camels, and ostriches as well. We then visited the Wyoming State Museum and toured the Governor’s Mansion. We also went into a gift shop and bought a sculpture of a ram’s head with curved horns as a souvenir. We also picked up an American Indian designed bath sheet with deep




desert colors. We packed in a lot of activities in a short span of time, but we still felt relaxed throughout the day. We started out very early Wednesday morning since had about five hours of driving ahead of us. Our first stop, about ninety minutes away, was at Fort Laramie, which was a significant 19th century trading post and military instillation. Several important treaties were negotiated and signed there with the Northern Plains Indian Nations. When we arrived, we were the only visitors and were able to tour the place on our own. We then drove another three and half hours and arrived in Sturges, a recreated Western town that is the home of the annual Sturges Motorcycle Rally. We began seeing the arrival of the bikers before the upcoming weekend and caught them again on Sunday at a waterfall lookout near Deadwood, South Dakota. The jeans, t-shirts, leather vests, earrings and assorted chains were


part of the dress code of these bearded and tattooed bikers, some of them unfortunately associated with gangs. Pesi was intimidated by them and was stunned when I approached them and carried on a conversation. She was in utter shock when I asked them to pose for photos with me, which they cheerfully obliged.

The most significant highlight of the
day was our visit to Devils Tower. The Tower is a butte protruding nearly one thousand feet from the ground near the Black Hills National Forest. Devils Tower is sacred to over twenty Indian tribes. It’s a unique geological marvel; the columns are its most striking feature. We spent a good hour driving up to its base and another hour taking dozens of photos in ev-
ery angle of this natural wonder. We took a guided hike with a park ranger who explained the physical significance of this monument as well as the wildlife that make this region their home. We were especially charmed by the prairie dogs with whom we shared some of our fruit.
On Friday morning, we crossed into South Dakota and made our way to Hill City, the “Heart of the Hills.” We had rented a wooden cabin surrounded by hills and trees and alongside a stream for the upcoming Shabbos. It was a two-family cottage; we had the ground floor, and the upstairs apartment was not occupied. It was spacious and airy with picture windows facing the scenic surroundings. The warm, wooden interior was beautifully decorated with a fireplace encased with comfortable couches and recliners. A large kitchen with all necessary appliances, a dining area, cozy bedrooms and modern bathrooms were features that would made our stay relaxing and enjoyable. We had taken along a fair amount of prepared food from home and supplemented it with produce that we found in supermarkets. There were also many products on the shelves which had kosher certification. After some local shopping, we took showers and got dressed “Shabbosdik.” After all, the main ingredient that would provide spiritual meaning to our stay would be Shabbos herself.

After lighting candles, we davened Kabbolas Shabbos and sang “Lecha Dodi” together. After singing “Shalom Aleichem” and making kiddush, we had a very traditional seudah – challos, gefilte fish, chicken, broccoli kugel, carrots and sour cherry compote all accompanied by our traditional zemiros. It was too late, too dark, and too cold to take a walk, so
we called it a night. The next morning, we davened and sang together again, and I read the parsha out loud, stopping many times to discuss the subjects with Pesi. Our seudah consisted of gefilte fish, salad, cold cuts and Yerushalmi kugel, and more compote.
After taking a nap, we sat around talking and reading and noshing. I learned the Daf and then we studied Pirkei Avos together. After Mincha, shalosh seudos, Maariv and Havdalah, we relaxed and made some plans for the upcoming week. Shabbos ended after nine so we did not have a very long evening ahead of us. Before going to sleep, we had a mini Melave Malka and retired with anticipation to tomorrow’s itinerary, which would be a visit to Mount Rushmore.
Hershel Lieber has been involved in kiruv activities for over 30 years. As a founding member of the Vaad L’Hatzolas Nidchei Yisroel he has traveled with his wife, Pesi, to the Soviet Union during the harsh years of the Communist regimes to advance Yiddishkeit. He has spearheaded a yeshiva in the city of Kishinev that had 12 successful years with many students making Torah their way of life. In Poland, he lectured in the summers at the Ronald S. Lauder Foundation camp for nearly 30 years. He still travels to Warsaw every year – since 1979 – to be the chazzan for Rosh Hashana and Yom Kippur for the Jews there. Together with Pesi, he organized and led trips to Europe on behalf of Gateways and Aish Hatorah for college students finding their paths to Jewish identity. His passion for travel has taken them to many interesting places and afforded them unique experiences. Their open home gave them opportunities to meet and develop relationships with a variety of people. Hershel’s column will appear in The Jewish Home on a bi-weekly basis.


 By Shammai SiSkind
By Shammai SiSkind
On a dimly lit night in mid-March, an agent of the Syrian militant group the Galilean Lone Wolves quietly crossed from Lebanon into Israel. Months of observing the old and outdated security fence, spotting weak points in the barrier, and timing security patrols across the border had paid off.
On foot, the man moved slowly under the weight of the improvised explosive device he was carrying, one that had been carefully constructed by his colleagues in Lebanon under the tutelage of IRGC technicians from Tehran.
After hours of traversing difficult terrain, the man emerged from the brush at the appointed time and place to meet his Palestinian contact. The contact was waiting for him just where he said he’d be. In addition to the vehicle that would facilitate the rest of the Lone Wolf’s journey, the Palestinian came bearing gifts: a rifle, several 5.56 magazines, and an explosive belt. The Syrian entered the car, and the two men drove off.
Hours later, a massive explosion shook Megiddo Junction on Route 65 in northern Israel. The area was largely vacant and only a single individual was caught
in the Iranian IED’s 30-meter kill radius – Sherif alDin, a resident of the local village of Salem.
IDF forces that rushed to the area determined the attack was not a suicide bombing and the perpetrator
detonated a bomb in the middle of a highway. After two days, the Israeli government finally lifted the press ban on the events: police special forces had caught up with the two men on Route 889, an East-West highway near Tzfat that runs along the Lebanese border. After a short standoff and futile attempts to illicit a surrender, the Syrian attempted to detonate the explosive belt still in his possession. The police operators opened fire, killing him instantly.
There are still many, many questions surrounding this most unusual incident, one that could have ended much worse than it did. How did the attacker enter Israel? Who were the people or groups that assisted him? What prompted them to detonate their main payload on a mostly empty highway? Was his accomplice also killed in the final showdown with the IDF?
was still at large. Over the next 48 hours, the public remained largely in the dark about what had taken place at Megiddo – all that was known was that an attacker had apparently infiltrated from Lebanon and
But the one takeaway that is readily apparent is this: Iran is still very much invested in its regional proxies and is committed to bringing the fight to its enemies, especially Israel.
Many outlets reporting on the Megiddo bombing identified the main assailant as a “Hezbollah terrorist.”
Biden’s insistence on making peace with their long-time foe Iran made the royal family even edgier.
While that is, in fact, accurate, it’s also a bit misleading. The actual organization that took responsibility for the attack, the aforementioned Galilean Wolves, is a distinct group, but one founded, trained, and equipped through Iran’s Revolutionary Guard Corps. What Israel experienced last week at Megiddo is classic Islamic Republic strategy, the one that it has been using since its inception. From Hezbollah to Iraqi militias, all of these may have the trappings of independent organizations. But in essence, they are all merely proxies of the Iranian Ayatollahs.
This strategy has been quite effective in spreading the regime’s assets throughout the region and ensuring its political influence reaches way beyond its domestic borders.

But Iran’s approach of extending itself internationally has not been limited to funding and arming a jubilee of militant groups. It has come to define every area of its national policy, from its economics to its foreign relations. Due to the Donald Trump era sanctions, the fallout from the Covid pandemic, and relentless opposition at home, the regime has had to double down on this strategy in recent years. Last week, Iran’s strategy bore concrete diplomatic results – but perhaps not the results it expected.
With all the news about the escalation in the Ukraine war, banks around the world collapsing, and other more profitable headlines, it was easy to miss the reports on what might be one of the most important diplomatic developments of recent years, at least as far as the Middle East is concerned. The Kingdom of Saudi Arabia, the Sunni stronghold and long-recognized head of the Arab world, reconciled with long-time foe the Islamic Republic of Iran.
The deal was not brokered by the United States or any of the typical Western patrons usually behind such developments. No, this time the Accords were brokered by none other than the People’s Republic of China. Four days after representatives from the three nations gathered in Beijing, the foreign ministries of all parties announced that Tehran and Riyadh had agreed to resume diplomatic relations.
According to official reports, both countries agreed to reopen embassies within two months.

The Saudis and the Ayatollahs had severed ties nearly seven years ago. The immediate reason for that
move, initiated by Saudi Arabia, was an incident in 2016 when protesters stormed the Saudi Embassy in Tehran in response to the Kingdom’s decision to execute a prominent Shiite cleric. But that was only the straw that broke the camel’s back. Iran and Saudi Arabia had been at each other’s throats for years at that point.
Two years earlier, in 2014, the Civil War which erupted in Yemen provided a physical battleground for Iranian proxies and Saudi military hardware to duke it out in a kinetic war. That conflict, in turn, came on the backdrop of Iran’s not-so-secret ambitions of becoming the dominant power in the region and its decades-long policy of establishing and arming Shiite groups around the Middle East, a policy that the King of Jordan dubbed in 2004 the “Shiite Crescent.”
During these years, the shadow war between the two countries escalated dramatically. Iran provided its Houthi allies in Yemen with long-range weapons to attack Saudi Arabia and its critical infrastructure, including its precious oil fields. The Saudis suffered hundreds of individual attacks from rockets and drones. This was also the period of the Trump presidency, the administration that did a 180 on American policy toward Iran, reneged on commitments taken by its predecessor, and inflicted crippling sanctions on the Iranian economy. The combination of fighting expensive proxy wars across multiple countries and having its main sources of revenue under siege forced the Iranian government to begin looking for alternative ways of projecting and leveraging its power.
Many individual tactics were deployed by Iran during this time. But the common denominator of all of them could be phrased something like this: “Be the ultimate service provider for dictators in need.” During those years, Iran became more enmeshed in the Syrian Civil War, setting up IRGC bases in the country, and coordinating the smuggling of weapons and personnel into the war zone via Shia militias in Iraq and elsewhere. It strengthened its relationship with Russia, a decision that has been highlighted in recent months after it became clear Russia was using Iranian-built drones in its war against Ukraine.
Finally, Iran cozied up to China in a way it had never done before. Desperate to make some money off its primary petrol industry, and in serious need of foreign expertise to shore up its infrastructure, Iran signed a strategic partnership with Beijing in March of 2021. The “25-year cooperation program,” as it is officially called, commits Iran to provide heavily discounted oil to China in exchange for a $400 billion investment in Iran’s economy. The agreement did more for Iran than
merely guaranteeing an economic outlet and securing more durable roads. The relationship with Beijing also opened China to an important diplomatic asset, one that could be leveraged in the future if so needed. And it seems that the time finally came.
There are two very distinct possibilities of what prompted this deal, and in turn what it means for all major stakeholders involved – a list that very much includes Israel.
One narrative is the continuation of that which has been pedaled since U.S. President Joe Biden came into office over two years ago. Namely, that America’s lack of interest in the Middle East would allow other players, like China, to exert more influence. Traditional allies of the United States in that area of the world would become less sensitive to American interests and begin hedging their geopolitical bets.
The Saudis have had a dependent relationship with the United States for a very long time. The oil for security terms of that relationship has characterized not only the relations between Washington and Riyadh but, in a very strong way, the entire Middle East. But since the current U.S. Administration came to power, there has been a marked lack of interest in pursuing large-scale change, or really any interest at all in the Middle East. This has made the Saudis very nervous indeed. Biden’s insistence on making peace with their long-time foe Iran made the royal family even edgier. It was this state of affairs that forced the Saudis into reconciling – at least in part – with their regional nemesis.
Once the Saudis made that decision, the natural go-between was Beijing, a third party that already had close ties to Tehran. From this perspective, the deal can be seen as a capitulation by Riyadh to Iran’s yearslong strategy of regional dominance. Recognizing that it had the upper hand and that they, the royal family of Saud, no longer had strong Western patronage to rely on, they took the path of reconciliation rather than continue the fight.
cations for Israel. It is no secret that Jerusalem has been actively seeking relations with the Saudis for a long time. Diplomatic progress in the region in the form of the Abraham Accords was an icebreaker of sorts, demonstrating the possibility both nations could finally recognize each other in the same way fellow Gulf state UAE had done. The moderate trend of the Saudi government in recent years and the movement of modernizing its economy, industry, and even to some extent its society have also been major drivers toward normalizing with Israel. But, as everyone knows, the most important factor in bringing the two countries closer together has been their common enemy of Iran. Now that the Saudis have made amends with Iran, not only does that negate a major incentive for Israel –Saudi normalization – it also means the Saudis have made peace with the country that poses the single biggest existential threat to Israel.
This perspective has set the flavor for nearly all media reports on the deal. It has been echoed by many defense and political experts, and has even been touted by some Israeli officials.
However, there is also a completely different way of looking at this new Chinese-brokered deal, one that is commensurate with longstanding regional realities, as well as the terms of the deal itself.
The first point to revisit when questioning the above dominant narrative is this: Who came crawling to whom?
It has been taken for granted by many observers that the Saudis were the ones who initiated the deal, motivated by fear of Iran, concern over American apathy, or both. But the truth is, the Iranian government has been attempting to reconcile with the Saudis for over two years. The reason for this is pretty simple. While Iran is certainly not giving up its regional aspirations, it has learned from multiple experiences that it cannot afford to overextend itself. Tehran has learned the hard way over the past five years that partnering with dictators and deploying military assets internationally is not only costly, but it could also come back to bite you. Perhaps the best example of this is seen in Iran’s involvement in the Syrian Civil War. Iran invested untold sums of money and some of its most capable personnel in supporting the Assad regime. But the very expensive IRGC facilities and drone launch pads it set up in southern Syria immediately became targets for the Israeli Air Force. Yes, Iran does want to become the dominant political force in Syria, but it could not do that without exposing itself to the might of Israel’s military.
Similarly, picking a fight with the Saudis in the form of arming Houthi rebels is quite costly, not only monetarily, but also diplomatically. Achieving European sympathy, for example – one of Iran’s constant goals – is very difficult when everyone knows you’re perpetuating a humanitarian disaster in Yemen.
Considering all of this, it is hardly surprising that we are now seeing credible reports that it was the Iranians that reached out to Riyadh, and not the other way around. According to a recent publication by Reuters, for example, Ayatollah Ali Khamenei began getting frustrated with his foreign relations team in late 2022. He needed progress with Saudi normaliza-

tion. The constant battle with the Saudis was wasting valuable resources. They needed to figure out a way of taking the Saudi conflict off their plate.
It was at this point that senior Foreign Ministry officials in Tehran reached out to China. What did China likely do that Iran itself could not? They provided guarantees. You see, Saudi Arabia’s main concern with Iran is that it will continue to arm its adversaries in the region, especially those adversaries in Yemen and Somalia that are in very close proximity to its borders. The Saudis needed a concrete indication that reconciliation with Iran would bring an end to IRGC support of jihadists and other militant groups in the Horn of Africa. Because China is by far Iran’s most important ally at this point – more important than Syria, more important than Russia – it is Beijing specifically that possesses the clout and leverage to ensure Iran sticks to the terms of a peace deal. Once the Chinese were on board, the Saudis were ready to listen.
In this sense, the deal is primarily two countries
is really important to take into account, the behindthe-scenes process of Saudi Arabi and Israel becoming more cordial began long before the Iran-Saudi break in 2016. The likelihood and benefits of Saudi-Israeli normalization are not and should not be measured by how much both of them hate Iran. The economic, diplomatic, and social benefits of such a move would be vast, regardless of any shared enemies the two states may or may not have.
Lastly, it is worth bringing up the significance of China’s role in this deal.
The first thing to consider is that China may have bit off more than it can chew. As the broker of the deal, China has also positioned itself as the guarantor. In the same way that a deal orchestrated by the United States breaking apart would make Washington look very bad, similarly, if Iran cannot come through on its side of the agreement, resulting in the Saudis pulling out, it would be a real embarrassment for PRC. The chances of that scenario unfolding are actually pretty significant.
As many observers have pointed out, Iran simply may not be able to prevent its long-time proxies from continuing their attacks on the Saudis. Iran has been prodding the Yemeni rebels to pummel Saudi Arabia with missiles for the past six years. The Ayatollahs waking up one morning and telling them, “We’ve changed our minds” might not fly with the Houthi leadership who have their own grudges against Riyadh. It would be a real shame for the first significant peace deal orchestrated by PRC to fall through.
tired of fighting each other finally finding an avenue of mutual appeasement. This point is salient while looking at the language of the deal itself. As the official statement reads, the agreement includes “the two countries’ affirmation of the respect for the sovereignty of states and the non-interference in Internal Affairs.” In regular English: Don’t bother us; we won’t bother you.
Now, as far as Israel is concerned, while there is always some measure of fear whenever any country begins softening up to Iran, this concern should be seen in proportion. As should be clear, the Saudis are not agreeing to support, partner, or in any way collaborate with the Iranians other than agreeing to reopen embassies that they already had. Furthermore, and this
Secondly, and this is still admittedly well within the realm of conjecture, China positioning itself between the Saudis and Iran could actually be beneficial for Israel in the long-term. China has for a long time been actively seeking economic and technological partnerships with Israel. There is still a very active department within Israel’s Foreign Ministry to further collaborations with China. While that trend has certainly been tempered by pressure from Washington in recent years, it has certainly not been brought to a halt, and China is still eager to work with the Jewish State in as many ways as possible. If China sees Israel as an asset, it may very well find fitting to use its influence to bring Saudi Arabia closer to Israel.
In short, the recent deal is far from a catastrophe not for Israel, or for anyone else. But it certainly does open a whole new realm of possibilities for the region moving forward.
Because China is by far Iran’s most important ally at this point –more important than Syria, more important than Russia – it is Beijing specifically that possesses the clout and leverage to ensure Iran sticks to the terms of a peace deal.


I recently moved to a more religious community. My parents both weren’t raised religious, and they wanted to become closer to G-d this summer. This was my first year here and my first year of high school. It was a really hard adjustment considering that I always went to public school. I was looking forward to a lot of things in high school such as a prom. Hearing the news that we were moving to a different state not knowing anyone for high school was devastating. I accepted the fact and respected my parents for the choice to become closer to Judaism. I came into school with a open mind, and I didn’t really know what to expect. I made a lot of friends, and I was doing well in my classes. This was until a girl who I really never had anything to do with started making up rumors about me. I keep Shabbat and all the mitzvot. This girl – we’ll call her Bella – said that I don’t and that I’m still the same person I was before I came here.
Teen Talk, a new column in TJH, is geared towards the teens in our community. Answered by a rotating roster of teachers, rebbeim, clinicians, and peers (!), teens will be hearing answers to many questions they had percolating in their minds and wished they had the answers for.


I really love my school, and they make me feel very welcome. I don’t know what to do about Bella – she lies to my friends about me and makes up a lot of garbage about me. My friends started to believe it, and I kinda wish I was back at my old school with my old friends.
Thank you so much for writing to Teen Talk. Although your particular situation may be unique, the problem you describe is far from unique, unfortunately. Leaving everything you knew in your hometown and moving to a new community can be challenging under any circumstances. I am so proud of you for appreciating your parents’ yearning for spiritual growth and going along with the move somewhat happily. Even though you felt you were giving up some pretty special experiences, you decided to be positive and give it your best shot. Good job! It seems you successfully adjusted and made friends and began to build a new wonderful life.
And then came Bella – the thorn in your side. Bella – who will do anything she can to try to bring you down.
Life is filled with many a “Bella.” These are people who have low self-esteem and who are
obviously jealous of the ones they try to bully and take down. If you look through the Book of Psalms, Sefer Tehillim, you will see that King David often refers to his enemies who speak disparagingly of him, and who literally tell lies about him, all in an effort to destroy him and his good name. King David tells us that indeed this is painful, but in the end, truth and justice always prevail. I encourage you to stay strong in your self-confidence and don’t lose your trust in the good people around you.
Perhaps you can encourage one of your teachers to give a lesson on the Torah values we are commanded to acquire and display. For example, the Torah tells us not to gossip, not to speak badly about another Jew. We are also warned not to hate another Jew in your heart, and we are most
certainly told never to embarrass a ba’al teshuva and remind them of their previous life. Bella is completely acting against the Torah and Torah values. As the saying goes, “Don’t confuse Jews with Judaism!” The Torah guides us in a beautiful way. Unfortunately, not everyone appreciates that.
When my youngest daughter was a little girl, she was being bullied by a girl in her class. I took her to my friend, a child psychologist, to help her with this challenge. He began by explaining to my daughter that all “her Bella” really wanted was to be my daughter’s friend. She just didn’t quite have the social ability to figure out how to get there. He recommended that my daughter compliment this girl once a day for two weeks and that she would see a real change. As hard as it was for my daughter to come up

with two weeks’ worth of compliments and actually say them to her “bully friend,” she did it. And wouldn’t you know it? The psychologist was right! All this girl wanted was to be accepted by my daughter.
I understand that you are in high school and the stakes are much higher, but the root of the issue is the same. Bella just wants to be liked and accepted by you – as you are liked and accepted by the others.
As far as your friends actually believing Bella, I think it is time for you to have some conversations. I bet if you speak to them and explain how hurt you feel and how far you have come,
Are you a teen with a question?
If you have a question or problem you’d like our columnists to address, email your question or insight to editor@fivetownsjewishhome.com , subject line: Teen Talk.




they will see the holes in the stories Bella has told. I bet deep down none of your friends really believed Bella in the first place. Don’t wait – talk to them now! As far as Bella goes, I believe you need to speak with her as well. As hard as it might be for you, really look at Bella and find her good
qualities. Then you can warmly point them out to her and tell her how much you care for her wellbeing. Once you win her over, you will see that is all she ever really wanted.
I wish you the best of luck. You seem like a winner to me!
I would like to start by saying I’m very grateful to be engaged to a really great guy. My problem is dealing with my mother since I have gotten engaged. In general, she is a very detail-oriented person and likes to be in control. I have navigated this fine until now, but at this point, I also have a chosson to think about and his wants and needs. He was telling me how his family all has pink gowns from a previous chasuna, and judging by the fact that I also really like pink, I told my mother I wanted pink to be the color of the wedding. She adamantly refused, stating “All the women will look like frosted cupcakes.” She’s insisting the color be hunter green. This is just one example of the many things I have to deal with. It also makes me feel very uncomfortable how when she’s talking to people she calls it, “my wedding,” as in her own. She also insisted on putting together registries of the things I need to start a home when I was really planning on going through the sites and creating one with my chosson. I find myself constantly making excuses to him for my mother but I know it’s unhealthy.
First of all, how can I deal with her? And second of all, should I admit that there’s clearly something wrong with my mother?


Mazal tov on this milestone. Good for you for reaching out for help with this matter of your mother’s overinvolvement. The examples you cite are pretty serious reasons for concern.

It’s hard enough to deal with so many pressures at this time in your life. It would be wise to access professional help so that you can deal effectively with your mother during the wedding planning, engagement, and beyond. You are right in your perceptions that this is “we” time: you and your chosson’s. While you may want to give your mother some areas of involvement, there are some boundaries and strategies you want to enlist.
Parents generally pay for weddings of children even when they are seasoned, independent adults. This, of course, makes matters more complex when a parent tries to own the event. Don’t duke this out
on your own or even with your chosson. Be smart as well as respectful. Get help and use appropriate language.
As a general rule of thumb, it’s not a good thing to hide things from your spouse, kal v’chomer, your future husband. I believe you should absolutely talk to your chosson about this and your feelings surrounding it. Not only will you feel good about being open and honest with him, but you will become closer through it. He will be able to give you the emotional support you need throughout this time.
Your mother clearly has a problem with control. If I were to psychoanalyze her from this small glimpse you have shown us, she likely had all of her decisions stripped from her during her own wedding planning and is now living vi-
cariously through you. It is possible she is taking this as her opportunity to plan the perfect wedding based on her opinions. Thankfully, we live in an age where therapy and help is no stigma, and you should probably see someone to make sure you do not follow in the same footsteps when your daughter gets married.
With your chosson on your side and a completely open relationship between the two of you, you will be able to more confidently assert your decisions to your mother without having to make any excuses to the other side. It will be hard to stand up for yourself, but with the right tools and the right people by your side, you will be successful.
It’s common in the Orthodox community for parents to pay for their children’s weddings from start to finish. Due to this fact, it’s natural for parents to approach their children with the attitude of “MY wedding,” as they are typically organizing most of the details as well as paying for the event. (I hope it’s OK that I’m assuming that this is your positionality in this case.) With that being said, your mother’s attitude is pretty typical for the classic, excited, and particular Jewish mom.
My mentor once told me that our greatest stresses come from blessings. For example, we can be overwhelmed from our job, but thankfully we are employed. We can be overwhelmed by the responsibilities of a wedding, but thankfully we have something to celebrate. We can be stressed out by cooking for yom tov, but thankfully we have the money to spend on food. I would encourage you to have the same attitude for your wedding as it would be a pity if these nuances felt so important that they overshadowed the anticipatory joy that your wedding day holds.
Lastly, you can respectfully try to communicate your feelings to your mom, while exercising high levels of gratitude for the financial and practical role that she plays for ensuring your wedding is a beautiful success.
Dr. Jeffrey Galler
What to do? A lot might be contingent upon how dependent you and your husband will be. You might have to accept her interference if you are going to need your mother’s financial support for the next five years while living in her basement.
Perhaps you and Mom can agree to hire a wedding planner, who can be the buffer between you.
In any event, you must decide which issues are vitally important to you, like the wedding colors, and explain to Mom that while you love and appreciate her, her organizational abilities, and her advice, there are some decisions that you and your husband will be making. Be prepared for an emotional confrontation.
Now, here’s my secret formula for getting your way. It would be useless for you to try and sit down and reason with Mom, because you will be constantly interrupted and sidetracked with emotional arguments and counterarguments. Instead, write out a clear and concise list of reasons for the wedding to be pink,and let Mom read it.
Then, pick a sentence that is simple and irrefutable, like, “Mom, I love and appreciate you, and the wedding color is going to be pink.”
Then, whatever your mom says, simply repeat that sentence, and nothing more.
The conversation might go like this:
MOM – It cannot be pink. I want hunter green.
YOU - Mom, I love and appreciate you, and the wedding color is going to be pink.
MOM – Didn’t you hear what I said? Do you want everyone to look like frosted cupcakes?!
YOU - Mom, I love and appreciate you, and the wedding color is going to be pink.
Flamingos! That’s what everyone will see! This is what I get for giving birth to you, diapering you, and raising you?
MOM – Flamingos! That’s what everyone will see! This is what I get for giving birth to you, diapering you, and raising you?
YOU - Mom, I love and appreciate you, and the wedding color is going to be pink.
MOM – How can you be so ungrateful? No. It can’t be pink. My friends will all laugh at me.
YOU - Mom, I love and appreciate you, and the wedding color is going to be pink.
MOM- You are so stubborn! But I told all my friends, “Hunter green!”
YOU - Mom,
I love and appreciate you, and the wedding color is going to be pink.
MOM – (Tearfully) I can’t believe you’re fighting me about this!
YOU - Mom, I love and appreciate you, and the wedding color is going to be pink.
MOM – Don’t you respect my opinion? I have more experience. You’ll thank me if you listen to me!
YOU - Mom, I love and appreciate you, and the wedding color is going to be pink.
MOM – I don’t think you hear me. I said, “NO PINK!”
The Navidaters
Dating and Relationship Coaches and Therapists
Thank you for writing into the panel. From your short email, it is clear that your mother struggles with control and boundaries. It is also clear that as a result of your mother’s struggles with control and boundaries, you are suffering. You likely want to please her and/or are scared of her reactions if you choose to displease her.
Let’s break this down a bit. First things first: having needs and wants that are different from your mom’s does not make you a disrespectful child. It makes you human. Healthy parents understand this. But we can’t force someone to understand us. We can only respectfully set a boundary and hope for the best.
With regard to how you conceptualize and present the issue to your chosson, I think it may be time to stop excusing your mother. Over time, that dynamic will begin to frustrate your husband, if it hasn’t already begun to frustrate your chosson. This will erode your attachment and bond because he will feel completely unseen, unheard, uncared for and believe that your
priority is your moth- er. He will also likely feel that you are part of the prob - lem, maybe even more a part of the problem for him than your mother herself. When two people marry, their order of priorities within the family system need to be as follows:
1. Spouse
2. Children
3. Parents (This is not my opinion. It is backed by an incredible amount of research.)
When allegiances and priorities are out of this order, trouble and problems ensue.
Many parents struggle to understand their place in their adult children’s lives. When adult children do not understand that the responsibility is theirs to navigate or correct, this always leads to heartache and stress on a marriage. When adult children do understand that the responsibility is theirs to fix, though potentially difficult, a marriage can be saved and flourish!
You are not responsible for your mother’s behaviors and actions. She is her own
YOU - Mom, I love and appreciate you, and the wedding color is going to be pink. MOM –What’s wrong with you? I can’t take any more of this. Okay, pink. But, you’ll be sorry.
Anyway, you get the idea. As long as you are loving, respectful, unemotional, reasonable, and do not allow yourself to get sidetracked from your simple declaration, I believe that you will prevail.
(Isn’t it sad that what should be the happiest time in a family’s life, should be fraught with such relatively unimportant drama? Baalai simcha need to remember what is and what is not really important. The whole wedding is over and mostly forgotten after several hours, but love and life-long relationships endure.)
independent person, and you can’t stop her from doing what she does. You can, however, let her know what your boundaries are; what makes you feel safe and comfortable; and what makes you feel unsafe and uncomfortable. Whatever happens after that, when done with respect and kindness, is on your mother...not you. Here is a potential script to your chosson and then one to your mom (for starters.)
To your husband to be:
“I want you to know that I’ve been doing a lot of thinking about my mom and my relationship with my mom. I know that I have been making excuses for her. I’ve probably done it my whole life. My mom can be a bit controlling, and it’s something I’m aware of and I want to take responsibility and learn to navigate that relationship. I never want to allow her or anyone to get between us. Please always let me know if she or I am making you feel uncomfortable. Your feelings are my top priority.”
To your mother:
“Mom, I love you so much. I want you super-involved in my wedding, and I appreciate everything you do for me. I’m going to be making my own registry with my chosson, and I would love your input if you’d like to share it.” And, “Mom, I know you love hunter green. And as much as I’d love to make you happy with that color, I like pink. I’d like to try to figure this out together.”
I understand that in frum circles, par-
ents are very heavily involved in weddings as they are paying for them. Healthy parents understand that their children’s needs and wants matter and they try to make room for them as they understand that this is their child’s wedding, not theirs – regardless of who is writing the checks.
Weddings can be very stressful, and if people struggle with control in general, it is likely to be on full blast around a wedding. I’d like to suggest a good read that may help you set boundaries with your mom. It is called The Book of Boundaries: Set the Limits That Will Set You Free by Melissa Urban. You can follow her on TikTok, too. I do! If you or any of the readership feel you may be struggling with setting boundaries (codependency) check out a Codependent’s Anonymous group (CODALI.org) and/or speak with a therapist to begin healing and living life, respectfully and kindly, on your terms and without fear of repercussions.
If you are a parent who finds him/ herself constantly battling adult children, you may be struggling with codependency, too. Talking to someone can help. You can potentially improve your relationships with your children and find the closeness you are seeking. Closeness does not come from control. Closeness comes from allowing freedom, believing in your child, and setting them free to make their own decisions...even on your budget.
Wishing you all the best, Jennifer
Closeness comes from allowing freedom, believing in your child, and setting them free to make their own decisions...even on your budget.
Q:Dear Etti, My preschooler was petrified of Haman the whole month leading up to Purim and now is crying about Pharaoh and the Mitzrim. I know that they are teaching the material in a loving and non-scary way, but my daughter is very scared anyway. She thinks they are going to come hurt us. Help!
-Still Being Chased by the Egyptians
A:Dear Still Being Chased, Some children have more vivid imaginations than others. Some children are considered highly sensitive children. It sounds like you have one of those children.
So did I. (She is grown now, with children of her own ka”h, but I still remember her fears.)
Children need to know that they are safe. They need to hear that the story of Purim happened many, many years ago and that Haman is no longer around. Haman is dead. He was a very bad person, and Hashem did not want this very bad person to hurt the Jews. They need you to reassure them that Pharoah and the Egyptians lived a long time ago and that they are no longer here.
Our children need safety and stability as their foundation before they begin to deal with adversity and the unfairness of the world. When children feel that security, they deal with frightening stories with aplomb, that wonderful childhood blanket of knowing this could never happen to them. We need to focus on the here and now first, and then talk about what happened many years ago.
Hatred, war, people wanting to hurt other people; our history is full of such stories. We need to address it, but also reassure our children that the adults in their life would never let anything happen to them.
Unfortunately, many teachers and parents are not aware of this need.
In The Journal of Positive Psychology in 2021 , psychologists Jeremy D. W. Clifton and Peter Meindl explain that adults often stress how the world is dangerous and bad to keep kids safer. Unfortunately, it actually does the opposite. If children believe the world to be a dangerous and bad place, it will affect how they see the world and their role in it. They will grow up to be less
trusting, more suspicious of people’s motives, and very scared to be in the world, as bad things might happen.
They suggest that we deal with what our children are learning or hearing, but we should take the time to share how our world is safer, more affluent, and more successful than how it was in the past. We should focus on the fact that the world is full of good people and that the adults work hard to make sure the bad guys can’t get them.
Some parents are ultra-sensitive as well and avoid uncomfortable discussions about war, bad people, and the like. This can be a mistake. It makes children become even more anxious, as they get concerned about “what must be so terrible that my mother is avoiding the topic?” Find someone to ask your questions to, an older parent, a seasoned teacher, and get their advice on how to approach these topics as they arise.
Sensitive children could use stories that address these scary topics with happy endings. The Purim story has a happy ending to stress. The Pesach story has a happy ending to stress. Both have numerous audio fun ways to explore the story, cartoon depictions, and opportunities for you to review the story and help them see the miracles and celebrate how Hashem is always there to protect us.
Be aware that some teachers like to use shock and awe as a technique in their storytelling, not realizing that

the details that excite some of the children are terrifying the others. If you have a highly sensitive small child, share that with the teacher, and perhaps the rebbe or morah will allow your child to go do an errand during such times, or he/she could tone his/her dramatics a little. For many children, the drama and details are the exciting part, and we want to think about them as well! Older children should be able to listen and then come home and debrief with their parents.
Even in older grades, our daughter would come home from school needing to analyze and discuss the different wars she learned about in history and have us reassure her that they were in the past.
Be happy you have a sensitive child! Sensitive children are more aware of others’ feelings. They are more sensitive to others’ needs. They are more compassionate and react more strongly to injustice. These are children who will help shape the next generation!
We don’t want to shelter our children. We just want to give them a proper perspective:
might be up, but in reality, it is still affecting a small percentage of people, wars happen but b”H not in our backyard. Build a firm foundation to raise resilient children.
May we be zocheh to welcome Moshiach speedily in our days,
-Etti
We should take the time to share how our world is safer, more affluent, and more successful than how it was in the past.Mrs. Etti Siegel holds an MS in Teaching and Learning/Educational Leadership and brings sound teaching advice to her audiences culled from her over 35 years of teaching and administrative experience. She is an Adjunct at the College of Mount Saint Vincent/Sara Shenirer. She is a coach and educational consultant for Catapult Learning, is a sought-after mentor and workshop presenter around the country, and a popular presenter for Sayan (a teacher-mentoring program), Hidden Sparks, and the Consortium of Jewish Day Schools. She is a frequent contributor to Hamechanech Magazine and The Journal for Jewish Day School leaders. She will be answering your education-based questions and writing articles weekly for The Jewish Home. Mrs. Siegel can be reached at ettisiegel@gmail.com.
Many adults find it hard to appropriately express their feelings. For some, even isolating which feeling they are experiencing can be challenging enough. Often, we misinterpret our emotions when feelings are running deeper. An example of this is acting angry or lashing out at others when, in reality, we are experiencing embarrassment. We may yell at an innocent party who wasn’t even around when the initial incident occurred. Feelings are truly very complex.
Many naively think that children lack the full range of emotions. They innocently think that children can’t experience many of the same feelings we adults do – such as shame, confusion and anxiety. The reality is that even newborns can feel certain emotions. As children develop, they quickly experience more and more of what adults do. Even toddlers can begin to feel embarrassed.
Unintentionally, adults may laugh at a little one’s antics and the child may feel shame or embarrassment. Parents may seem confused when their child quickly switches from playfulness to anger and tantruming. They fail to realize their child interpreted the adult’s laughter as making fun of them and this caused the rapid emotional shift.
If adults can find it challenging to recognize and express their emotions, we can only imagine how difficult children will find it. As parents, we can help our youngsters to identify and appropriately express the vast range of feelings they will encounter. Furthermore, we can help them learn to communicate their emotional needs similar to how they express their physical ones. It can be frustrating for children to be unable to express themselves and we may find other feelings being masked and confused by anger or frustration. The hope is that the more we provide our children with ways to describe their feelings, the better they can express themselves and work through their emotions.
As children become more emotionally aware, they are able to provide a surprising amount of insight into their inner world.
We know we shouldn’t label children, but we certainly can label their feelings. Children don’t automatically recognize what they’re experiencing, and it can be helpful when we provide that information. There are posters and cards that show pictures of a variety of emotions children may feel, along with a corresponding facial expression. Therapists, teachers, and parents can use these to help children identify what they are feeling at a given time. The facial expressions and other descriptions can be helpful for children who are not yet able to recognize an emotion based on name alone.
We can help by labeling an emotion as a child is feeling it. For example, when we see they’re jealous they didn’t win a prize, we can provide the words, “It’s normal to feel jealous when someone gets something we wanted.” We can also model this behavior when in our children’s presence, “I am so frustrated that I burnt lunch – I was really looking forward to it.”
Feelings and their origins can be very vague. Verbally expressing those feelings is even more complex. As parents, we’d like to help our children use the words they need.

Additionally, we want our children to learn emotionally healthy ways to speak with others. It’s too easy to hurt others when trying to get one’s own needs met. Effective communication skills are crucial for all relationships. Married couples may spend years learning appropriate ways to speak with each other. When possible, we want to encourage our young charges to make their needs known in a way that will not hurt others or lessen shalom. It’s a fine art to reach out to another and productively share with them when they’ve hurt us with-
out offending them or raising their defense mechanisms.
Communicating in such a mature fashion can be difficult for children and certainly isn’t intuitive. “Share your feelings with me” is too vague. It may be helpful to give them a formula to guide them.
As an example, “I feel (insert emotion) when (insert person’s name) does (insert action or behavior)” is one potential formula option. “I feel embarrassed when you yell at me in front of others.” “I feel angry when he takes my toys.” “I feel happy when you take me to the park.” It may be helpful to have a list of feelings hanging up for the child to use as prompting.
You may have noticed the popular “I” language. When we use the word “I,” it’s less threatening and aggressive than “you.” “I feel angry” is gentler than “you make me angry.” “I feel hurt” is going to get a child farther than “you hurt me.” “I” language is also beneficial because someone can argue whether or not they did something to make you angry, they can’t so easily insist you don’t feel anger.
It doesn’t matter what a child is feeling or why, their feelings are considered valid. This doesn’t mean we are saying it’s good they got angry or a positive thing that they feel jealous; it just means we are acknowledging they do feel the way they do. It’s counterproductive to insist someone feels differently just because we don’t think they should feel that way.
“State the problem, ask your needs” is another formula kids can use to tell someone what they require. Children can act out or do any of a number of inappropriate behaviors in an effort to get their needs met. Encouraging them to state their problem and ask their needs is more appropriate. Rather than scream, “Where
is the pencil?!” (at the highest decibel possible), a child can be encouraged to say, “I can’t find a pencil (state the problem), can you please help me (ask the need)?” Instead of screaming, “Move!” a better option would be “I want to sit there. Can you please move over?”
Aside from being far more polite, this formula more accurately makes their needs known. Randomly screaming “where is a pencil?” won’t quickly get someone to help you search. “Move” is rude and is unlikely to motivate someone to give you a spot.
When children are willing to share their feelings with us, we should be grateful and not critical. We never want to mock or discount their feelings. Just because we wouldn’t feel that way doesn’t mean they don’t. This also isn’t the time for mussar.
For example, when a child expresses feelings of jealousy, “How could you feel jealous when you get so much?” is a sure-fire way to ensure a child doesn’t open up again so fast. There are plenty of other opportunities to be mechanech our young ones – even if we think they can do better now.
Communication is the basic foundation of human relationships, yet is so challenging. When we teach the next generation effective means to communicate their feelings and needs, we are giving our children a gift that will last them a lifetime.
Much hoopla has been advertised throughout the media regarding eating too close to bedtime, along with advising those to “eat your meals early.” Does it really make such a difference if one chooses to eat dinner at 6:30 p.m. vs. 9:30 p.m.? How does eating late affect potential increase in weight?
The truth is that consistently eating late night meals throws our body out of sync and is directly correlated to poor health. Studies on late night meals show increases in blood pressure, blood sugar, changes in metabolism, and weight gain. There have been many studies which discuss the link between latenight snacking and obesity. There are potential risks of increased fat and compromised success in weight loss. Contributions of decline in weight loss can be due to the choices our body will make as someone who is very hungry eating late. Some of the main aspects that are at play are the way we burn calories – which results in weight decreasing and burning of fat. One study done by Harvard Medical School found that individuals who ate much earlier than other individuals showed a significant difference in their hunger levels, the way they burnt calories after eating their meal, and the way they stored fat.
To understand our hunger levels, we must first understand the hormones involved in our body. There are two hormones that play a role in the way we eat and how our hunger works: ghrelin and leptin. Ghrelin increases appetite, is released primarily in the stomach, and is thought to signal hunger to the brain. One would expect the body to increase ghrelin if a person is undereating and decrease it if they are overeating. Leptin, on the other hand, is a hormone made by fat cells that decreases your ap -
petite. Leptin lets your body know that you are satiated. Results have shown from studies that eating later had profound effects on hunger and the appetite-regulating hormones leptin and ghrelin, which influence our drive to eat. Specifically, levels of the hormone leptin that signals satiety were decreased across the 24 hours in the late eating conditions compared to the early eating conditions. Therefore, individuals who choose to eat later may want to keep on eating even though they are full because their hormonal signals telling them they are satiated aren’t working as efficiently.
An additional reason why individuals who eat later may be more likely to gain weight is because of the “latenight/midnight snack” mindset. Many individuals will tend towards highly caloric foods late at night, namely cookies, chips, sodas – all of which are not high protein and not necessarily nutritious options.
Those late-night snacks and cravings may just be your body telling you you’re actually tired and should get a good night sleep. Something that may very well help those cravings is to eat enough and consistently throughout the day and to get enough sleep! In a study of 12 young men, sleep deprivation was associated with an increase in ghrelin levels, appetite, and hunger compared with when they slept 10 hours a night. However, if you are getting a good night’s sleep and eating enough throughout the day, those late-night snacks are certainly okay if you have a grumbling stomach! A better alternative for those who get hungry late at night is to have some high protein snacks which contain fiber, like some carrots and hummus, dark chocolate covered strawberries, or an apple with some all-natural almond butter.

An additional concern of eating later is the role that one’s metabolism plays. Metabolic rate is defined as the

series of chemical reactions in a living organism that creates and breaks down energy necessary for life. More simply, it’s the rate at which your body expends energy or burns calories. There are differences in the speed of metabolism. A slow metabolism burns fewer calories, which means more may get stored as fat in the body; that’s why some people still have difficulty losing weight when just cutting calories. A fast metabolism, on the other hand, burns calories at a quicker rate, which explains why some people may eat a lot and not gain as much weight. By nature, as the day goes on, we become less active because we are no longer running around doing errands, working, or anything else we may do that requires us to be out and about. Later in the day, due to the fewer calories we burn, may be prime for weight gain when food is eaten so late. Since most of us tend to be much less active at night, our organs become less active as well. Because of this, the body doesn’t require as much energy as it does throughout the day, so our metabolism slows down.
Although our metabolism is always working and is still in effect when we sleep, in order for it to work most efficiently, we should ideally try not eating at least two hours before sleep. This will support a good sleep schedule and promote a restful sleep in which we are burning calories in the most effective way.
However, if you are interested in speeding up your metabolism so that you can burn those calories not only through eating earlier in the day, but also so it can keep working efficiently throughout the day, there are many beneficial steps you can take. We can speed up our metabolism by being more active and increasing our phys -
ical activity. A great and easy activity can be just walking! Another excellent exercise is something known as HIIT, high intensity interval training, which puts your body under “stress” for a little and then back to “normal.” This kind of workout can really rev up one’s metabolism, not only right after the workout, but research shows that this kind of process can keep the metabolism working and burning calories for even multiple hours after you finish exercising. Weight training/strength training in addition to aerobic exercise can also be beneficial, because through weight training, we are building muscle mass, which increases our bodies’ ability to burn energy. Both forms of exercising –combining strength activity and aerobic activity throughout the week – can help speed up our metabolism and manage our weight.
There are some tips and tricks to avoid eating so late at night and to curb those cravings. A good idea may be to eat regularly throughout the day. Make sure to eat breakfast, lunch, and dinner, along with filling snacks, which will help keep you satiated and keep your energy levels up. Additionally, keeping a food diary and planning your food intake can
be very helpful if you usually tend to eat later. If you know in advance what you plan on eating and are keeping tabs on it, you will be less likely to head to the kitchen late at night.
Another good idea would be to preplan and portion your snack. If you anticipate that you will feel hungry later
be tempted to indulge. Also, it may be beneficial to brush and floss after eating your last meal or snack for the day, because that will signal to you that you are “done” for the night.
Another idea may be to drink some water before heading to the kitchen if you feel in the mood for those late-night
and are in the mood for that snack, have it ready in a portion-controlled snack bag or plate, so you are being mindful of what you are eating.
Additionally, try to eliminate your “trigger” foods from the house; if you don’t have access to it, you cannot eat it! Behaviorally, it may be helpful to avoid hanging around the kitchen area late at night, especially if you know you will

snacks. Sometimes the body is trying to tell us that we are thirsty, and we misinterpret it as being hungry. Drink at least one cup of water, wait a little, and if you still feel hungry, then have a portion-controlled, healthy, satiating snack. All of the above modifications can be helpful tips and tricks to use if you feel any of those cravings and temptations coming on.
All in all, the time of day you eat doesn’t directly affect how your body processes food and/or directly causes weight gain, but it most certainly will influence it. However, what is important is your overall calorie intake for the day, which depends on how active you are, what kind of calories you are intaking, and how early you are eating. Unfortunately, though, oftentimes people who eat late at night tend to opt for the high-calorie foods that their bodies can do without. Therefore, avoiding food after dinner may help to promote weight loss. Even so, if you miss a healthy dinner at 6:30 p.m., there’s no reason not to eat it at 9:30 p.m. as long as it is a well-balanced meal. You will feel full and satisfied and will avoid falling into the “late-night snacking” situation, thereby ensuring you feel your best at a healthy weight and lifestyle.
Aliza Beer is a registered dietitian with a master’s degree in nutrition. She has a private practice in Cedarhurst, NY. Patients’ success has been featured on the Dr. Oz show. Aliza can be reached at alizabeer@gmail. com, and you can follow her on Instagram at @alizabeer

Those late-night snacks and cravings may just be your body telling you you’re actually tired and should get a good night sleep.
Idon’t work on Fridays, except when I do.
Like today, the sixth grade science classes, finishing up a geology unit, invited me to watch their performances. I will never again take for granted the Earth’s layers.
I noticed that somehow the boys with their squeaky, high-pitched young voices are beginning to evolve into their teen years and seem to be turning back into their precious younger selves. We have had a few rough patches during the in-between years, but I sat there listening to their changing voices sing and rap so terribly yet being so cute, and I found myself believing that they will turn out okay.
One of the sixth grade boys, “H,” who has spent a lot of quality time with me in my office came over to say goodbye and wish me a good Shabbos as he was leaving to go to his bus. I asked if he had time to bring my bag to me from my office.
His bus had already been called, and I didn’t want him to miss it so I told him I would get someone else to do it.
“Oh no, Mrs. Deutsch, I want to do it. I have enough time.”
“Oh, H., I will miss you next year,” I responded. (The sixth grade is the last grade in our school.) To be honest, there was a time that this would have been my fondest wish.
“Mrs. Deutsch, why won’t I see you? You’re not coming back next year?” he asked incredulously.
“No, H. You are the one who is not coming back!”
Today, I also got to witness what a “born leader” looks like. In kindergarten, I had to call and tell a tense and crying mother that I had no class in which to place her son as no one had requested him, and essentially, some kids had “dis-requested” him.
I can tell you that there are not many harder calls to make.
I told her that we would figure it out, but I needed her help and partnership;
No one needs to cry for him now!
As teachers and administrators, we seem to be glued into place as we witness class after class cycle through the
ache and tears. Yet it seems to me that through my long and very rewarding career, those who gave me the most pain in the past are the very same ones who bestow the most reward today.
I had a student a very long time ago during my time working in the Yeshivah of Flatbush, a school known for its emphasis on academic rigor and strict behavior protocol, who was very out of every box. Though this boy was bussed daily from Staten Island, Tzachi never got to school wearing shoes nor did he ever do his homework or have a full set of books.
Tzachi followed me to Camp Morasha where we laughed a lot about his continued foibles. And yes, they continued.
One day, long after school was long done and many summers had passed, I was sitting in my office at Kushner when a sleek Mustang convertible pulled up. A tall, impeccably dressed young man walked into the building asking to see me. I must say that I did not recognize the sophisticated young man standing in front of me.
It was Tzachi; he was wearing highly polished Italian leather loafers to thank me.

“Look, Mrs. Deutsch, shoes,” he said. “Thank you for believing in me.” Take it from me. It does not get much better than that! Tzachi, “E,” “H,” and thousands upon thousands more, thank you!
she had to get him help.
Today, I watched in joy as he led the singing and dancing with his heart and soul, and his colleagues lined up behind him. He sets the tone as the clear class leader; he led and the others followed.
His Rebbe, standing next to me, nodded his head in acknowledgement of “E’s” charisma and power!
grades. We witness short people grow tall (some taller than others), teeth fall out and grow back (some naturally and others by accident), girls turn into women and boys into men.
Some transition smoothly, less so since COVID; try to get an appointment with a therapist these days. And others grow older, coupled with a lot of heart-
Barbara Deutsch is currently the associate principal at HANC 609 and a longtime reflective educator, parent, grandparent, and new great-grandparent. Even after all these years, she still loves what she does and looks forward to working with kids every single day.
“Look, Mrs. Deutsch, shoes,” he said. “Thank you for believing in me.”


I am a teacher in a day school and a student will be returning to class after experiencing a family tragedy. I am unsure of how to approach this situation, and I would like to provide guidance for both the student and classmates to make the reintegration process as smooth as possible. What advice can you offer in this challenging situation?
Rabbi Dr. Dovid Fox responds:
This is, sadly, a common dilemma facing both children and adults. When someone is returning to school, shul or work following an absence related to mourning, illness or other crisis, it is important to have a plan of “dos and don’ts” so that the transition is not awkward or hurtful. Let’s look first at how the situation is handled in Jewish law. The custom is that when a man who has been sitting shiva returns to the shul, he is called up to the Torah. One facet of the practice of giving him an aliyah is to demonstrate that he is welcome and is once again part of the congregational community.
When a student has been away because of an illness or loss, it is a wholesome and healthy gesture to demonstrate that the class welcomes him or her back and wants them to return to the social environment. The concern, of course, is doing so while remaining sensitive to the classmate’s own feelings of sadness, worry or self-consciousness.
They might be feeling ill at ease, or concerned about having missed schoolwork, or might still be preoccupied with distress and memories of their loss or ordeal. The return to school should not become awkward to the student, the teacher or the rest of the class.
A general rule to follow is that, prior to the return, the teacher recommends that each classmate is encouraged to take a moment to approach that student one on one and simply say, “You have had a rough time. It’s good to have you back” or “You were missed. Glad that you can rejoin the class.” Generally, it is best to avoid flooding the child with questions. They do not want to be interrogated and asking them for details may be an unwanted and uncomfortable invasion of their wish for privacy.
Returning to school should feel natural and normal. Good friends should remain good friends. Mediocre friends or those with minimal prior relationship
with the student should not use this time to try becoming best friends, which will feel unnatural to the student. A good friend should inform the student that if she or he wants to take a walk and talk, they will be there for them. If the student does not feel like talking but would appreciate their company, they will be there for them, too. Friends can offer to help the student catch up with assignments and homework. Teachers, too, should quietly approach the student and inquire about how they are doing at this time and offer any support or time needed to return to their schoolwork.
Most youngsters do not want a lot of pity nor do they want to feel that others see them as needy, impaired or no longer capable of regular tasks. No one should make assumptions about how the child is feeling or what they have been through. If he or she feels safe and cared about, they might selectively share elements of their experience. At times, a student

wants to get back into their routine and not disclose their experience. This should be respected, and no one should expect tears or out-of-character conduct. When a student is behaving in ways which do attract concern about their functioning, this is best brought up with the school counselor or principal so that helpful steps can be taken. Otherwise, the classroom is not a venue for counseling or probing with a student. Rather, it is a safe haven for readapting to one’s former routine and schedule. The best approach is to normalize the school atmosphere for the returning student.
A final caveat: very young children will generally not need preparing prior to a classmate’s return. They do not comprehend the realities associated with another child’s trauma. They may not be attuned to the emotions experienced by that child, and usually do not track the passage of time or the causes of a friend’s absence. The integration into the classroom is often automatic once that child is ready to return.
It’s important to remember that everyone grieves differently, and it is in our hands to respect each individual’s own process, even if it’s not what you might expect or have experienced personally. Our compassion and support for the student will help them and their classmates heal and move forward together.

Serves: 4
By AdinA SilBerm A nThis recipe can also be adapted to make 4-6 whole chicken legs instead of drumsticks.

Ingredients
▫ 12 skin-on chicken drumsticks
▫ 1 lemon, sliced
▫ ¼ cup olive oil
▫ 3 tablespoons grated garlic
▫ 2 shallots, minced
▫ ½ cup honey
▫ Zest of 2 lemons
▫ ¼ cup fresh lemon juice
▫ 1 teaspoon kosher salt
▫ ½ teaspoon freshly ground black pepper
▫ ½ cup fresh parsley, finely chopped, plus more for serving
Preparation
1. Preheat oven to 375℉. Add drumsticks to a 9x13-inch baking dish; arrange lemon slices around chicken.
2. Heat oil in a skillet over medium-high heat; add garlic and shallots and sauté for about 8 minutes, until golden.
3. l ower heat and add honey, lemon zest, lemon juice, salt and pepper; cook until sauce thickens and is bubbly, about 5 minutes. Add parsley and mix.
4. Pour sauce over chicken and cook, uncovered, for 1½ hours, basting chicken halfway through. Serve chicken with sauce and more fresh parsley.
Recipe courtesy of Fleishigs Magazine Pesach Issue, www.fleishigs.com.
About Fleishigs Magazine: The fifth annual Fleishigs Pesach cookbook (we mean issue!) has landed. Formulated like a real cookbook with everything from basics (like Adeena Sussman’s preserved citrus and Busy in Brooklyn’s spiced pomegranate molasses), soups, salads and sides to fish, chicken, meat and dessert. Beyond the recipes, read interviews with women-owned companies offering Pesach products. And finally, check out a sample menu put together by Elisheva Taitz of Pesach recipes that can all be found from prior issues on the Fleishigs app.
◦ 4 sheets matzah
◦ ½ cup olive oil
◦ 6 cloves garlic
◦ ½ teaspoon kosher salt
◦ ¼ tsp cayenne pepper
◦ 1 pound sushi grade tuna

◦ 2 avocado, cubed,
◦ 1 mango, cubed
◦ 3 scallions, minced
Preheat oven to 400°F.
Arrange matzah on a baking sheet.
Mix olive oil, garlic, salt, and pepper and brush on the matzah and bake for 10 minutes. Let them cool and break into bite-size pieces.
Arrange matzah pieces on a large platter and top with tuna, avocado and scallions.
You can add additional toppings before serving such as spicy mayo, kosher for Pesach soy sauce, and crunchy onions.

I wrote this recipe for Fleshigs Magazine last year and so many people told me how much they enjoyed it. The magazine publishes monthly and has really creative and innovative recipes, and I am always honored when they ask me to create recipes for them.
I make this a lot during the year and serve it with nacho chips.
I thought using matzah would be a creative way to enjoy this over Pesach.
O
YS: What are the specific demographics of Orthodox Jews that a larger company with a wide reach might want to target?
MT: In 2017, I did a study, a profile of the American Modern Orthodox community. That study was covered in a publication called “World Religion News,” and the photo that they put on the front cover was of a chassidic couple. So, even an organization like “World Religion News” was absolutely clueless that there’s really a difference between Modern Orthodox, charedi, chassidic, Sephardic, etc.
Before I get to the numbers, I’m going to tell you that for a little group, we have a lot of really interesting subgroups with different ways of living and areas of interest. The American population is about 330 million, of which about 7.5 million in total are Jews. The Jewish community has always been about 2% of the population. Within the American Jewish community, the Orthodox are about 10%-12%.
* * *So, you’re really talking about 900,000 Orthodox Jews, which is not that much. But they are clustered geographically in the tri-state area and a few other areas, making them more marketable. It’s not like they’re spread out over all 50 states. That 900,000 is also growing very rapidly.
The largest subgroup is Reform Jews with just under 3 million, then Conservative Jews with about 1.2 million, and then the Orthodox with about 900,000. If you said 20 years ago that the Orthodox would be almost as large as the Conservative Jews,
people would have thought you were crazy. But the birth rate is very high.
In terms of the subgroups, there are two broad groups. There’s the Modern Orthodox and the charedi. There’s also the chassidim, who might live in Williamsburg, Brooklyn, Satmar, the Lubavitch in Crown Heights, etc. These groups live in very tightly clustered and reachable neighborhoods. In addition, there’s a group in the United States called Sephardic Jews. All of the groups I mentioned up to now are basically called “Ashkenazi.” Ashkenazi Jews hail from Central Europe, Eastern Europe, Russia. The Sephardic Jews come from Western Europe, Spain, Portugal, Morocco, Egypt, Iran, Syria, and Iraq.
What type of companies can benefit by specifically targeting our community?
In my view, the biggest difference between Orthodox Jews and the rest of
his column features business insights from a recent “Mind Your Business with Yitzchok Saftlas” radio show. The weekly “Mind Your Business” show –broadcasting since 2015 – features interviews with Fortune 500 executives, business leaders and marketing gurus. Prominent guests include John Sculley, former CEO of Apple and Pepsi; Dick Schulze, founder and Chairman Emeritus of Best Buy; and Beth Comstock, former Vice Chair of GE; among over 400+ senior-level executives and business celebrities. Yitzchok Saftlas, president of Bottom Line Marketing Group, hosts the weekly “Mind Your Business” show, which airs at 10pm every Sunday night on 710 WOR and throughout America on the iHeartRadio Network.American society is, first, that they marry very young. They marry at 19-21. Second, the community has an extreme focus on children. I’ll pay a little bit of demographic hopscotch with you. Two is the median number of children that an American family has. Among the Modern Orthodox, the median is 2-4. So, the modern Orthodox are growing faster than the American community, but not as fast as the Yeshivish community. The yeshivish community typically has 4-6 children, sometimes 8. The chassidim have about 6-8, and even numbers in the double-digits are not that unusual.
What does that mean? Not only do they have a lot of children, the philosophy of caring for the children, nurturing them, watching them, and supporting them is extreme in the Orthodox community. And having a lot of children means that they have to be fed and clothed. Orthodox standards, for much of the community, require

clothing to be nice, good quality, and not super casual. There’s definitely a market for people who offer clothing for children. Of course, there’s kosher food. Given the size of the families, there’s a lot there in terms of their houses. There’s always a lot of expansion of homes going on. If you go into certain Orthodox neighborhoods, every other vehicle on the streets might be a minivan. We’re not talking SUV six-seaters; we’re talking eight-seaters. So, in all of these areas, there is significant need in this community.
With Shabbos every week and so many Jewish holidays, what is the median annual spend for food in a Orthodox family vs. the average American family?
I’ve heard that the number for a typical American family is $6,000 ($500 a month). For an Orthodox family, it might be between $10,000-$12,000, or larger. It all depends on what people buy. Do you buy organic, etc.? We did a survey last year on the costs of living the Orthodox lifestyle, and the extra cost of kosher food was listed as one of the factors that people are aware of. On the whole, the cost of food was not seen as a super-burden, but it was seen as somewhat of a burden because we have the equivalent of a Thanksgiving dinner 60-65 times a year, through our Shabbos and holidays.
Between me and you, the challenge is not so much the cost of the food; it’s just keeping my weight down. On that note, I know that many of my relatives who live in Orthodox neighborhoods all go to fitness classes. A lot of these fitness classes are men-only and women-only because the Orthodox like that separation of the genders. So, there’s another area where there’s a market opportunity.
Could you share some of the data you’ve gained in the studies you’ve conducted on the Orthodox Jewish community?
When Orthodox Jews were asked what the biggest hit to their budget was, many of them said the cost of education. They’re talking about elementary and high school education. But there is also a real, growing demand in the community for secular secondary education. For example, a Modern Orthodox kid might seek to go to a place like Columbia and take courses in history and philosophy. But for the other two-thirds of the Orthodox community, the chassidic and yeshivish, there is a growing demand for programs that teach people skills to earn money. They might go to Yeshiva University or Touro College to
study medicine, law, accounting, computer programming, etc. These are two universities that cater to the Orthodox community. And there are also programs in the community that don’t require admission to a college, training institutes that might train somebody in computer programming, or that kind of thing. I think there’s a growing realization that the cost of an Orthodox lifestyle is expensive, and we need to have better ability to earn money.
Another area to look at is simchas (joyous celebrations). When you get invited to an Orthodox Jewish wedding, you might see between 350-550 other people there and wonder, “Do the parents of the bride
true, not only in the Orthodox Jewish community, but in other religious communities as well, such as the Amish, Mennonite, Seventh Day Adventist, and Mormon communities. So, there’s definitely a market for clothing. Another example, I have a General Electric stove oven, and it has a Shabbos mode. My daughter got a Samsung refrigerator, and it had a Shabbos mode switch. There are certain requirements, in terms of the non-use of electricity on Shabbos. So, when you open the refrigerator door, you don’t want the light to come on, and the Shabbos mode prevents that. And apparently, the market is big enough for Samsung to put in that
getting married, you can probably borrow a wedding gown from dozens of organizations. Any item you might need, like a baby carriage or an exerciser, you can get one, borrow it for six months, and just make an $18 donation. Having said that, your average American family has about 2 children and the average charedi median is in the 6-7 range. That means every expense that’s tied to children is tripled – clothing, food, diapers, formula, etc.
What are some things that a general marketing agency might not know about marketing to the Jewish Orthodox community?
really know all these people?” There is actually a commandment in our community to share our simchas. So, we might invite almost everybody in our synagogue or our circle. This results in a lot of fun events, but it also results in a lot of food and catering opportunities.
We also have a lot of newspapers in our community. If you go into any Orthodox home, you’ll see newspapers with 200+ plus pages. And the thing I’ve noticed is that a lot of them offer things like tourism packages, especially around the holidays. Our community takes our religion very seriously. We’re very diligent about it. And we need breaks, so we go on vacations, especially around the holidays. There are definitely opportunities in the marketing area to provide quality locations with kosher food. And there are many consultants out there who can advise on getting speakers that are appropriate and anything else.
The specifics of the community do suggest that there are some areas that should be focused on by marketers to a greater extent than in the American community as a whole.
Aside from the food industry, are there any other types of companies that have really leveraged opportunities to expand their business in the Orthodox community?
Sure. For one, there are clothing companies that sell modest clothing. That’s
switch. We’re a small community, but we have specific needs. And smart companies like GE, Samsung, the clothing companies, and the food companies that have thousands of products with kosher symbols, all understand that there is a market, and they can meet their needs.
What are some more interesting stats, facts, and figures about the Orthodox Jewish segment?

One of the questions that’s often asked is, what are the incomes of these large families? The incomes are high; they tend to be dual income families. Remember, we’re talking about families in the New York area. The median household income is in the $120,000-125,000+ range. That sounds like a lot, but when you have six or seven children, that’s a lot of kids to cover. Among these families, the median amount that gets spent on an elementary and high school education is in the low $30,000s. If they have a child in college, it’s also in the low $30,000s. So, for those families that have children ranging from age 8-18, they might be spending $60,000 on education. And of course, they’re spending more money on housing because they live within walking distance of a synagogue since they don’t drive on Shabbos.
Let me just add that the Orthodox community is remarkably self-reliant. They have enormous charitable organizations and charitable participation. If you’re
I recently did a study with a marketing firm that was hired to do research in a strong yeshivish community for a local healthcare facility. The question was, since most yeshivish people try not to go online, how do you get them to fill out a survey? As I mentioned, every one of these communities have very vibrant newspapers. So, we placed an ad in the local Jewish newspaper. For some strange reason, while people don’t go on the unbridled internet, they do go into WhatsApp communities and chat groups. So, we sent thousands of WhatsApp messages and status reports. And finally, we did a paper survey through the mail. So, one of the things you need to know about reaching Orthodox communities is that you may need to be creative. We ended up getting 400 responses to the survey. About half were from the online communication and about half were paper surveys that got mailed in. You also need to be sensitive about how you present your material. Depending on the community you’re in, it will affect the photos that you use. For example, some communities might have modesty concerns regarding pictures of women.
“The largest subgroup is Reform Jews with just under 3 million, then Conservative Jews with about 1.2 million, and then the Orthodox with about 900,000.”
So many reporters here. I just saw a reporter start interviewing someone but they turned out to be a reporter, too.
- Tweet by Huffington Post reporter Christopher Mathias reporting from a “pro-Trump rally” outside Manhattan’s criminal court last weekend where the media was present to document the pending violence
It’s just a bunch of cameras taking pictures of a guy who is putting on a rat suit next to a guitar with the words “Hang Fauci” on it.
– Tweet by NBC reporter Ben Collins

Remember this: If it weren’t for me, Ron DeSanctimonious would right now be working probably at a law firm, or maybe a Pizza Hut, I don’t know.

- Trump attacking Florida Gov. Ron DeSantis while talking to reporters
I don’t know how to spell the sanctimonious one. I don’t really know what it means, but I kinda like it, it’s long, it’s got a lot of vowels. We’ll go with that, that’s fine. I mean you can call me whatever you want, just as long as you also call me a winner because that’s what we’ve been able to do in Florida, is put a lot of points on the board and really take this State to the next level.
– Gov. Ron DeSantis in an interview with Piers Morgan when asked about Trump calling him Ron DeSanctimonious
The way TikTok is programmed, it preys on children. It’s disguised as candy, and it’s actually cocaine. And I think this is coming out everywhere.
- Keith Krach, who served as undersecretary of State for Economic Growth, Energy and the Environment

You know, when you’re a certain age, you use words that you know from when you were a kid or you remember saying, and that’s what I did today and I shouldn’t have. I should have thought about it a little longer before I said it, but I didn’t. And I should have said “cheated.” And I used another word. And I’m really, really sorry.
– The View’s Whoopi Goldberg, who has never been the “sharpest tool in the shed” and in the past has said that the Holocaust wasn’t driven by racism against Jews, apologizing for saying on air last week that “people felt gypped off” because the term gypped is… wait for it…disparaging to gypsies
- Former liberal Congressman Barney Frank (D-MA), who was the main sponsor of the Dodd-Frank bank reform law that passed after the 2008 meltdown, in an interview with the Financial Times, defending his current position as a board member of Signature Bank, which was shut down last week
You know what we’ve been saying for years that one of these days, we’re going to wake up, and Trump will have been arrested for one of these many crimes? Well, that day could be tomorrow.
— Jimmy KimmelYou’ve got to give it to him. It’s not often that everyone sends out a save-the-date for their own arrest.
- Jimmy Fallon
But you never know with him. Either he’s about to actually be arrested or he’s releasing another round of digital trading cards for us to buy. We don’t know for sure.
- Jimmy KimmelKenne was good at just about anything he tried to be good at and was wicked smart — but that didn’t stop him from trying his best to do absolutely nothing except drink, smoke, and listen to music.
- From an obituary for Kenneth Joseph Pluhar Jr. of Illinois, age 62, written by his very honest, funny, and loving daughter last week
[Chareidim] should begin to learn core studies because F-16 fighter jets are only in English.
- Dan Halutz, a former IDF chief of staff, mocking religious Israelis at an “anti-judicial reform” rally
Just like we won in the Independence War, you will win in the second war of liberation.
- Ibid.
The process that the Left is undergoing in Israel – they are comparing us to fascists and to Nazis and to 1930s Germany – is reminiscent of [ Germany.] What was there in 1930s Germany? Thugs for hire did political terror in the streets – not murder, by the way. They did not kill anyone. [They conducted] political terror via intimidation, violence, and disruption of public order... They created chaos and then they brought their party into power non-democratically.
- Prime Minister Netanyahu’s son Yair on the Caroline Glick podcast, talking about the Israeli protesters
They are the ones that are shouting for dictatorship. They are the ones that are marching Israel toward fascism. They are the ones that are adopting the same methods as the “Blackshirts” in Italy and in Germany.
- Ibid.
If exactly the same proposals were being made by a centrist government, or left-wing government, no one would notice. There would be no demonstrations. There would be some academic discussion, law school teachers would be teaching it, but hardly anyone would care.
- Famed attorney Alan Dershowitz commenting on judicial reform
Even if all of these reforms were to be enacted, it would turn Israel, G-d forbid, into Canada, New Zealand, or Australia, or many European countries.
- Ibid.
The minister must refrain from giving operative instructions to the police, either directly or indirectly, and this is especially true regarding protests and demonstrations against the government.
- Supreme Court Justice Yitzhak Amit ruling that National Security Minister Itamar Ben-Gvir is prohibited from giving operational instructions to the police during anti-judicial reform demonstrations
Both Netanyahu and Putin are blaming outside agitators and foreign funding for their problems… It’s right out of the dictators’ handbook.
- Thomas Friedman, in a New York Times article, comparing Netanyahu, who is trying to reform Israel’s judicial system, to Putin, who is responsible for the murder of hundreds of thousands of innocent civilians
It’s pretty bad when the very first time you ever hear of a bank is when they’re going out of business.

- Stephen Colbert, referring to the Silicon Valley Bank fiasco
I don’t see how a bank could lose all their money that fast. Why don’t they just attach the money to those chains they put on the pens?
– Ibid.

On the bright side, it was refreshing to hear about a crash that had nothing to do with a selfdriving Tesla, don’t you think?
– Jimmy Fallon
Biden tried to put everyone at ease. He said, “Don’t worry, I got through the first Great Depression. I’ll get through this one.”
- Ibid.
In response, Trump said, “It’s times like these where we need a president with experience of multiple bankruptcies.”

- Ibid.
Pity is a benign form of abuse. I can feel sorry for myself, but I don’t have time for that.
 By David Ignatius
By David Ignatius

Henry Kissinger must have sense of deja vu as he watches China broker a rapprochement between Saudi Arabia and Iran. The triangular diplomacy is very similar to the former secretary of state’s own opening to China in 1971.
“I see it as a substantial change in the strategic situation in the Middle East,” Kissinger told me during an interview this week. “The Saudis are now balancing their security by playing off the U.S. against China.” In a comparable way, Kissinger notes, he and President Richard M. Nixon were able to play off tensions between Beijing and Moscow in their historic engagement with China.
The de-escalation of tensions in the Persian Gulf is good for everyone – in the short run. And if Chinese President Xi Jinping wants to take on the role of restraining Iran and reassuring Saudi Arabia, good luck to him. The United States has been trying since 1979 to bend the arc of the Iranian revolution toward stability.
But over the longer run, Beijing’s emergence as a peacemaker “changes the terms of reference in international diplomacy,” Kissinger argues. The United States is no longer the indispensable power in the region, the only country strong or supple enough to broker peace deals. China has claimed a share of that convening power.
“China has in recent years declared that it needs to be a participant in the creation of the world order,” explains Kissinger. “It has now made a significant move in that direction.”
China’s growing role also complicates Israel’s decisions. Israeli leaders have viewed a preemptive military strike against Iran as a last resort, as Tehran moves ever closer to becoming a nuclear-weapons state. But as Kissinger notes,
“pressure on Iran will now have to take into account Chinese interests.”
The Chinese have been opportunists. They have capitalized on the diligent (and mostly thankless) efforts by the United States to bolster Saudi Arabia and to resist Iranian proxy fighters in Yemen, Iraq, and Syria. The United States built the road to rapprochement, so to speak, but the Chinese cut the ribbon.
Secret Saudi-Iranian talks began two years ago in Baghdad under the sponsorship of then-Prime Minister Mustafa alKadhimi, a U.S. partner. Some sessions were held in Oman, an even closer U.S. ally. In six negotiating sessions, Iranian and Saudi representatives agreed on a road map for resumption of diplomatic relations, which Saudi Arabia suspended in 2016 to protest Iran’s covert support of Houthi rebels in Yemen. Before reaching final agreement to reopen embassies, the Saudis demanded that Iran acknowledge its support for the Houthis and curb their attacks.
Washington has also laid the groundwork for a settlement of the horrific war in Yemen. Tim Lenderking, the State Department envoy for Yemen, helped negotiate a
cease-fire last April. Civilian flights now operate from Sanaa, the Yemeni capital, and goods are flowing through Hodeidah, the country’s main port. The Saudis recently deposited $1 billion in the Yemeni central bank to stabilize the country.
Enter China, to harvest the goodwill. When Xi visited Saudi Arabia in December, he pledged that he would use Beijing’s influence with Iran to close the deal. When the three sides met in Beijing this month, Ali Shamkhani, Iran’s national security adviser, admitted backing the Houthis and agreed to stop sending them weapons, according to a knowledgeable source. Iran also pledged that it would not attack the kingdom, either directly or through proxies.
Two months from now, assuming the Iranians restrain the Houthis, the two countries will reopen embassies in Riyadh and Tehran. Hopefully, Lenderking can negotiate a peace agreement in Yemen by then, too.
The elephant in the room remains the Iranian nuclear program. With the collapse of the 2015 nuclear agreement, Iran has stepped up its uranium enrichment,
and experts say it probably could test a simple nuclear weapon within months if it wanted to. But here, too, Iran seems to understand that it is near the cliff’s edge. Tehran pledged this month that it would allow the International Atomic Energy Agency to resume intensive monitoring of its nuclear sites.
Iran’s clerical regime is in retreat. Its currency has collapsed; its young women have defied the government edict to wear headscarves, and residents say the public is speculating about what kind of country will emerge after its aging supreme leader, Ayatollah Ali Khamenei, is gone.
The Middle East, so long a zone of confrontation, is becoming a balancing game. Saudi Arabia is newly friendly with China and Iran but is also working with the United States by providing $400 million to Ukraine; spending $37 billion for 78 Boeing airplanes; and backing a new 5G and 6G cellular technology known as O-RAN that could supplant China’s Huawei.
The United Arab Emirates is courting China, too, but it is also maintaining its defense relationship with the United States – and settling regional quarrels with Qatar, Turkey and Libya. The UAE has gone from “Little Sparta,” as former defense secretary Jim Mattis once dubbed it, to “Little Singapore.”
The truth is that a unipolar Middle East, where a dominant United States was encouraged in confrontational policies by its allies Saudi Arabia and Israel, wasn’t a very stable region. A multipolar Middle East, with its ceaseless hedging and balancing, will have its own dangers. And as Kissinger suggests, it will be a new game with new rules.
 By David Ignatius
By David Ignatius

Pentagon strategists have always divided the world into East and West, with U.S. regional forces under European Command or Indo-Pacific Command. But looking at the embrace of Presidents Xi Jinping and Vladimir Putin this week, you wonder whether we may need a single “Eurasian Command” to handle an integrated threat.
A strong China is bolstering a weak Russia. That’s the real headline that describes the showy meetings in Moscow this week between the two countries’ leaders. The Chinese aren’t providing weapons (yet), but Xi certainly offered moral and psychological support in what might be described as a get-well visit to an ailing relative. White House spokesman John Kirby on Tuesday rightly called Putin a “junior partner.”
The paradox of the Ukraine war is that Putin’s bid for greater power in Europe has made him weaker. This diminished Russia will fall increasingly under China’s sway – unless there’s an unlikely turn post-Ukraine and a Western-leaning leader replaces Putin. Maybe that’s the biggest reason for Xi’s fraternal visit: He is bolstering a flank against America and the West.
China’s dominance over a weaker Russia will take many forms in the coming years. Russia has lost its energy markets in Europe because of its reckless invasion, so it will depend ever more on demand from China and other Asian customers. China’s economic sway grows every year in central Asia and in Russia’s own far east. Its hard power in space, cyber, robotics and artificial intelligence will increasingly dwarf Russia’s.
Xi’s rescue strategy for Russia seems to center on a peace plan that would stanch the bleeding in Ukraine. From what we know, Xi proposes a cease-fire agreement that would freeze Russia’s gains from last
year’s illegal invasion. That version won’t fly with Ukraine or the United States. We won’t know for a few days whether Xi will talk with Ukrainian President Volodymyr Zelensky in a way that opens a real process of negotiation. That seems unlikely. But so did the Iran-Saudi deal that Xi brokered this month.
keep the high ground, invoking the sanctity of the United Nations charter even as he affirms his support for the Russian leader who shattered that charter’s norms. It’s a shameless approach, but smart diplomacy.
Xi’s emerging role as the leader of a Eurasian bloc presents dilemmas for U.S.
cow in the June 2021 summit in Geneva in part to concentrate on the Chinese challenge. That didn’t work out as the White House hoped, to put it mildly.
Now it’s Xi who is the triangulator. He is playing off the bitter split between the United States and Russia, helping Putin, but also keeping a bit of distance, too. Xi similarly used China’s close relations with Iran to make the diplomatic breakthrough between Riyadh and Tehran that the United States could never achieve.
Though Putin was beaming in Xi’s reflected glow this week, the visit was a reminder of just how isolated the Russian leader is. President Biden hosts a prominent foreign leader at the White House every other week. When was the last time you saw a major foreign leader visit the Kremlin? (The president of Belarus doesn’t count.) Xi’s get-well visit will give his “dear friend” Putin a psychological boost and help his domestic popularity. But other than China and a few outliers, Russian stands alone.
If you were looking for another reason why it’s important that Ukraine succeeds against Russia, consider the photos from Moscow. “The President of Eurasia” – I fear that’s the invisible caption of the pictures of Xi that we’re seeing amid the Kremlin’s golden doors and red carpets. The idea that a vast swath of the world is dominated by a China that stands so resolutely against freedom and democracy is chilling. If this alliance succeeds, we will live in a darker world.
By playing the peacemaker, Xi can position himself better to take other, harsher rescue measures if Ukraine rejects a cease-fire. He could offer ammunition for Russia, arguing he’s only leveling the playing field. He could try to mobilize nations of the Global South, such as India, South Africa, and Brazil, to pressure Ukraine to end the fighting. Xi wants to
strategists. For a generation, separating China from Russia was a central goal of U.S. foreign policy. Driving that wedge was a major reason for the historic visit to China in 1972 by President Richard M. Nixon and national security adviser Henry Kissinger. The Biden administration initially hoped it could try that strategy in reverse – warming relations with Mos-
The bottom line: The International Criminal Court indicted Putin last week for war crimes. Xi is his only powerful friend. Dealing with them separately is bad enough. If they truly become partners in Eurasia, sharing dominion under a Chinese banner, that would be worse.
The Chinese aren’t providing weapons (yet), but Xi certainly offered moral and psychological support in what might be described as a get-well visit to an ailing relative.
 By Marc A. Thiessen
By Marc A. Thiessen
President Ronald Reagan said that the nine most terrifying words in the English language were “I’m from the government, and I’m here to help.” Well, he’s been proved right once again, this time by the collapse of Silicon Valley Bank (SVB). The bank’s failure –the second-largest in U.S. history – was a direct result of its own gross mismanagement, combined with a series of well-intentioned government interventions run amok that created the conditions for its catastrophic failure.
Government intervention No. 1: In December 2008, the Federal Reserve cut its benchmark lending rate to near zero for the first time, and then kept interest rates artificially low (below the economy’s natural rate) for an extended period. Instead of an emergency measure, abnormally ultralow rates were a fixture of the U.S. economy for more than a dozen years. This created incentives for banks such as SVB to hold Treasury bonds –whose value depends on low interest rates – under the belief that they were “safe” assets because low interest rates would continue in perpetuity.
Government intervention No. 2: When Covid-19 hit, government-imposed lockdowns effectively brought the economy to a standstill, forcing businesses to close, too many of them permanently. These shutdowns did immeasurable damage, putting millions of Americans out of work.
Government intervention No. 3: During the shutdowns, the federal government pumped more than $5 trillion into the economy – providing direct cash payments to businesses and individuals. With his $1.9 trillion American Rescue Plan, President Biden continued this miasma of spending long after it was needed: sending millions of Americans stimulus checks, the largest child tax credit
payments ever, and absurdly generous unemployment supplements that paid many Americans more to stay home than to work. Because people were getting free money but had nowhere to spend it, personal savings rates soared to the highest level on record, with households amassing $2.7 trillion in excess savings. The result? When the economy opened up again, consumer spending skyrocketed – but supply could not keep up with demand, producing the worst inflation in 40 years.
Government intervention No. 4: After Congress hit the accelerator, overheating the economy, the Fed slammed on the brakes and began raising interest rates in an effort to tamp down spending-induced inflation. This had the effect of driving down the value of Treasury bonds – because as interest rates go up, bond values go down. This proved disastrous for SVB, which had invested tens of billions of dollars of its clients’ venture capital money in Treasury bonds. Ironically, these were
supposed to be safe investments. But because of this disastrous sequence of government actions, they were suddenly deeply devalued. This left the bank with billions of dollars in unrealized losses on the books and sparked the bank’s collapse.
Government intervention No. 5: Now, the FDIC has stepped in to create a new lending authority and to guarantee the assets of all Silicon Valley Bank depositors, even though less than 10 percent of the bank’s deposits qualified for FDIC insurance under the $250,000 limit Congress set to protect the assets of average Americans. The FDIC decided to extend this coverage to SVB’s wealthy uninsured tech investors anyway, bailing them out and thus rewarding risky behavior. Worse, by guaranteeing deposits above the $250,000 limit, the government is creating a new moral hazard – effectively establishing a universal uninsured deposit guarantee. Once the FDIC guarantees
the deposits of all SVB clients, it cannot justify not doing the same for other banks as well. The result will be a nationwide no-risk banking system that we will one day come to regret.
And, so, the chain will go on.
Some on the left are arguing that it was a lack of government intervention that led to the bank’s collapse and are blaming Donald Trump and the 2018 partial rollback of the Dodd-Frank banking reforms he signed into law as president. This is incorrect. The Dodd-Frank rollback – one of the few bipartisan pieces of legislation passed under Trump – still left SVB subject to lots of regulation and oversight. As Sen. Jon Tester (D-Mont.), who led the bipartisan effort to reform Dodd-Frank in 2018, told Politico, “If you read the bill, you’ll know that it doesn’t let them off.” Higher capital requirements wouldn’t have mattered, and the bank’s money was in what most considered the lowest-risk assets possible: Treasury bonds. Just two weeks before SVB’s collapse, KMPG, one of the big-four accounting firms, gave the bank a clean bill of financial health. The problem wasn’t poor regulation. The problem was that the bank was terribly managed.
But absent this domino-like series of government interventions – starting with unprecedented near-zero interest rates which encouraged SVB to buy Treasurys, and followed by unprecedented lockdowns, government-stimulus-fueled consumer spending, runaway inflation and rising interest rates that devalued those Treasurys – this bank failure would never have happened. It’s just the latest evidence that Reagan was right when he warned us: “Government is not the solution to our problem – government is the problem.”


PEACEFUL PRESENCE STUDIO
Men’s private yoga, Licensed Massage & Holistic Health Guidance
436 Central Ave, Cedarhurst Info. & free video training
www.peacefulpresence.com
516-371-3715
GERBER MOVING FULL SERVICE MOVING
Packing Moving Supplies
Local Long Distance
Licensed Insured
1000’S Of Happy Customers Call Shalom 347-276-7422
HANDYMAN AVAILABLE
For big or small jobs, Sheetrock, carpentry, painting, electrical, plumbing, install & repair appliances
Call Ephraim at 347-593-4691
VACUUM SALES AND REPAIR
All areas call Max Flam 718-444-4904
MANAGEMENT STAFF WILL ASSIST you with: * Obtaining Medicaid and Pooled Income Trust
* In-home Assessments, Individual and Family Counseling
* Securing reliable home care assistance
* Case and Care Management services
Dr. S. Sasson, DSW, LCSW (718) 544- 0870 or (646) 284-6242
HAIR COURSE:
Learn how to wash & style hair & wigs. Hair and wig cutting, wedding styling Private lessons or in a group Call Chaya 718-715-9009
ZEVIZZ WOODTURNING JUDAICA
Challah knifes, batei mezuzah, besamim holder, kiddish cups, havdalah candle holders, yad for sefer torah, pens, stenders, bowls and more 952-356-2228
LOOKING FOR PRIVATE PAY CLIENTS NPhomecare Service
Food prep meals, light house cleaning and laundry. Grocery shopping. Hospital visit. Be Padiatist. Physical Therapist. Educational therapist
Maintains your Independence in the comfort of your own home
Tel: 718 912 6425
Tel: 917 972 1428
Email: npersaud2022@gmail.com
WOODMERE - OLD WOODMERE
3 bedroom 2 full bathroomsSD# 14
Features LG living room with fireplace, den, large dining room, kitchen and dinette area, high ceilings, hardwood floors, primary bedroom plus sitting area plus 2 additional bedrooms, full basement, alarm, sprinkler, close to all. $759K Mark Lipner Associate Broker Berkshire Hathaway Laffey International 516-298-845 mlipner@bhhslaffey.com

DON’T GET STUCK WITH A TWO STORY HOUSE YA KNOW, IT’S ONE STORY BEFORE YOU BUY IT BUT A SECOND STORY AFTER YOU OWN IT! Call Dov Herman
For An Accurate Unbiased Home Inspection Infrared - Termite Inspection Full Report All Included NYC 718-INSPECT Long Island 516-INSPECT www.nyinspect.com
WOODMERE
Charming Colonial on beautiful tree lined street in the heart of Old Woodmere. Home features 3 bedrooms, 1.5 baths, kitchen, dining area, living room, full basement. Relatively new heating system + hot water tank. Large & beautiful backyard. Great for entertaining. Close to all. $676K Mark Lipner Associate Broker Berkshire Hathaway Laffey International 516-298-8457 mlipner@bhhslaffey.com
WOODMERE NEW TO THE MARKET
CAN’T AFFORD YOUR PROPERTY TAXES? MORTGAGE?
Must sell for any reason? Call for FREE Consultation. Call now 212-470-3856 Cash buyers available!
Move Right Into This Lovely Home, Totally Renovated Kitchen, SS Appliances, Quartz Countertops, Glass Backsplash, 10Ft Center Island, 2 Sinks, MBR W/Full Bath On The First Floor & 2 Additional Bedrooms + Full Bath. 7 New Split Systems, Hardwood Floors, New Recessed Lighting
Throughout, New Full Finished Basement W/Cedar Closet, Close To The Railroad, Shopping, Restaurants & Houses of Worship.$999K Associate
Broker Berkshire Hathaway Laffey International 516-298-8457 mlipner@bhhslaffey.com

Spacious 5 bedroom 4 bathroom split level in Saddle Ridge Estates Well maintained home home , renovated eat –in-kitchen , formal living room and dining room, den, central air conditioning, hardwood floors, high hats, master bedroom with a custom bathroom and Jacuzzi tub, close to all $995k Mark Lipner Associate Broker Berkshire Hathaway Laffey International 516-298-8457 mlipner@bhhslaffey.com
Luxurious Exquisite 6 bedrooms, 6.5 bath home situated on approximate 1.8 acre property in prestigious Hewlett Bay Park. Formal Living room and dining room, library, chefs Eat-in Kitchen, extraordinary great room leads out to veranda. large Gunite built-in pool + pool house with full bath, large slate patio, impressive sprawling property, school district #14 Hewlett-Woodmere. Close to all. P.O.R. Mark Lipner Associate Broker Berkshire Hathaway Laffey International 516-298-8457 mlipner@bhhslaffey.com
LAWRENCE
Stunning One of a Kind Mid Century Modern 6 Bedroom, 6.5 Bath, Contemporary Ranch. Resort Style Home on Over an Acre of Property in Back Lawrence. Incredible Views, Regulation Size Tennis Court - Deco Turf. IG-Gunite Pool, Low Taxes, 5318 sq. ft. of Main Floor Living Space. Plus 5000 sq. ft. Basement With Very High Ceilings. Call Mark 516-298-8457 for more details Mark Lipner Associate Broker Berkshire Hathaway Laffey International 516-298-8457 mlipner@ bhhslaffey.com
WOODMERE: NEW TO THE MARKET
Well maintained 4 bedroom home on a cul-de-sac in Old Woodmere SD#14. Features central air conditioning, gas heat, eat -in -kitchen with stainless steel appliances, very spacious den, 2 car garage, hardwood floors, high hats, magnificent yard with an in-ground saltwater pool, close to the railroad, shopping and houses of worship. Call for a private showing. Mark Lipner Associate Broker Berkshire Hathaway Laffey International 516-298-8457 mlipner@bhhslaffey.com
NORTH WOODMERE JUST LISTED
Move Right Into This Beautifully Maintained and Updated Three Bedroom, 2.5 Baths Large Split Situated on an Oversized Park-like Lot Overlooking the Pond. Home Features naturally bright lit rooms with a Ground Level Den Leading to Patio, With Another Lower Level With Partially Finished Basement. Hardwood Floors
Throughout Updated Kitchen With Granite Counters in School District 14 and Close to all Houses of Worship.
$949k Mark Lipner Associate Broker Berkshire Hathaway Laffey International 516-298-8457
mlipner@bhhslaffey.com
WOODMERE
New to the market move right in 8 bedrooms 3 full bathrooms on a lot size 57x112. prime location features eat in kitchen with 2 sinks, new stainless steel appliances, gas heat, hardwood floors, possible mother daughter with permits, close to the railroad, shopping and houses of worship. Mark Lipner Associate Broker Berkshire Hathaway Laffey International 516-298-8457 mlipner@bhhslaffey.com
In the heart of Cedarhurst (Close to Woodmere , Lirr & Cedarhurst Park)
EIK Kosher Kitchen/ Dr/Lr/Family Room/ Playroom/ 4 Bedrooms, 3 Full Baths/ Basement: 2 Bedrooms, 1 Full Bath, Kitchenette, Separate Entrance Asking $1.3m Whatsapp Text Only: 845-213-0002
No Brokers
HEWLETT BAY PARK
Six bedroom home in highly desirable Hewlett Bay Park on 3/4 of an acre with an inground gunite pool and tennis court, en-Suite bathrooms and bedrooms on both floors, 1st floor Master Suite with steam shower and Jacuzzi tub, Eat-in Kitchen, with SS appliances, 2 sinks, 2 dishwashers, double oven, formal living room, formal dining room, den with fireplace. Close to railroad, shopping, and houses of worship. SD#14. Great house for entertaining. Park-like Property. P.O.R.
Mark Lipner Associate Broker Berkshire Hathaway Laffey International 516-298-8457 mlipner@bhhslaffey.com
WOODMERE
Spectacular 5 bedroom, 5 bath renovated home in SD#14 with in-ground pool & pool house, lot size 111 x 107. Formal living room & dining room, magnificent kitchen with SS appli-ances, tremendous den with fireplace and 4 skylights, vaulted ceiling, LED lighting, master suite, new CAC, new roof. Outside totally redone with Stone and Stucco. Backyard with new pavers, park-like property, sandbox, great home for entertaining. Close to all. $1,489,000
OPEN HOUSE SUNDAY, MARCH 19
1:30-3:00PM 562 SUNSET DR. Mark
Lipner Associate Broker Berkshire Hathaway Laffey International 516298-8457 mlipner@bhhslaffey.com
WOODMERE
Charming Colonial on beautiful tree lined street in the heart of Old Woodmere. Home features 3 bedrooms, 1.5 baths, kitchen, dining area, living room, full basement. Relatively new heating system + hot water tank. Large & beautiful backyard. Great for entertaining. Close to all. Mark Lipner Associate Broker Berkshire Hathaway Laffey International 516-298-8457 mlipner@bhhslaffey.com
WOODMERE
Beautiful, brick, colonial boasting 5 bdr 3.5 Bth in pristine condition. Excellent location, near all! Move right in! RCUSA 516-512-9626
WOODMERE
Great Home on a Cul-De-Sac, SD #15, Features 4 Bedrooms, 3 New Full Bathrooms, Gas Heat, Central Air Conditioning, Renovated Gourmet EIK w/2 Sinks, Granite Countertops, New Stainless Steel Appliances Leading out to a New Deck, Elegant Formal Dining Room, New Flooring, Moldings, and New Wood Bannister Leading to the Bedrooms, Spacious Master Bedroom Suite w/Jacuzzi Tub, Sep Stall Shower, and a Large Walk-In Closet. Generously Sized Den Leading Out to a Magnificent Backyard With a New Pergola, Great Home for Entertaining, High Hats Throughout, New Front Walkway Leading to a Nice Front Porch, New Front Windows Close to RR, Shopping, Houses of Worship. P.O.R. Mark Lipner Associate Broker Berkshire Hathaway Laffey International 516-298-8457 mlipner@ bhhslaffey.com
Prestigious Center-Hall Colonial in Hewlett Bay Park, Set Back on Private Property. This Stately Home Features a Grand Entry Foyer, Formal Living Room, Formal Dining Room, Chef’s Kitchen, Large Den, Master Bedroom suite with Sitting Room + 2 Baths (His & Hers) and Loft and Additional 3 Bedrooms + Bonus Rooms. Exquisitely Manicured Park-like property. Award Winning School District #14. Too Many Features To List. Will Not Last!
P.O.R. Mark Lipner Associate Broker Berkshire Hathaway Laffey International 516-298-8457
mlipner@bhhslaffey.com
FAR ROCKAWAY REDUCED! Moller Realty Group
Corner Lot for Sale. 40x100. Approved Plans. Legal 2 Family. Asking $499k *Adjacent lot with existing legal 2 also available Both lots Asking 1.4m Motivated Seller Call or Text 516-506-3347
WOODMERE
Move right in. 4 bedrooms, 4 bathrooms split level. Features eat-in-kitchen with stainless steel appliances, granite countertops, formal living room and dining room, main floor family room with fireplace, 2 master bedrooms with full bathrooms, central a/c, gas, heat, hardwood floors, recessed lighting, cedar closet, sauna, generator and much more.
$1,115,000. Open House SUNDAY
MARCH 26 11:30-4:00PM 566
Norman Way. Mark Lipner Associate Broker Berkshire Hathaway Laffey International 516-298-8457 mlipner@bhhslaffey.com
WOODMERE
Move Right In. Renovated 8 Bedroom Colonial, Prime Location in SD#14Old Woodmere. Smart Home, Camera System, New CAC System, AG Pool, Large Eat-in Kitchen with Pantry. Finished Basement. Mark Lipner Associate Broker Berkshire Hathaway Laffey International 516-298-8457 mlipner@bhhslaffey.com
WOODMERE HOUSE RENTAL
Lovely Split Level on Quiet Residential Tree Lined Street. Huge Park-like Property. Four Bedrooms, Two Full Baths, deck & playroom. Close to all. Mark Lipner Associate Broker Berkshire Hathaway Laffey International 516-298-8457 mlipner@bhhslaffey.com
APT. FOR RENT
WOODMERE
Big fully renovated, spacious 4bedroom 2 full bath split level.2 car garage +driveway. Backyard on water SD#14. W&D. Tons of storage space. 917-324-9292
APT FOR RENT
2 bedroom spacious apartment fully renovated. Separate entrance & utilities. Water view, walking to shul & shopping. On the lake. 347-517-3552
CEDARHURST MOVE RIGHT IN. Totally Updated One Bedroom Townhouse Apartment on the First Floor. Featuring 1.5 Bathrooms, Central Air Conditioning, Washer/ Dryer in the Unit, Kitchen With SS Appliances, Hardwood Floors, and Recessed Lighting. Freshly Painted. Super on Premises. Underground Parking is $95/month. This spacious rental is managed by a responsible landlord. Great Courtyard. Close to the Railroad, Shopping, Restaurants, Post Office, Cedarhurst Park + Houses of Worship. NO BROKERS FEE Mark Lipner Associate Broker Berkshire Hathaway Laffey International 516-298-8457 mlipner@bhhslaffey.com
WOODSBURGH
Magnificent 2K Sq. Ft. Co-Op. 3Br/2Bth, Eik, Lr, Dr, W/D In Unit, Gar, 2 Stor Units, Elev, Near All $775K 516-846-1032 No Brokers
LAWRENCE
Spacious 2BR, 2 Full Bath Apt with an enclosed terrace in the heart of Lawrence. Well maintained & manicured building. New hardwood floors, updated Eat-in Kitchen with gas stove. warming draw, dishwasher & microwave. New windows on the enclosed terrace & one of the bedrooms. 3 New A/C Units & New Refrigerator. Close to shopping, transportation, library, schools, and houses of worship. $339K OPEN
HOUSE SUNDAY FEBRUARY 19 2:003:30PM 284CENTRAL AVE B-5 Mark Lipner Associate Broker Berkshire Hathaway Laffey International 516298-8457 mlipner@bhhslaffey.com
CEDARHURST
Move Right In. Totally updated 2BR, 2 Bath, Apt. on the 1st Floor. Private Entrance, CAC, W/D in Unit, Kitchen with SS Appliances, Hardwood Floors, Recessed Lighting, Freshly Painted, Great Courtyard, Parking $95/Mo. Close to Railroad, Shopping, Restaurants, Cedarhurst Park + Houses of Worship NO
BROKERS FEE Mark Lipner Associate Broker Berkshire Hathaway Laffey International 516-298-8457 mlipner@bhhslaffey.com
One Bedroom Renovated Apartment In Prime Lawrence. Efficiency Kitchen, Renovated Bathroom. Sunken LR, Dining Room, Close to All, Transportation, Shopping, Worship. $275k Mark Lipner Associate Broker Berkshire Hathaway Laffey International 516-298-8457 mlipner@ bhhslaffey.com
LAWRENCE
Spacious 2BR, 2 Full Bath Apt with an enclosed terrace in the heart of Lawrence. Well maintained & manicured building. New hardwood floors, updated Eat-in Kitchen with gas stove. warming draw, dishwasher & microwave. New windows on the enclosed terrace & one of the bedrooms. 3 New A/C Units & New Refrigerator. Close to shopping, transportation, library, schools, and houses of worship. $339K Mark Lipner
Associate Broker Berkshire Hathaway Laffey International 516-298-8457 mlipner@bhhslaffey.com
HEWLETT
3 bedroom 2 bath co-op with central air conditioning, terrace, washer dryer, hardwood floors, recessed lighting, magnificent kitchens, ss appliances, l/r, d/r, close to the railroad, shopping, and houses of worship. $319k OPEN HOUSE



SUNDAY, MARCH 19 11:00-1:00PM
1201 EAST BROADWAY H-23Mark
Lipner Associate Broker Berkshire Hathaway Laffey International 516298-8457 mlipner@bhhslaffey.com





This amazing two-bedroom two full bathroom condo Features a luxurious lifestyle in the beautiful city of Lawrence. What more could you ask for? The building has a 24-hour doorman and elevator access, with a social room, library, washer/dryer inside the unit, and terrace. Plus, the added benefit of having a live-in super to ensure maximum safety and security! And don’t forget about your new kitchen complete with a gas stove, refrigerator, microwave, and even two dishwashers! The living room and dining room are spacious and have recessed lighting installed throughout. Both bedrooms feature lots of closet space for storage. To top it off, there’s even garage parking available to make your life just that much easier! Don’t miss out on this incredible opportunity. Please call for a private showing Mark Lipner
Associate Broker Berkshire Hathaway Laffey International 516-2988457 mlipner@bhhslaffey.com

HEWLETT
Totally renovated 1 and 2 Bedroom, Apartments with washer/dryer, kitchen with quartz countertops, stainless steel appliances. Recessed lighting, hardwood floors, storage in basement. Close to RR, shopping, and houses of worship. Mark Lipner
Associate Broker Berkshire Hathaway Laffey International 516-298-8457 mlipner@bhhslaffey.com
HEWLETT
Hewlett House 1 Bedroom Co-op. Unit Includes 1 Parking Spot + Storage Unit, W/D Outside of Unit. Close to Shopping, Schools, Houses of Worship, Restaurants + Parks. Prime Location in the Heart of Hewlett. $109k Mark Lipner Associate Broker Berkshire Hathaway Laffey International 516-298-8457 mlipner@bhhslaffey.com
CEDARHURST
1, 2 and 3 bedroom apartments, totally renovated private entrance , central air conditioning, hardwood floors, washer/dryer, garage parking, dishwasher, recessed lighting, private playground, close to railroad, park, shopping and houses of worship. Call for more details
Mark Lipner Associate Broker Berkshire Hathaway Laffey International 516-298-8457 mlipner@bhhslaffey.com
WOODMERE
1 bedroom apartment, elevator building, eat-in kitchen, full bath, hardwood floors, plenty of closet space. Ceiling fan in bedroom & kitchen, laundry room in the basement. Close to the railroad, shopping, and houses of worship $168k Mark Lipner Associate Broker Berkshire Hathaway Laffey International 516-298-8457 mlipner@bhhslaffey.com
WOODMERE
Totally renovated bright and sunny 1 bedroom corner unit apartment with a washer/dryer. Features quartz countertops, ss appliances, recessed lighting, bathroom with chrome fixtures, close to the railroads, shopping and houses of worship. Call for details Mark Lipner Associate Broker Berkshire Hathaway Laffey International 516-298-8457 mlipner@bhhslaffey.com
WOODMERE
Move right in!! 2 Bedroom Apartment, Elevator Bldg in SD #14, Pre War Bldg, Pet Friendly, Laundry Room in Basement, Wood Floors, New Windows, Corner Apartment, Beautiful Renovated Kitchen w/SS Appliances, 3 A/C Units, Close to RR, Shopping & Houses of Worship. A must-see! $199k
Excellent growth potential, Frum environment, Excellent salary & benefits. Email resume to: resumetfs1@gmail.com
REBBEIM TEACHERS & ASSISTANTS
CAHAL is hiring Special Ed Rebbeim, Teachers and Assistant Teachers for 2023-24 school year. AM or PM, FT or PT. E-mail resume to shira@cahal.org or call 516-295-3666 for information.
SEEKING ELA TEACHER
Immediate opening. ELA teaching position for Gr. 5. Mon.-Thurs., afternoon hours. Far Rockaway/5T area. Competitive salary, warm, supportive environment. All teaching materials provided. Teachersearch11@gmail.com.
A YESHIVA IN QUEENS
is looking for an experienced part/ full time secretary, 2-year-old morah, kindergarten morah, kindergarten morah assistant and Pre-1A English teacher for the 2022-2023 school year. Nice and timely pay. Please email resume to mshelt613@gmail.com or call/text 718-971-9799.
LOOKING FOR A DRIVER
Business looking for someone that has a large van or sprinter that can work a full day on Wednesdays on a weekly basis throughout the year in Brooklyn. Please do not call if you do not have a large van or a sprinter 347.992.7411
MDS REGIONAL NURSE:
5 Towns area Nursing Home management office seeking a Regional/Corporate level MDS Nurse to work in our office. Must be an RN. Regional experience preferred. 2-3 years MDS experience with good computer skills required. Position is Full Time but Part Time can be considered. Great Shomer Shabbos environment with some remote options as well. Email: officejob2019@gmail.com

A multi-tasker needed for general office work. The ideal candidate is someone who is detail-oriented, responsible, and can take ownership. Looking for someone who is eager to learn, and expand his/her skill set while possessing the ability to work independently and as part of a team. Experience with Excel required. Five Towns location. In-office position only, not remote. Please send resume to 5tpart.timecareer@gmail.com
Large Not for Profit Organization is looking for a Controller who can Manage the monthly financial close, including reconciliations of revenue and expense accounts, investment activities, fixed assets, accruals, ongoing variance, payroll, and benefits analysis. Manage and comply with all local, state, and federal government accounting and reporting requirements. Salary range $120k-$160k
Respond to Jobs@hcsny.org
YESHIVA ATERES EITZ CHAIM
Boys HS Cedarhurst, seeking GS teacher for afternoons, M-TH. Warm and supportive environment. Competitive salary based on experience. Please email resume to aecrabbioppen@gmail.com.
IMMEDIATE OPENING
ELA teaching position for Gr. 5. Mon.-Thurs., afternoon hours. Far Rockaway/5T area. Competitive salary, warm supportive environment. Teachersearch11@gmail.com
5 TOWNS BOYS YESHIVA
Seeking Elem Gen Ed Teachers
Excellent working environment and pay. Only lic/exp need apply. Email resume to yeshivalooking@gmail.com

COM HAB/ RESPITE SERVICES
Nechama is a High Functioning
24 Year Old Female that lives in Far Rockaway near Dinsmore Ave, who has experience working with children, is looking for a frum young mother, who lives in Far Rockaway area to provide Com Hab and/or Respite Services for her, in order for this individual to learn how to manage a household i.e., learning cooking skills, organizational skills etc… This individual is available from 4:30 pm to 6:30 pm Monday through Thursday, including Sundays. Jobs@hcsny.org
 By Avi Heiligman
By Avi Heiligman
At the beginning of World War II, strategists for the Axis powers knew that if the United States were to enter the war, they would be facing a country with extraordinary production capabilities. Japanese commanders in particular were worried about American air assets that were being produced in large numbers and at a very high speed of production. American faculties produced 99 aircraft carriers during the war and increased their aircraft production from 3,000 planes to over 300,000 by war’s end. Two-thousand-six-hundred of these planes weren’t the typical fighter, bomber transport or reconnaissance plane. The Consolidated PBY Catalina flying boat and amphibious aircraft had many unique capabilities and rendered valuable service both during and after the war.
In addition to the American PBY planes that were built, two other countries produced the flying boat. Canada built 620 of them, while Soviet factories built 27. First introduced in 1936, the Catalina had a crew of eight to ten men and measured 100 feet from wingtip to wingtip. Its incredible range of 2,500 miles was only matched the B-17 four engine bomber at the start of the war. However, it was slow and was vulnerable to air attacks. Its range of mission included reconnaissance and intelligence, patrol, search and rescue, bombing, torpedo bombing anti-submarine warfare, mine laying and nighttime operations. PBYs had up to five machine guns and could carry 4,000 pounds of bombs. This multi-purpose aircraft was often painted black to avoid detection by Japanese planes and was
outfitted with sophisticated radar and other ship detecting systems.
The crews of these planes often went into the enemy’s lair and endured withering gunfire to complete their mission. This was the case of Lt. Nathan Green Gordon and his crew that flew in a Catalina named Arkansas Traveler. The Arkansas native was part of Patrol Squadron 34, nicknamed the “Black Cats,” and was based in New Guinea.
On February 15, 1944, the squadron was on patrol duty for a Fifth Air Force bombing mission over Kavieng in New Ireland. They had gotten the call that an A-20 Havoc medium bomber had gone down and needed rescue. Escorted by P-47 fighters, the Catalina flew a hundred miles and landed in a large swell with 16foot waves but found no sign of the crew. They were directed by an overhead B-25 bomber to a second location of a downed B-25. The swells were also high on this landing, and they had to cut off one of the engines to make a safe landing. This time, they were able to pick up the six stranded crewmembers.

As their escort fighters had to leave due to low fuel, Gordon got more calls to pick up more stranded airmen. He made another two landings, and nine more men came aboard. The fourth landing was just 600 yards from the shore, and Gordon bravely flew the seaplane through thick anti-aircraft fire. Ultimately, the Catalina had rescued fifteen airmen with several wounded men among the survivors. The overloaded seaplane now had 24 men onboard including the Catalina crew. After the rescued men had been safely dropped
off at an American base, Gordon refueled and returned to his base. The entire crew was awarded the Silver Star and Gordon received the Medal of Honor for his role in the daring rescue.
Earlier in the Pacific Theater of Operations, some Catalina seaplanes had been used during attacks against Japanese ships and transports. Lieutenant (j.g.) Allen Rothenberg from Washington, D.C., was a Jewish PBY Catalina pilot with the VP-51 Squadron. After the attack on Pearl Harbor, they were stationed to conduct patrols and in early June 1942 flew towards Midway Island with 500-pound bombs. No targets were found on a patrol during the battle, but on their way back to Midway, they observed that there was black smoke coming from the island. They didn’t know if the island had been captured and barely made it an alternate refueling site before the gas tanks were empty. An accident with another PBY forced them back to Pearl Harbor.
Rothenberg and his crew were sent back to the South Pacific and operated in the Guadalcanal area. On October 16, the crew located enemy ships by radar and aimed for the largest ship. They hit an enemy cruiser with a torpedo on their second run at the target and escaped enemy fire. Records don’t indicate which enemy ship was hit or that a Japanese cruiser was sunk that day, but inaccuracies were very common back then, as the Japanese did not want the public to know about their losses.
Three days later, together with two other Catalina seaplanes, Rothenberg was sent by Vice Admiral “Bull” Halsey
to attack a Japanese cruiser that had been shelling marines fighting on Guadalcanal. Two Japanese cruisers were sighted, and Rothenberg ordered that his 500-pound bombs be dropped. The first two missed their targets, but the last two caused explosions on one of the warships. The ship was abandoned by the Japanese, and the next day American warships sank the ship that Rothenberg had put out of action. Rothenberg was awarded the Navy Cross for “his superb airmanship and courageous initiative.”
In another action, Rothenberg spotted the survivors of the American destroyer USS Meredith. The ship had been sunk by Japanese planes, and 73 survivors had been afloat for three days. Rothenberg dropped life rafts and called for other American ships 30 miles away to pick up the stranded sailors. Later in the war, Rothenberg became a carrier fighter pilot and saw action in the Korean War as the commander of a F9F Panther squadron.
Catalina seaplanes performed important tasks that no other aircraft was capable of undertaking. Even when their replacements were being delivered to the navy, the Catalina was the preferred flying boat of most aircrews and therefore wasn’t replaced until long after the war had ended. Catalinas and their crews are history to be remembered.
In the 1946 movie, It’s A Wonderful Life , Jimmy Stewart plays banker George Bailey, who uses his honeymoon savings to keep his family building and loan afloat after a bank run. Years later, Bailey’s despair over a missing $8,000 drives him to cash in his life insurance, although the story doesn’t end there.
Small-town banks like the Bailey Brothers Building and Loan have become as rare as George’s 1919 Dodge Phaeton. And today, every time a bell rings, someone’s grandma gets conned out of her life’s savings. But bank runs are still a thing. Recently, Silicon Valley Bank became the largest bank to fail since Washington Mutual failed during the 2008 Great Recession. SVB had invested billions of customers’ deposits in perfectly safe bonds, only to watch rising interest rates push the value of that portfolio down enough to spark a run. Last Friday, regulators stepped in to shut it down, and regional bank stock prices tanked across the industry.
Last Sunday, the Federal Reserve, Treasury, and FDIC jointly announced a deal to guarantee customers would have access to their money. That’s good news for anyone counting on that cash – including an army of tax collectors across the country.
We all know the FDIC insures bank deposits up to $250,000. But SVB’s business customers kept millions on hand to finance their standard-issue Silicon Valley dreams, running their companies and paying their employees. The collapse meant regulators locked up %85 of the bank’s 175$ billion in customer
maining cash with SVB. When SVB failed, hundreds of companies said they would have trouble making payroll without access to their cash. Obviously, that would have been no bueno for the employees who didn’t get their paychecks. But those companies also could have wound up stiffing Uncle
None of this comes at a convenient time for Uncle Sam. On January 19, the Treasury hit the debt ceiling, an artificial limit on how much the government can borrow. Officials are currently using “extraordinary measures” to keep the government fun factory pumping out cash like Play-Doh. (“Extraordinary measures” is code for spending shenanigans that would make George Bailey’s face turn the color of baby food after the baby’s done using it.) Rumor has it that we can coast on fumes until crashing sometime between July and September – and missing billions in taxes from SVB customers and their employees could certainly have hastened that day.
accounts. Take Roku, for example, who manufactures the digital media players you use to stream media on your TV.
Roku had 487$ million at SVB, and their stock fell 4% on news of the shutdown.
Crypto lender BlockFi – which halted withdrawals and declared bankruptcy after Sam Bankman-Fried’s FTX exchange went bust – held $227 million of their re -
Sam and state and local governments who wouldn’t get the taxes withheld on those paychecks.
Customers who pay corporate tax may have been planning to use some of their deposits to make those payments, too. March 15 is the deadline for filing corporate taxes, and April 15 is the deadline for first quarter estimated tax payments.
Silicon Valley Bank went from “looking for capital” to “busted” to “backed up” in less than a week. Now, it looks like we’re in for a happy ending. The story illustrates how nearly any financial news has a tax angle. So remember, we’re here to help you write happier endings, too!

Officials are currently using “extraordinary measures” to keep the government fun factory pumping out cash like Play-Doh.
I’m here, under the bed, looking for the candy that was in the wrapper I just found.
I’m not sure if my persistence is coming from my devotion to Peach cleaning or the fact that it’s a Snickers wrapper and I love Snickers. I’m hoping that there is one still on the loose.
This Pesach thing comes year-in and year-out and still we haven’t perfected the system.
Whether we’re traveling, staying home, cooking, cleaning, shopping or packing, we always seem to be confronting something new to deal with.
Years ago, it used to be about cleaning your own house. Now, it’s cleaning someone else’s house – in Orlando.

Years ago, it used to be going down to a hotel in Miami. Now, it’s filling all the space left open –in Mexico.
Years ago, it was making sure your program had a day camp. Now, it’s bribing your kids to stay in day camp.
Years ago, it was scrambling for ingredients to use for Passover. Now, it’s trying to find some item that’s not kosher for Passover.
This year is one of those uniquely challenging Pesachs. You know, the ones where they sneak in an extra day on to the yom tov end and abscond with one of the days from the chol hamoed part. That means we need to do more, cleaning, cooking and eating. And there are less excursions, swimming, or exercising.
matzah before we even get to the meal. We lean, we cry, we sing, we talk, and throughout we drink! And then we are supposed to be able to tell the whole story of what happened to us 2,000 years ago. We’re lucky, after doing all that, if we still remember it’s Pesach!
The truth is, we do it year-in and year-out. So we are be pretty famil -
his bed to find frogs in his bed and frogs on his head!” And furthermore, that Pharoah said, “No, no, no” and wouldn’t let us go!
And surely, we all know there were Ten Makkos and that the sea split. And that we got the Ten Commandments and a Homeland, too.
Therefore, inebriated or sober, somehow, we’ve learned our history. And we know we’ve got a lot to be thankful for!
So, whatever the inconveniences might be, we should remember we are celebrating the gift of being let go. So let go of all your stresses – and enjoy the Pesach holiday in all its grandeur!
Talk about a holiday where you should specifically not be puffing things up! Everything has to stay flat but our stomachs!
And can we talk about the Seders?! After all, “The more you talk about it, the more you are praised.” We eat an entire meal and a boatload of
iar with it. We also get a cheat sheet called the Haggadah to remind us. And on top of that, we have all our schools preparing our kids for this holiday. It would be hard to miss a detail.
One thing we all know for sure is that: “One morning Pharaoh awoke in
